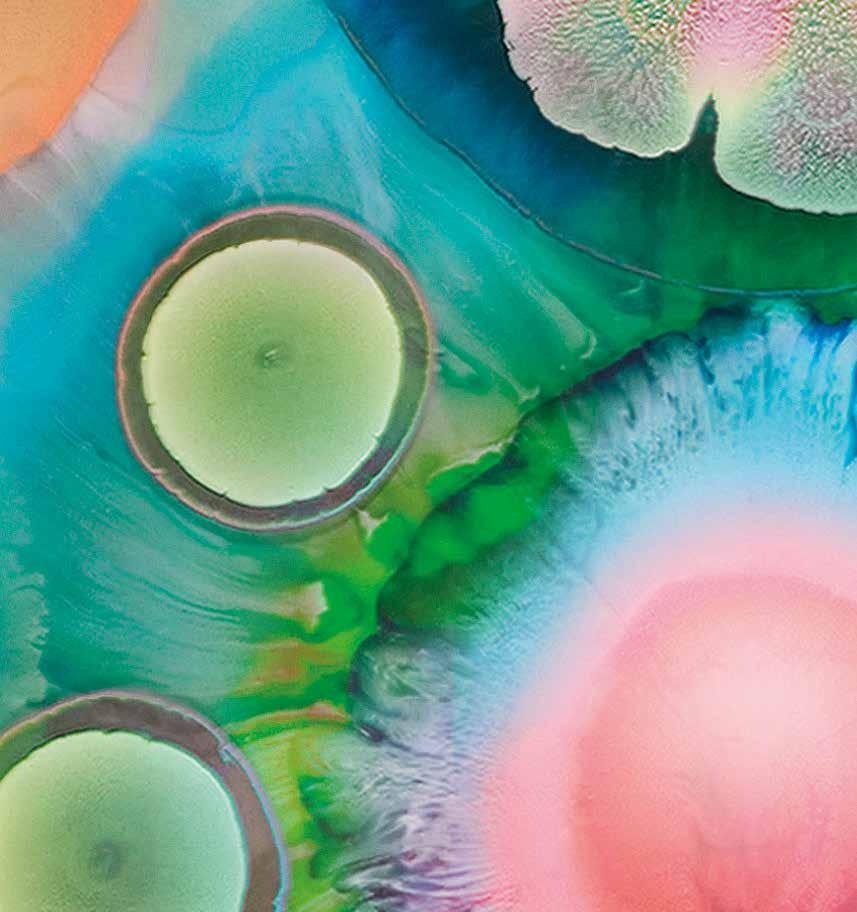

Prescribing Information for Enstilar® (calcipotriol/betamethasone)
50 micrograms/g + 0.5 mg/g cutaneous foam
Please refer to the full Summary of Product Characteristics (SmPC) (www.medicines.org.uk/emc or www.medicines.ie) before prescribing.
Indication: Topical treatment of psoriasis vulgaris in adults. Active ingredients: 50 µg/g calcipotriol (as monohydrate) and 0.5 mg/g betamethasone (as dipropionate). Dosage and administration: Flare treatment: Apply by spraying onto affected area once daily. Recommended treatment period is 4 weeks. If it is necessary to continue or restart treatment after this period, treatment should be continued after medical review and under regular supervision. Longterm maintenance treatment: Patients who have responded at 4 weeks’ treatment using Enstilar once daily are suitable for long-term maintenance treatment. Enstilar should be applied twice weekly on two non-consecutive days to areas previously affected by psoriasis vulgaris. Between applications there should be 2-3 days without Enstilar treatment. If signs of a relapse occur, flare treatment, as described above, should be re-initiated. Maximum dose: The daily maximum dose of Enstilar should not exceed 15 g, i.e. one 60 g can should last for at least 4 days of treatment. 15 g corresponds to the amount administered from the can if the actuator is fully depressed for approximately one minute. A two-second application delivers approximately 0.5 g. As a guide, 0.5 g of foam should cover an area of skin roughly corresponding to the surface area of an adult hand. If using other calcipotriol-containing medical products in addition to Enstilar, the total dose of all calcipotriol-containing products should not exceed 15 g per day. Total body surface area treated should not exceed 30%. Safety and efficacy in patients with severe renal insufficiency or severe hepatic disorders have not been evaluated. Safety and efficacy in children below 18 years have not been established. Shake the can for a few seconds before use. Apply by spraying, holding the can at least 3 cm from the skin, in any orientation except horizontally. Spray directly onto each affected skin area and rub in gently. If used on the scalp, spray into the palm of the hand then apply to affected scalp areas with the fingertips. See hair washing instructions in the package leaflet. Wash hands after use (unless Enstilar is used to treat the hands) to avoid accidentally spreading to other parts of the body as well as unintended drug absorption on the hands. Avoid application under occlusive dressings since systemic absorption of corticosteroids increases. It is recommended not to take a shower or bath immediately after application. Let the foam remain on the scalp and/or skin during the night or during the day. Contraindications: Hypersensitivity to the active substances or any of the excipients. Erythrodermic and pustular psoriasis. Patients with known disorders of calcium metabolism. Viral (e.g. herpes or varicella) skin lesions, fungal or bacterial skin infections, parasitic infections, skin manifestations in relation to tuberculosis, perioral dermatitis, atrophic skin, striae atrophicae, fragility of skin veins, ichthyosis, acne vulgaris,

acne rosacea, rosacea, ulcers and wounds. Precautions and warnings: Adverse reactions found in connection with systemic corticosteroid treatment, e.g. adrenocortical suppression or impaired glycaemic control of diabetes mellitus, may occur also during topical corticosteroid treatment due to systemic absorption. Application under occlusive dressings should be avoided since it increases the systemic absorption of corticosteroids. Application on large areas of damaged skin, or on mucous membranes or in skin folds should be avoided since it increases the systemic absorption of corticosteroids. Visual disturbance may be reported with systemic and topical corticosteroid use. If a patient presents with symptoms such as blurred vision or other visual disturbances, the patient should be considered for a referral to an ophthalmologist for evaluation of possible causes which may include cataract, glaucoma or rare diseases such as central serous chorioretinopathy (CSCR) which have been reported after use of systemic and topical corticosteroids. Due to the content of calcipotriol, hypercalcaemia may occur. Serum calcium is normalised when treatment is discontinued. The risk of hypercalcaemia is minimal when the maximum daily dose of Enstilar (15 g) is not exceeded. Enstilar contains a potent group III-steroid and concurrent treatment with other steroids on the same treatment area must be avoided. The skin on the face and genitals is very sensitive to corticosteroids. Enstilar should not be used in these areas. Instruct the patient in the correct use of the product to avoid application and accidental transfer to the face, mouth and eyes. Wash hands after each application to avoid accidental transfer to these areas as well as unintended drug absorption on the hands. If lesions become secondarily infected, they should be treated with antimicrobiological therapy. However, if infection worsens, treatment with corticosteroids should be discontinued. When treating psoriasis with topical corticosteroids, there may be a risk of rebound effects when discontinuing treatment. Medical supervision should therefore continue in the post-treatment period. Long-term use of corticosteroids may increase the risk of local and systemic adverse reactions. Treatment should be discontinued in case of adverse reactions related to longterm use of corticosteroid. There is no experience with the use of Enstilar in guttate psoriasis. Enstilar contains butylhydroxytoluene (E321), which may cause local skin reactions (e.g. contact dermatitis), or irritation to the eyes and mucous membranes. Pregnancy and lactation: There are no adequate data from the use of Enstilar in pregnant women. Enstilar should only be used during pregnancy when the potential benefit justifies the potential risk. Caution should be exercised when prescribing Enstilar to women who breast-feed. The patient should be instructed not to use Enstilar on the breast when breastfeeding. Side effects: There are no common adverse reactions based on the clinical studies. The most frequently reported adverse reactions are application site reactions. Uncommon (≥1/1,000 to <1/100): Folliculitis, hypersensitivity, hypercalcaemia, skin hypopigmentation, rebound effect,
application site pruritus, application site irritation, application site pain (including application site burning). Not known (cannot be estimated from available data): Blurred vision, hair colour changes. Calcipotriol: Adverse reactions include application site reactions, pruritus, skin irritation, burning and stinging sensation, dry skin, erythema, rash, dermatitis, psoriasis aggravated, photosensitivity and hypersensitivity reactions, including very rare cases of angioedema and facial oedema. Systemic effects after topical use may appear very rarely causing hypercalcaemia or hypercalciuria. Betamethasone: Local reactions can occur after topical use, especially during prolonged application, including skin atrophy, telangiectasia, striae, folliculitis, hypertrichosis, perioral dermatitis, allergic contact dermatitis, depigmentation and colloid milia. When treating psoriasis with topical corticosteroids, there may be a risk of generalised pustular psoriasis. Systemic reactions due to topical use of corticosteroids are rare in adults; however, they can be severe. Adrenocortical suppression, cataract, infections, impaired glycaemic control of diabetes mellitus, and increase of intra-ocular pressure can occur, especially after longterm treatment. Systemic reactions occur more frequently when applied under occlusion (plastic, skin folds), when applied onto large skin areas, and during long-term treatment. Precautions for storage: Do not store above 30°C. Extremely flammable aerosol. Pressurised container. May burst if heated. Protect from sunlight. Do not expose to temperatures exceeding 50°C. Do not pierce or burn, even after use. Do not spray on an open flame or other ignition source. Keep away from sparks/open flames. No smoking. Legal category: POM. Marketing authorisation number and holder: PL 05293/0008 (UK), PA 1025/5/1 (Ireland). LEO Pharma A/S, Ballerup, Denmark. Basic NHS price (UK): £39.68/60 g, £79.36/2 x 60 g. Last revised: March 2021.
Reporting of Suspected Adverse Reactions
Adverse events should be reported.
For the United Kingdom, reporting forms and information can be found at: www.mhra.gov.uk/yellowcard or search for MHRA Yellow Card in the Google Play or Apple App Store.
Adverse events should also be reported to Drug Safety at LEO Pharma by calling +44 (0)1844 347333 or e-mail: medical-info.uk@leo-pharma.com
For the Republic of Ireland, reporting forms and information can be obtained from: HPRA Pharmacovigilance, Earlsfort Terrace, Dublin 2, Tel: +353 1 6764971, Fax: +353 1 6762517, Website: www.hpra.ie, e-mail: medsafety@hpra.ie
Adverse events should also be reported to Drug Safety at LEO Pharma by calling +353 1 4908924 or e-mail: medical-info.ie@leo-pharma.com
Page 5: Boots Ireland launch Liver Scanning Service
Page 8: EU steps up to prevent medicine shortages
Page 10: We talk to Hillary Collins, PHX Ireland

Page 16: Innovation and growth in Ireland’s OTC Market
Page 22: IQVIA Top 100 OTC Products
Page 36: An overview of the Pain Category
Page 58: Homecare: Pharmacy Career with a difference
Page 62: New research in Vitamin D
PUBLISHER:
IPN Communications
Ireland Ltd.
Clifton House, Fitzwilliam Street
Lower, Dublin 2 00353 (01) 6690562
MANAGING DIRECTOR
Natalie Maginnis n-maginnis@btconnect.com
EDITOR
Kelly Jo Eastwood: 00353 (87)737 6308
kelly-jo@ipn.ie
ADVERTISING EXECUTIVE
Amy Evans: amy@ipn.ie
EDITORIAL/ EVENTS & MARKETING EXECUTIVE
Aoife Hunter: aoife@ipn.ie

CONTRIBUTORS
Gwynne Morley | Jackie Kelly
Denis O’Driscoll | Martin Hynes
Damien O’Brien | Deirdre Butler
Michelle O’Hagan
Theresa Lowry-Lehnan
Fathimah Kara
Mark McPhillips
Caroline Crowley
Dr Sally Griffiths
Dr David Breen
DESIGN DIRECTOR
Ian Stoddart Design
Irish Pharmacy News is circulated to all independent, multiple Pharmacists and academics in Ireland.
All rights reserved by Irish Pharmacy News. All material published in Irish Pharmacy News is copyright and no part of this magazine may be reproduced, stored in a retrieval system or transmitted in any form without written permission. IPN Communications Ltd. has taken every care in compiling the magazine to ensure that it is correct at the time of going to press, however the publishers assume no responsibility for any effects from omissions or errors.
Summer is finally here and with the sunshine came some good news for community pharmacists as Minister for Health Stephen Donnelly announced he is to set up an Expert Taskforce to support the expansion of the role of pharmacists in Ireland.


The Taskforce will examine how pharmacists can be enabled to operate at the top of their licence for the benefit of patients and the wider health service. It will initially consider options to enable pharmacists to extend prescriptions for a range of medicines and medical conditions where appropriate.
PSI Registrar and Chief Officer Joanne Kissane added, “We believe the move to establish a taskforce is an important step in examining the ways in which the scope of pharmacists can be expanded upon, utilising their extensive medicines expertise and education and training for the benefit of patients and the public.”
Turn to page 4 for the full story.
Furthermore, on page 6 we detail the further announcement of the potential for building capacity in higher education programmes for pharmacy.
The Higher Education Authority (HEA) report to Government recommends that with additional investment, there is scope to create over 190 places in pharmacy education annually and up to 1,400 places across healthcare and veterinary medicine.
Tom Murray IPU Honorary Treasurer says, “While there is now an action plan to train more pharmacists, this will take time. There is a pressing need to deal with the shortages within the profession today. Many pharmacist vacancies are going unfilled, and this can only have a negative impact on patient experience.”
The IPN August issue carries our annual IQVIA Top 100 statistics. Irish Pharmacy News has been working with data analysts IQVIA for over eight years in compiling and bringing this information to our readers, pharmacy professionals of Ireland.
We spoke to General Manager of IQVIA, Gwynne Morley, to gain further insights into how these statistics are compiled and on the value of this market to pharmacy.

Turn to page 16 for the full report and the in-depth category reports which follow, including the allergies market, eye care in Ireland, cough, cold & flu, men’s health, digestion and
I hope you enjoy the issue.
CPD: MANAGEMENT OF COUGH
P41
TEAM TRAINING: ACNE P64
FEATURE: LUNG CANCER PATHWAYS P70
FEATURE: E-CIGARETTES & VAPING P73
CLINICAL PR: P62
Minister for Health Stephen Donnelly is setting up an Expert Taskforce to support the expansion of the role of pharmacists in Ireland.
Joanne Kissane, PSI Registrar and Chief OfficerTwo new mental health support resources to support children and young people in Waterford city and county were launched at an event held in Mt. Congreve House and Gardens.

in examining the ways in which the scope of pharmacists can be expanded upon, utilising their extensive medicines expertise and education and training for the benefit of patients and the public. Such a move aligns with one of the strategic objectives within our current corporate strategy to facilitate evidence-based practice by pharmacists and advanced practice, where this is required by patient need and public policy.
“The Way Forward” is a Bibliotherapy initiative to promote wellbeing among children and young people. It is a collaboration between HSE/Community Healthcare’s Primary Care/Child Psychology Services in Waterford and the Waterford City and County Council Library Services.
The Taskforce will examine how pharmacists can be enabled to operate at the top of their licence for the benefit of patients and the wider health service.
It will initially consider options to enable pharmacists to extend prescriptions for a range of medicines and medical conditions where appropriate.
Welcoming the announcement
Derek Reilly, interim Secretary General of the IPU said, “The Irish public already deeply value the role of their pharmacist, and the pharmacy network is the most accessed and accessible aspect of our health system. Expanding the profession’s role will allow our 1,900 community pharmacies to function at the very heart of the healthcare system.”
The Irish Pharmacy Union National Pharmacy Conference takes place this year on Saturday, 21st October in Johnstown House Estate in Enfield, Co. Meath.
This event, plays a vital role in supporting pharmacists with CPD, covering a range of clinical and business topics.
Mr Reilly has however warned that fees paid to pharmacists, which are lower now than they were in 2009, will need to be addressed as a priority. “The Pharmacy profession had to endure substantial fee cuts during the recession and remains the only healthcare profession who has not had fees restored. For each medicine dispensed on behalf of the state the fees received today are 24% lower than 14 years ago, while costs continue to rise. While this review of services is welcome, it cannot be done in isolation without reviewing the funding of pharmacies.”
PSI Registrar and Chief Officer
Joanne Kissane added, “We believe the move to establish a taskforce is an important step
“We recognise that the expansion of pharmacists’ scope of practice has the potential to alleviate pressures in other areas of the health system and provide access to care at the lowest level of complexity, in line with the principles of Sláintecare.
“In participating in the taskforce, and considering any recommendations that arise from its work, our focus will be on ensuring appropriate regulatory frameworks, standards, and training are in place to ensure that patients and the public have access to trusted pharmacy services.”
The Taskforce has been asked to provide its first recommendations to the Minister as early as October 2023.
Dr Pat O Mahony has been appointed as Taskforce Chair.

Bibliotherapy is the use of literature to help educate and address a range of mild to moderate mental health, wellbeing and behavioural difficulties. All of the books and resources listed in the guide can be found in your local library in Waterford. This initiative was funded and supported by the Waterford Children and Young People’s Services Committee (CYPSC).
The “Guidelines for referrals to mental health and support services in Waterford (for children and young people)” is a resource funded by the HSE/South East Community Healthcare’s Regional Suicide Prevention Resource Office and developed in partnership with the Waterford CYPSC Youth Mental Health Subgroup.
The poster is designed for professionals across all agencies to ensure that children and young people are referred to the support service that is most appropriate to their individual needs. The poster highlights the many services and supports available to children, young people and their families across Waterford City and County.
This is the first face to face conference since 2019 and will also mark the start of the celebrations of the 50th Anniversary of the IPU. The event will provide support to the pharmacy profession through an extensive programme of events, education sessions and ‘The Great Debate’.
The Breakfast event at in Mt. Congreve House to launch the Bibliotherapy initiative and the Guidelines poster was addressed by Tracy Nugent (HSE Service Manager/Resource Officer for Suicide Prevention) and Dr Tom Pender (Senior Clinical Psychologist, HSE/Community Healthcare’s Primary Care/ Child Psychology Services in Waterford). The event was attended by a broad range of organisations including the HSE, Tusla, Waterford City and County Council and many community and voluntary stakeholders.
The HSE will introduce publicly funded fertility treatment services from September 2023. This includes treatments such as IVF, IUI and ICSI for people who meet the access criteria, as announced by the Minister for Health.
Dr Clíona Murphy, Clinical Director, HSE National Women and Infants Health Programme (NWIHP), said, “This is the first and very exciting phase in the rollout of Assisted Human Reproductive Services in Ireland and an important development to support people who need fertility treatments.
“We are delighted to see investment in this area to ease the financial burden for public patients and it will significantly increase access to services for many. We have designed caring and efficient pathways for patients, ensuring a safe and quality service, so that fertility issues are addressed through the public health system at the lowest level of clinical intervention necessary.”
People who are experiencing fertility issues should talk to their GP, who can do initial tests. Patients can then be referred by their GP to their local Regional Fertility Hub, where they can expect to avail of a wide range of investigations and interventions including: relevant blood tests, semen analysis, fertility-related surgeries and medical management of fertility challenges including ovulation induction with follicle tracking.
From September, if further advanced treatment is recommended by a Reproductive Medical Consultant and the patients meet the Access Criteria, the hubs will refer patients to a HSE-approved private provider of their choosing. There is no cost to patients for the recommended treatment through the private providers.
The HSE will be actively monitoring and reviewing the demand on this service, and reviewing patient needs both in collaboration with our six fertility hubs and with the network of HSE-approved private providers.
Boots Ireland has launched a new Liver Scanning Service to help check liver health by measuring potential scar tissue and fatty change in the liver.
Caoimhe McAuley, Director of Pharmacy and Superintendent Pharmacist of Boots Ireland with Professor Suzanne Norris, Consultant Hepatologist & Gastroenterologist, Professor of Gastroenterology/Hepatology
Boots recognises its unique position as a local primary healthcare provider, and this new service connects pharmacy to multidisciplinary healthcare colleagues to promote awareness of the importance of liver health and how it can affect overall health, while increasing access to preventative care across the country.
From July 2023, selected Boots pharmacies in Dublin, Cork and Galway will provide this Liver Scanning Service.
Commenting on the new service, Caoimhe McAuley, Director of Pharmacy and Superintendent Pharmacist of Boots Ireland said, “The overall health of our liver is often overlooked when in fact, it should be prioritised, so we are delighted to be able to bring our Liver Scanning Service to fruition on a pilot basis in selected stores. Innovation and expansion of healthcare is key at Boots and being the first pharmacy in Ireland to offer this as a private fee-based service is a prime example of that. We at Boots recognise the need to raise customer awareness of the importance of liver health, its contribution to long-term health and healthy aging, and the lifestyle choices we can all take to protect it. We look forward to welcoming existing and new customers who

want to avail of the service into store over the coming weeks.”
Apart from exercise, there are many other ways in which the liver can be inflamed. For example, non-alcoholic fatty liver disease, or NAFLD as it’s more commonly known, is an umbrella term used to describe liver disorders caused by an increase of fat in the liver. It is, in many cases, due
to a combination of eating more calories than the body needs and leading a more sedentary or inactive lifestyle. It occurs commonly in association with being overweight. High levels of NAFLD are also seen in those living with diabetes, more often Type 2 diabetes (T2D), or earlier stages of altered glucose handling in the body. In the early stages, liver disease causes no symptoms.
Sinn Féin TD for Waterford, David Cullinane recently asked the Minister for Health the estimated first year and full cost of implementing a minor ailments and illness scheme in community pharmacy. The question was raised in the Dail.
Minister Donnelly replied that he recognises the significant role community pharmacists play in the delivery of patient care and acknowledges the potential for this role to be developed further in the context of healthcare service reform.
“In that regard,” he said, “various approaches to extending the scope of practice of community pharmacists are being progressed by my Department. This includes
the introduction of a Minor Ailment Scheme (MAS). The MAS would enable medical card holders to attend their local pharmacist for assessment and treatment for a number of specified ailments rather than initially having to attend the GP to obtain a prescription.
“The main purpose of this is to remove an access barrier to to increase capacity in our healthcare service.
“The full-year cost of implementing the MAS will be comparable to the current spend for those conditions under the General Medical Services (GMS) scheme, although it is likely that the spend will include a combination of both transferred activity and new activity.
“The spend under GMS in 2022 for the conditions being considered for inclusion in the MAS was approximately ¤15.1m.”

The pharmacy regulator and pharmacy representative bodies have welcomed the announcement of the potential for building capacity in higher education programmes for pharmacy.
Tom Murray IPU Honorary Treasurerpharmacy and education space, to consider workforce issues and to create a framework to respond to future pharmacy workforce needs as part of a whole of healthcare approach. These recommendations include ensuring that the number of pharmacy students being trained in Ireland is sufficient to meet the needs of the sector, informed by national strategic workforce planning and modelling.”
A team of scientists from around the globe, including those from Trinity College Dublin, has gained high-res structural insights into a key bacterial enzyme, which may help chemists design new drugs to inhibit it and thus suppress disease-causing bacteria.
Their work is important as fears continue to grow around rising rates of antibiotic resistance.
The Higher Education Authority (HEA) report to Government recommends that with additional investment, there is scope to create over 190 places in pharmacy education annually and up to 1,400 places across healthcare and veterinary medicine.
The announcement by Government Ministers follows the request to the Higher Education Authority to assess the potential for additional third level places to meet future workforce needs and skills development across five professional disciplines.
The PSI was pleased to participate in the HEA’s Expert Advisory Panel earlier this year to review institutions’ proposals for expanding the capacity of academic places.
As the regulatory authority for pharmacy in Ireland, the PSI has an important role in assuring high standards of education and
training in pharmacy. The PSI is responsible for accrediting and approving educational programmes for pharmacy and for setting the accreditation standards that must be met on an ongoing basis by the approved pharmacy programme providers.
PSI Registrar and Chief Officer, Joanne Kissane, said, “The standard of pharmacy programmes in Ireland is high, and we will play our part to support any future developments so that, with education providers, we maintain the requisite high standards in education and training for qualifying pharmacists whose knowledge and competence must meet patient and health service needs and ensure safe and effective patient care.
“The opportunity to increase the number of pharmacy graduates in Ireland aligns with some of our ongoing work undertaken with partners across the health,
The 10th All Ireland Pharmacy Conference (AIPC) will be held at Ballymascanlon House Hotel, Dundalk on 6th and 7th November 2023. The theme for this year’s conference is ‘Creating Momentum & Building Capacity’

This conference is jointly coordinated by the Northern Ireland Centre for Pharmacy Learning and Development and the Irish Institute of Pharmacy. Its focus is to share good practice in pharmaceutical care and practice development across the primary and secondary care sectors.
Tom Murray IPU Honorary Treasurer said, “Ireland has traditionally relied on other countries, primarily Britain, to educate our pharmacists. Last year saw just 155 new pharmacy graduates from Ireland enter the register less than half of the total new entrants to the professional register. The potential to significantly increase the education of pharmacists in this country would be hugely welcome and provide a much more solid foundation to the community pharmacy sector.”
“While there is now an action plan to train more pharmacists, this will take time. There is a pressing need to deal with the shortages within the profession today. Many pharmacist vacancies are going unfilled, and this can only have a negative impact on patient experience. With a growing and ageing population, we estimate there is a significant shortfall of pharmacists working in the sector. One short term action we would like is to make it as easy as possible for pharmacists from nonEU countries to relocate and work in Ireland,” concluded Mr Murray.
The scientists, led by Martin Caffrey, Fellow Emeritus in Trinity’s School of Medicine and School of Biochemistry and Immunology, used nextgen X-ray crystallography and single particle cryo-electron microscopy techniques to “look under the bacterial bonnet” and produce a molecular blueprint of the fulllength enzyme that may be used to design drugs that attack any structural weaknesses.
Because the enzyme Lnt is not found in humans – it only exists in bacteria and helps them build stable cell membranes through which things are transported in and out of cells – it is of huge potential significance as a therapeutic target as any bespoke drug designed to attack it should have fewer side-effects for patients.
Martin Caffrey said, “A number of disease-causing bacteria have developed resistance to a plethora of first-choice drugs used to treat them and, with antimicrobial resistance on the rise in general, the World Health Organization has for some time now advised that a postantibiotic era, in which minor injuries and common infections could prove fatal, is looming.
“New drugs are therefore badly needed and, while the journey can be a long one from providing a structural blueprint like this to developing a new drug, the precision to which we have resolved this potential target paints something of a ‘bullseye’ on that target.”
Pharmacists, technicians and qualified assistants are encouraged to exchange ideas for pharmaceutical service development in the Republic of Ireland and Northern Ireland.
On the evening of Monday 6th November, the conference dinner will take place at 8.00pm and provides an opportunity to network with colleagues. The main conference proceedings will start at 9.30am on Tuesday 7th November and will involve parallel oral sessions and poster presentations. Visit www.allirelandpharmacyconference.com for full details.
This work was supported by multiple funders, including Science Foundation Ireland, the European Research Council, the Marie Sklodowska-Curie programme, and the Irish Research Council.

E45 Cream creates a protective barrier to lock in natural moisture. E45 cream is used for treating dry skin conditions such as dry/flaky skin, eczema, itchy skin, dry psoriasis, and sunburn. Suitable for the whole family. Apply 2-3 times daily for best results.




The European Commission, the Heads of Medicines Agencies (HMA) and the European Medicines Agency have issued recommendations for actions to avoid shortages of key antibiotics used to treat respiratory infections for European patients in the next winter season. These recommendations, which have been developed through the Executive Steering Group on Shortages and Safety of Medicinal Products (MSSG), complement the process to develop an EU list of critical medicines. In close cooperation with the EU Member States, the Commission will take operational follow-up actions, including, if necessary, possible joint procurements.
Emer Cooke, EMA Executive Director
If the demand in the coming winter season is similar to an average level of consumption in previous years, the data collected suggest that supply to the EU of oral formulations of key first and second-line antibiotics for respiratory infections will match demand in the coming winter season. EMA and the European Health Emergency Preparedness and Response Authority (HERA) will continue to work with marketing authorisation holders to strengthen measures to increase the supply of some intravenous antibiotics.
To be better prepared for the winter season, the EMA’s Executive Steering Group on Shortages and Safety of Medicinal Products (MSSG) agreed on the following recommendations for pro-active actions:
• Increase the production of key antibiotics: To avoid shortages in the upcoming autumn and winter season, EMA and HERA are recommending to continue to engage with marketing authorisation holders to step up
measures to increase production. Early action ahead of the autumn and winter season should give manufacturers enough time to ensure they have sufficient manufacturing capacity to meet the demands.
• Monitoring of supply and demand: EMA and the Commission, together with Member States will continue to monitor the demand and supplies in cooperation with companies. Given that the measures taken are designed to ensure sufficient supply, all stakeholders are reminded to order medicines as normal, with no need to stockpile medicines. Stockpiling medicines can put further strain on supplies and cause or worsen shortages.
Public awareness and prudent use: Antibiotics should be used prudently to maintain their efficacy and avoid antimicrobial resistance. Medical professionals have a key role to play, and antibiotics should only be prescribed to treat bacterial infections. They are not suitable for treating viral infections such as cold and flu, where
they are not effective. Citizen awareness-raising initiatives are also advised.
Next steps
In line with the European Council conclusions of June 2023, EMA and the Commission through HERA will continue to closely monitor demand and supply and interact with marketing authorisation holders throughout the rest of the year to detect early any unexpected shortfalls of supplies and take any necessary measures. A dedicated HERA Board meeting with representatives of the Member States’ Ministries of Health, the Commission and the industry will take place on Thursday, 20 July to discuss the matter further and agree on possible additional steps.
Stella Kyriakides, Commissioner for Health and Food Safety, said, “The availability of medicines is a crucial component of a strong European Health Union. It is essential that we take action now to prepare ahead of next winter and ensure that potential shortages of antibiotic medicines are avoided. Today we are taking
an important step on measures to address our immediate needs for key antibiotics, complementing the on-going process to develop an EU list of critical medicines. Operational follow-up by HERA and EMA will now follow as a matter of priority.”
“Based on the data received we are working to ensure that we are better prepared for the upcoming winter season,” said Professor Karl Broich, chair of the Heads of Medicines Agencies (HMA). “These early projections will allow the European medicines regulatory network to work with stakeholders to take measures in advance and prevent potential shortages for patients in the upcoming winter season.”
“It is important that manufacturers take early action, ahead of the winter season, so that they can ramp up manufacturing capacity where necessary,” adds Emer Cooke, EMA’s Executive Director.
“The availability of medicines is a crucial component of a strong European Health Union. It is essential that we take action now to prepare ahead of next winter and ensure that potential shortages of antibiotic medicines are avoided”

From September 2023, the EU will phase out fluorescent lighting. This may directly affect your business, so why not beat the rush and apply for a fully funded lighting upgrade from Energia? You can get your old fluorescent lighting replaced, while also reducing your lighting consumption by up to 80%. We’ll make it easy by managing the entire process from start to finish.
Find out more at energia.ie/lighting
Irish Pharmacy News recently caught up with Hillary Collins, People and Culture Director at PHX Ireland.
Hillary re-joined the growing Irish Business less than a year ago and here she outlines for readers her People strategy and the cultural transformation journey for the Business with the ambition of making LloydsPharmacy “A Great Place to Work.”


LloydsPharmacy – Changing for the Better

self and feel supported, valued, and listened to every day.
She says, “Our people are at the core of our business. Their diversified talent, skills and experiences is what sets LloydsPharmacy apart and will help us to make a difference to Irish healthcare and patient lives.

As the People and Culture Director, working along with a team of talented and passionate HR professionals, Hillary’s goal is to ensure the workplace culture is one where “our people” can truly do their best work, be their true
“With the ongoing challenges recruiting Pharmacists, one of the first changes we have introduced is the Employee Value Proposition (EVP) and People Strategy to build our employer brand so we can attract, develop, recognise and reward our people for their valuable contributions in supporting our mission to deliver health across Ireland.”
Hillary outlines the 6 key pillars within her “Our People” strategy with a focus on Diversity and Inclusion, Recognition, Listening through feedback, Developing career paths, Supporting employees at every stage and
Representing the communities we live in through our CSR initiatives. So what is changing at LloydsPharmacy?
Pillar 1

understand and embrace our differences,” she adds.
Some examples of the Diversity and Inclusion Initiatives include:
Hillary explained how she is creating a workplace where all staff feel comfortable to be their authentic selves all year round.
“We already have a culturally diverse workforce with many of our employees coming from international markets and its
• Pride Campaign June: education-based initiatives with guests speakers like Nigel Owens
• Female Centric Mentoring to support our female teammates grow in confidence and role

• Partnership with Trinity Centre for People with Intellectual difficulties seeking to offer student work

The new “Our People” strategy being introduced by Hillary Collins, People and Culture Director for PHX Ireland: encompassing LloydsPharmacy, United Drug and TCP.Members of the United Drug and LloydsPharmacy teams enjoying the Pride Ice Cream van delights during Pride Month!
to develop key employment skills and also create our own working environment that is more inclusive of the communities we servce
• Leadership engagement programme, feeds into the development of our D&I charter and our work towards bronze accreditation with Irish centre for diversity.
Pillar 2
Some examples include:
• Induction: consisting of self-directed e-learning, manual handling practical training, a buddy system, sessions with guest speakers and group discussions.
• Pharmacist CPD training and weekly bulletin updates
• Mentoring from Superintendent Pharmacist and monthly Superintendent support calls

• Access to e-learning
• Support from Dedicated Pharmacist Experience Program Manager throughout career

Senior Pharmacists with APPEL and TCQR support teams practicing mock interviews in preparation for exams: Gaby O›Shaughnessy, Maureen Reidy, Nancy UkongaOmowa, Denis O’Driscoll, and Martin Hynes

Pillar 3 Recognising you…
Hillary adds, “In addition to developing our own teams, there has been a huge focus in developing Pharmacy students through APPEL, Erasmus Programmes and supporting local and international universities.”
Hillary believes the LloydsPharmacy APPEL and EU programmes are the best available in Ireland. “We provide the most comprehensive and detailed programme including a bespoke induction, a dedicated mentor assigned for support and guidance, access to OTC training, support from the Superintendent Pharmacist and Clinical Governance Pharmacist as well as OSCE practicals to support students for their mocks.
“Not only do ensure that our programmes are developed for Pharmacists by Pharmacists but we are holistic in our pastoral care and support aiding and supporting that transition from third level to a successful first step on their career ladder.
Hillary’s personable and open management style helps encourage employees to share their achievements and successes.
Hillary is passionate about “acknowledging and recognising our employees’ positive impact, dedication, and commitment across our pharmacies and showcasing the great work of our people and the difference they make to our customers and patients every day.”
“Recognising you” Awards Initiative





Revamped this year, the Internal Employee “Recognising you” Awards programme incorporates a recognition event for all finalists along with some local hero events to recognise and celebrate the hundreds of other colleagues nominated along the way.
Pillar 4 Hearing you…
Hillary is passionate about developing people, “so they can be and do their best, with a focus on creating their own personal development and career growth journey.”
One of the key strengths of working for LloydsPharmacy is the comprehensive, best in class training and development programmes to encourage personal growth and career progression.
• Training Summit: the in-person colleague training event designed to provide product knowledge, sales tips, and expertise to enhance patient service
• Participation in mentoring new Pharmacists, APPEL and EU students
• Opportunities to join Mentoring and Training panel for OTC colleagues, contribute to SOPS and become a member of Pharmacist Steering committee
“Our dedicated Pharmacist Experience Program manager also provides the unique role of supporting EU Pharmacists to settle into LloydsPharmacy and Ireland,” she reflects.
Another key pillar is the belief in continuously seeking feedback and actively listening to her people.
Hillary joins the Pharmacist Steering Committee and calls, and can be regularly seen walking through the offices and out in Pharmacy, meeting and greeting the people.
Initiatives like the annual survey seeking feedback from all colleagues is a benchmark to monitor progress.
support (bank account, PPS number, PSI registration etc.)
Hillary Collins recently visited the LloydsPharmacy Lucan SC team bringing some nice cupcakes as a celebration of their dedication and customer focus.
Left to right: Team includes Ana, Adina, Marie Claire, James, Hillary, Chloe and Saoirse.

We offer a fantastic relocation package to help support you in your move:
Pillar 5 Representing you…
Hillary Collins listening to the Lucan Pharmacy colleagues feedback on new People initiatives being implemented.
Left to Right: Kerry, Adina, Hillary, Saoirse and Chloe.
Hillary goes on to tell us, “As a company, we want to make a positive difference in Ireland. The Charity Programme gives our colleagues and customers the chance to support a cause that is close to their hearts and benefits the local communities where we work and live.
“We value what our employees value and hence collectively we can do good, give back and change lives. Every two years we invite our employees to select their preferred charity, so it has personal meaning to them. The ISPCC won the largest votes in the recent poll and so far thanks to the generosity and dedication of our teams, we have raised over ¤20,000 from our collective fundraising initiatives.”
Pillar 6 Supporting you…

the latest developments in the community pharmacy sector, share CPD opportunities and are readily available to assist and support with any issues that may arise.
“We have also enhanced our benefits packages offering our people a growing range of financial, health and wellbeing, and lifestyle benefits including access to Laya Healthcare wellbeing resources available 24/7 such as digital gym, wellbeing course, recipes, and more.”
Interested in a New Career with LloydsPharmacy?
Hillary acknowledges that as one of Irelands leading Pharmacy chains with over 80 Pharmacies, the company’s strength lies in the ability to provide Pharmacy teams a strong support network of specialists and peers from IT, HR, Sales, Legal, Operations, Marketing and Procurement.

According to Hillary, “Our Pharmacists are also uniquely supported by a Superintendent Pharmacist, and a Clinical Governance Pharmacist to ensure Pharmacists meet all regulatory and contractual requirements. They advise Pharmacists of
Hillary advises, “By joining Lloydspharmacy, one of Irelands largest Community Pharmacy chains, you will join a team who will place your development and success at the centre of everything we do. With competitive rates, flexible arrangements, and a vast array of benefits, we pride ourselves on looking after you at every stage of your career journey.”
Currently there are some open roles in LloydsPharmacy for Supervising and Support Pharmacists, and Pharmacy Technicians, across various locations in Ireland, both rural and urban.


Get in Touch Today
Check out the Careers Section online to read more about what open roles are available at LloydsPharmacy Ireland.







Hillary Collins is a Longford native, currently living in Celbridge Kildare. She is married to Nick with 3 boys. Hillary has over 20 years experience working in Human Resources many at international leadership level. When she’s not working – Hillary loves reading, music and travel.
Hillary re-joined the business in late 2022 having worked there for 6 years earlier from 2011 – 2017.
Highlights of her career to date include: Combination of the 6 years previously spent at United Drug citing them as being “most formative years in career”, as well as the vast international experience gained from working for her previous company, in outsourced healthcare solutions and express logistics, as CHRO supporting 6,000 employees across 12 different countries, and 8 different languages.
When asked why she re-joined the Irish team Hillary notes, “When the opportunity arose to re-join the Irish team and continue their good work during COVID-19, I didn’t need to be asked twice, I grabbed this wonderful opportunity with both hands.”



Fitzgerald Power regularly update community pharmacy across Ireland as to the latest trends affecting the sector.
Their quarterly reports offer valuable insight and expert analysis into how the Pharmacy and SME markets are performing.
Every three months the team look at the key trends of certain sectors, and provide thorough breakdowns to help you get members get their heads around the numbers.
The below is a summary of the latest analysis of the key trends in the Irish Community Pharmacy sector, prepared on a quarterly basis.
After falling by an estimated 0.8% in 2022, the Central Bank of Ireland expects average real household disposable income to increase by 2.1% and 2.3% in 2023 and 2024, respectively.
In efforts to tackle the on-going medicines shortages, the EU is preparing to stockpile drugs and oblige manufacturers to guarantee supplies. In Ireland, 212 products are out of stock, including cough syrups and vital antibiotics.
The suppliers of the majority of medicine in Ireland has urged the Government to heed warnings from GPs and pharmacists nationwide on the growing risk of medicines shortages.
Inflation in the eurozone was 6.9% in March 2023, a decrease from 9.2% at the end of the previous quarter. Energy prices have continued to plummet with inflation at -0.9% vs 25.7% in December 2022.
The Irish Central Bank expects inflation to average 5% in 2023, with the rate of increase in energy prices forecast to decline rapidly as the year progresses. HICP inflation is forecast to moderate to 3.2% and 2.2% in 2024 and 2025, respectively.
The volume of sales, as measured by the CSO, increased by 0.6% in March 2023 against the same period last year.
Volume of Sales: CSO 0.6%
SOURCE: CSO
IQVIA data shows the largest growth in RX classes was
After falling by an estimated 0.8% in 2022, the Central Bank of Ireland expects average real household disposable income to increase by 2.1% and 2.3% in 2023 and 2024, respectively.
In efforts to tackle the on-going medicines shortages, the EU is preparing to stockpile drugs and oblige manufacturers to guarantee supplies. In Ireland, 212 products are out of stock, including cough syrups and vital antibiotics.
The suppliers of the majority of medicine in Ireland has urged the Government to heed warnings from GPs and pharmacists nationwide on the growing risk of medicines shortages.
Inflation in the eurozone was 6.9% in March 2023, a decrease from 9.2% at the end of the previous quarter. Energy prices have continued to plummet with inflation at -0.9% vs 25.7% in December 2022.
The Irish Central Bank expects inflation to average 5% in 2023, with the rate of increase in energy prices forecast to decline rapidly as the year progresses. HICP inflation is forecast to moderate to 3.2% and 2.2% in 2024 and 2025, respectively.
SOURCE: CSO
to decline rapidly as the year progresses. HICP inflation is forecast to moderate to 3.2% and 2.2% in 2024 and 2025, respectively.
Parasitology 27%
Diagnostic agents 19%
Alimentary & Metabolism 13%
Respiratory system 13%
Various 13%
SOURCE: IQVIA
32% 15% 11% 8% 7% urged in
25 15 20 10 5 0
25 15 20 10 5 0
Diagnostic agents 19% Parasitology 27%


Parasitology 27%
Diagnostic agents 19%
Anti Neoplast+Immunomodul 32%
Alimentary & Metabolism 13%
Respiratory system
Respiratory system 13%
Alimentary & Metabolism 13% Various
Various
SOURCE: IQVIA
13%
Top RX Classes by Value Market Pulse
Nervous system 15%
Alimentary & Metabolism 11%
Systemic anti infectives 8%
Respiratory system 7%
SOURCE: IQVIA
PSI data suggests there have been 7 net openings since January 2023, bringing the number of community pharmacies in Ireland to 1,913.
32% 15% 11% 8% 7%
New Openings and Closures
Anti Neoplast+Immunomodul 32%
Nervous system
Nervous system 15%
15%
Metabolism
Alimentary & Metabolism 11%
11%
Systemic anti infectives 8%
New Openings between 1st January ‘23 – 31st March ‘23 11
Respiratory system 7%
SOURCE: IQVIA
SOURCE: IQVIA
Closures between 1st January ‘23 – 31st March ‘23 4
Net Openings between 1st January 2023 – 31st March 2023 7
SOURCE: PSI
Irish Pharmacy News has been working with data analyst company, IQVIA, for the last eight years to comprise this annual report which highlights the Top 100 Over-the-Counter pharmacy brands in Ireland.
The information contained over the following pages is widely accepted as the industry standard from which brand performance is measured across the OTC sector.
We spoke to General Manager of IQVIA, Gwynne Morley, to gain further insights into how these statistics are compiled and on the value of this market to pharmacy.

The Top 100 Over the Counter (OTC) Market Report is based on the total value of wholesale sales for OTC products into retail pharmacy over the course of the previous 12 months to April 2023 (May 2022- April 2023).

It’s a rolling annual value which includes the 5 major OTC categories including Pain relief, Cough and Cold remedies, Vitamins and Minerals, Skin and Digestive Health.
IQVIA (NYSE:IQV) is a leading global provider of advanced analytics, technology solutions, and clinical research services to the life sciences industry. IQVIA creates intelligent connections across all aspects of healthcare through its analytics, transformative technology, big data resources and extensive
domain expertise. IQVIA Connected Intelligence™ delivers powerful insights with speed and agility — enabling customers to accelerate the clinical development and commercialization of innovative medical treatments that improve healthcare outcomes for patients. With approximately 86,000 employees, IQVIA conducts operations in more than 100 countries.
Present in Ireland since 1990, IQVIA pioneered the country as a hub for clinical research. In addition to supporting life sciences in their clinical efforts across Europe and the globe, IQVIA’s activity in Ireland includes supporting the life sciences industry from R&D through to commercialization, as well as healthcare providers, to improve treatment outcomes and patient pathways.
The total value of the Over the Counter (OTC) market in Ireland based on IQVIA’s data for the 12 months, May 2022 to April 2023, was €559 million.1 This market grew by 11.2% (value) & 7.3% (volume) when comparing year-on-year growth.2
Gwynne notes, “The 5 major OTC categories (including Pain Relief, Cough, Cold and Respiratory products (CCR), vitamins and minerals, skin and digestive health) account for €445 million1 of the total value. Double digit growth in the pain relief and CCR categories are driving the growth in Ireland.” (See Figure 1.)
Readers can note below the previous period growth rate Moving Annual Total (MAT) April 20232 for each of these five categories:
Two major factors positively impacted market growth in 20223 according to Gwynne.
1. A strong cough and cold season, starting earlier than anticipated with high incidence worldwide.
Two major factors positively impacted market growth in 20223 according to Gwynne.
1. A strong cough and cold season, starting earlier than anticipated with high incidence worldwide.
“In the final week of 2022, the estimated level of total influenza cases in the US was 2.1 times the same level of the corresponding week of the baseline period – three-year average of 2016/17, 2017/18, 2018/19, - further strengthening the fact that unusually high levels of incidence were being experienced over the total season, however by mid-January a slowdown had taken full effect with illnesses trending in line with the most recent 3-year seasonal average.4
“This drop off was similar to the one witnessed in Australia, which started fast but then dropped off rapidly.
“Ireland witnessed the same trends with the ‘tripledemic’, that overwhelmed our healthcare system in the autumn and winter of 2022 to midJanuary 2023. The term ‘tripledemic’ is used to refer to a collision of RSV (Respiratory Syncytial Virus), flu, and COVID-19 to the extent that it might overwhelm hospital emergency departments.”
2. Price increases driven by global inflationary pressures.
“Along with inflation and cost of living, pricing has been the subject top of mind across all consumer goods sector over the past 12 months. In Ireland, price increases contributed 2.2% to the growth of the consumer health market.3
“In consumer health, across the world, there has been variation in how these increases have been implemented – if at all – but what has become clear, is that some consumer health categories are more increase friendly than others. As consumers start making hard choices on where to spend their money, an increase in the wrong category could lead to a
negative impact on revenue. Knowing, when and in what categories to apply increases is crucial as consumers navigate uncertain financial times.”
Globally, Cough, Cold and Respiratory (CCR) products comprise the largest category of OTC market, growing at triple the rate of the global market, and accounted for a 24% global market share in 2022 (see Figure 2).
Gwynne continues, “This rebound reflected continued recovery from reductions in non-COVID viral infections during the pandemic. In Ireland, CCR experienced significant growth in the period from May 2022 to April 2023 (29% PPG MAT 20231), primarily due to the ‘tripledemic’. Despite this significant double-digit growth, pain relief continues to be the most consumed OTC products in Ireland, valued at €160million MAT April 2023 versus €108million MAT April 2023 for CCR.1
“Vitamins and minerals and digestive health continue to experience good growth, albeit single digits, 6.2% PPG
“Today’s healthcare consumer is expecting not just a pill-in-a-pack product. They expect value-added, holistic solutions that blend the physical product in their wider healthcare lifestyle through value-added services such as on-going support via an app; or digital therapeutic products that have a direct impact on their health”
MAT April 20232 and 7.4% PPG MAT April 20232 respectively. In recent years, more people have become interested in taking control of their own health and wellness and this trend has been driven by several factors, including an increase in access to information about health and wellness, the rise of social media, and a growing interest in natural and holistic approaches to healthcare.
“Probiotics that positively affect the gut microbiome outperformed the total consumer health market long-term and saw double-digit growth rates during the COVID-19 pandemic between 2020-2021. Moreover, skin related microbiome products are emerging.
“Calming, sleep and mood enhancing products continue to grow at 11.1% PPG MAT April 20222. This suggests that a significant number of the population continue to struggle with anxiety and insomnia.
“The other category, that has experienced double-digit growth at a rate of 40.1% PPG MAT April 20232, is Antinauseants, otherwise known as treatments for travel sickness. This is clearly related to the lifting of travel restrictions following the pandemic.”
The category that has declined the most in Ireland over the past 12 months is weight loss. Gwynne adds, “Albeit this category in the OTC market is small when compared to those of pain and CCR. Recent innovations in the treatment of obesity in the prescription market has potentially negatively impacted the OTC sector of this category.”
“As the world emerges from the pandemic, consumer trends such as rising awareness of the option to self-medicate and interest in wellness continue to influence the market,” Gwynne tells us.
“While the serious short-term trends still need to be tackled, its crucial to focus on
the longer-term established trends that will shape the future of the consumer health market – especially in e-Commerce and digital innovation.
“Consumer health companies continue to lag behind sectors such as banking and entertainment in adopting digital approaches. The pandemic has driven growth in investment in digital innovations across many markets. Today’s healthcare consumer is expecting not just a pill-in-a-pack product. They expect value-added, holistic solutions that blend the physical product in their wider healthcare lifestyle through value-added services such as on-going support via an app; or digital therapeutic products that have a direct impact on their health.

“Continuing and accelerating this digital transformation within the consumer health industry is essential in enabling the industry to hit the new “sweet spot” of innovation and be fully prepared for a consumer-centric future, with improved outcomes and consumer experience the new key performance indicators for innovation”
“As the world emerges from the pandemic, consumer trends such as rising awareness of the option to self-medicate and interest in wellness continue to influence the market,” Gwynne tells us.
“Currently, established models of commercial viability and brand fit continue to be applied in the consumer health industry, by contrast providers, health plans and other stakeholders are already turning to digital approaches to meet consumers’ evolving needs and expectations, improve patient engagement and experience, and drive loyalty. COVID-19 has accelerated emerging health care trends, including shifting consumer preferences and behaviours, the integration of life sciences and health care, implementation of digital health technologies, development of new talent and care delivery models, and clinical innovation. Continuing and accelerating this digital transformation within the consumer health industry is essential in enabling the industry to hit the new “sweet spot” of innovation and be fully prepared for a consumer-centric future (Figure 3), with improved outcomes and consumer experience the new key performance indicators (KPIs) for innovation.”4
We also asked Gwynne if the contribution of innovation to the OTC market in Ireland has increased or decreased over the last 12-18 months. She notes that this innovation in the OTC market in Ireland has primarily been driven by the launch of new products recommended for the treatment of pain, sore throat and erectile dysfunction, and to support digestive health and immune system. These launches have contributed sales of €2.2 million MAT April 20231 to the Irish OTC market.
“As discussed above, today’s healthcare consumer is expecting a holistic approach to their wider healthcare lifestylesolutions that combine the physical product with value-added services such as on-going support via an app; or digital therapeutic products that have a direct impact on their health.
“The first wave of digital health tools has empowered users to manage their own health, and to proactively identify issues that require healthcare interventions. Wearables and fitness watches monitor health and wellness, providing consumers and healthcare professionals with data about the user’s heart health, exercise, and mental health.4
“However, we are now on the cusp of the next wave of digital consumer health trends. The evolution of digital health is expanding beyond wellness apps, to transform the way consumers use products. The most innovative companies are looking at ways to use connected sensors, smartphone cameras, diagnostic algorithms, and wearables to capture data, provide feedback, and help consumers and healthcare professionals customize how they manage their own health or those of their patients.4
“Biometric sensors can be included in such devices or used separately, as in connected glucose or heart rate monitors while even basic smartphone tools such as the camera and microphone can measure health-related data. For example, stress levels can be tracked through fingertip
photoplethysmography, a non-invasive approach using a light source and a photodetector at the skin’s surface to measure variations in blood circulation. Smartphones can also detect the sound signature of coughing and snoring. Data gathered via these devices can then be analysed using diagnostic algorithms and AI/ML approaches, a development which is having an increasing impact on consumer health on both the consumer and manufacturer sides. In addition to consumer users, public health agencies are already utilizing digital health technologies, with the UK National Health Service (NHS) using voice-assisted technology to deliver health information from websites.4
“Possibly the biggest opportunity for the consumer health industry with the rise of digital health, is its ability to streamline clinical trials and open-up new ways of generating evidence. The industry can use virtual tools to collect health data through digital channels, helping to make research less burdensome and more consumer centric, whilst improving adherence and outcomes, and gaining an improved understanding of the real-world efficacy and safety of products and services.”4
e-Commerce and e-Pharmacy have been on the minds of consumer health industry leaders for over two decades and are leading to changes in how industry engages with consumers. However,


consumers haven’t abandoned retail pharmacy entirely even during the pandemic, with advice and consultation still valued highly, says Gwynne.

“Before looking at the commercial opportunities of e-pharmacy, it is important to bear in mind the regulatory differences that impact how e-Pharmacies operate in each country.
Regulations governing the online sale of healthcare products vary across countries with governments taking different approaches across which product classes can be sold online, who can sell which product class, the requirement for e-Pharmacies to have a physical presence or not, and cross-border sales regulations. Prescription medicines are not permitted to be sold online in Ireland. However, the sale of non-prescription medicines is allowed.
“We are also seeing a difference globally in how e-Commerce/ e-Pharmacy, where permitted, is being adopted - the cultural difference between mature consumer health markets such as Germany and more dynamic younger markets such as China.5
“Within the European Union, the share of consumer health sales accounted for by online purchases varies from country to country, but Germany remains the leader with the most mature online market and relatively stable growth.8 Overall, the OTC products with the highest online market share were those for chronic diseases and those with high prices or in categories requiring sensitive or confidential handling.
“Unlike Germany – or most of Europe –China’s online consumer health market is widely integrated across the country’s powerful e-Commerce and social e-Commerce channels. All e-Commerce through social media channels – termed social e-Commerce – through sites such as PDD, WeChat and TikTok, accounted for 28% of Chinese e-Commerce in 2021, growing 53%.”5
Gwynne reflects that robust growth is projected for the global OTC market over the next four years despite continued macroeconomic challenges, inflationary pressures, cost of living increases and changing consumer behaviours.
“In 2023, 6.8% growth is forecast, followed by 5.9% growth in 2024 and 5.5% in 2025. These are comparable to typical pre-
pandemic growth rates of 5-6%. Most regions are expected to align with the global rate, seeing accelerating growth; Ireland is forecasted to grow at 6% in 2023 and 7% in 2024.”5
“Volatility is the key global trend impacting consumers and businesses. Inflation, cost of living, supply chain issues are changing purchasing behaviours,” says Gwynne.
“Consumer mindsets are inevitably impacted by global macroeconomic factors as well as the gradual emergence from the COVID-19 pandemic. Across markets, consumers are being more considerate of where they spend their money, however, maintaining their health and those of

their families remains a key aspect of their lifestyles. Yet, choices are being made between ‘need to have’ healthcare products and ‘nice-to-have’ aspirational products, altering the market dynamic across categories.”
She concludes, “According to a Global Consumer Insights Pulse Survey6, half of all consumers are either very or extremely concerned about their own personal financial situation. And 96% of surveyed consumers intend to adopt some type of cost-saving behaviour over the next six months. Shopping less, both in-store and online, with many concerned about potential stockouts, especially of essential products.7 The majority (82%) of supply chain leaders anticipate challenges will worsen or stay the same during the next 6 to 12 months.”8
References:
1. IQVIA OTC Ireland Monthly Database, MAT April 2023
2. IQVIA OTC Ireland Monthly Database, Previous Period Growth April 2023
3. IQVIA Europe Consumer Health Trends 2023 Webinar Presentation, March 2023
4. IQVIA White Paper, The Next Wave of Self Care Digital Health, February 2023
5. IQVIA White Paper, Global Consumer Health Trends, June 2023
6. https://www.pwc.com/gx/en/industries/consumer-markets/consumer-insights-survey
7. https://prod.ucwe.capgemini.com/wp-content/uploads/2023/01/Final-Web-VersionReport-Consumer-Trends
8. 2023 State of Supply Chains Report - https://www.coupa.com/ stateofsupplychains/2023

DifflamTM Spray is indicated as an adjunct in the symptomatic relief of painful inflammatory conditions of the throat and mouth1

Difflam Spray (benzydamine hydrochloride), 0.15% w/v, Oromucosal Spray Difflam Oral Rinse (benzydamine hydrochloride) 0.15% w/v, gargle
Please refer to Summary of Product Characteristics (SmPC) before prescribing Indications, Dosage and Administration: Difflam Spray is used as an adjunct in the symptomatic relief of painful inflammatory conditions of the throat and mouth. Difflam Oral Rinse is a locally acting analgesic and anti-inflammatory treatment for the relief of painful inflammatory conditions of the mouth and throat including:
Traumatic Conditions: Pharyngitis following tonsillectomy or the use of a naso-gastric tube; Inflammatory Conditions: Pharyngitis, aphthous ulcers and oral ulceration due to radiation therapy; Dentistry: For use after dental operations. Benzydamine exerts an anti-inflammatory and analgesic action by stabilising the cellular membrane and inhibiting prostaglandin synthesis. Difflam Spray For oromucosal administration. Adults and Elderly: 4 to 8 puffs, 1½-3 hourly. Children (6-12): 4 puffs, 1½-3 hourly. Children under 6: One puff to be administered per 4 kg body weight, up to a maximum of 4 puffs, 1½-3 hourly. Because of the small amount of drug applied, elderly patients can receive the same dose as adults. The spray should be directed onto the affected area. Uninterrupted treatment should not exceed seven days, except under medical supervision. Difflam Oral Rinse Rinse or gargle with 15 ml (approximately 1 tablespoonful) every 1.5 to 3 hours as required for pain relief. Not suitable for children aged 12 years or under. The solution should be expelled from the mouth after use. Difflam Oral Rinse should generally be used undiluted, but if 'stinging' occurs the rinse may be diluted with water. Uninterrupted treatment should not exceed seven days, except under medical supervision. Elderly: No special dosage recommendations are made for elderly patients. Presentation: Difflam Spray: Oromucosal Spray Difflam Oral Rinse: Gargle. Contraindications: Use in patient with a known hypersensitivity (e.g. bronchospasm, rhinitis, urticaria) to Difflam Spray, Difflam Oral Rinse, benzydamine hydrochloride, or to any of the other ingredients listed in the SmPC for Difflam Spray or Difflam Oral Rinse. Warnings and precautions: Benzydamine use is not advisable in patients with hypersensitivity to acetylsalicylic acid or other NSAIDs. Bronchospasm may be precipitated in patients suffering from or with a previous history of bronchial asthma. Caution should be exercised in these patients. Difflam Spray Avoid contact with the eyes. If the condition is aggravated or not improved use should cease.
Difflam Spray contains: • 14 mg of alcohol (ethanol) in each puff. The small amount of alcohol in this medicine will not have any noticeable effects. • less than 1 mmol sodium (23 mg) per dose of 8 puffs, that is to say essentially ‘sodium-free’. • methyl parahydroxybenzoate (E218) which may cause allergic reactions (possibly delayed) • mint flavour with benzyl alcohol, cinnamyl alcohol, citral, citronellol, eugenol, geraniol, isoeugenol, limonene and linalool. These substances may cause allergic reactions. Difflam Oral Rinse Avoid contact with eyes. Difflam Oral rinse is for oromucosal use only and should not be swallowed. Difflam Oral Rinse contains: • 1126 mg of alcohol (ethanol) in each 15 ml dose. The amount in 15 ml of this medicine is equivalent to less than 30 ml beer or 12 ml wine. The small amount of alcohol in this medicine will not have any noticeable effects. • methyl parahydroxybenzoate (E218) which may cause allergic reactions (possibly delayed) • mint flavour with benzyl alcohol, cinnamyl alcohol, citral, citronellol, eugenol, geraniol, isoeugenol, limonene and linalool. Benzyl alcohol, cinnamyl alcohol, citral, citronellol, eugenol, geraniol, isoeugenol, limonene and linalool may cause allergic reactions • less than 1 mmol sodium (23 mg) per 15 ml dose, that is to say essentially ‘sodium- free’. Interactions with other medicinal products and other forms of interaction: There are no known interactions with other medicinal products. Fertility, pregnancy and lactation: Difflam Spray and Difflam Oral Rinse should not be used in pregnancy or lactation unless considered essential by the physician. There is no evidence of a teratogenic effect in animal studies. Undesirable effects: Uncommon (>1/1000, <1/100): Oral numbness (hypoesthesia) and a stinging feeling in the mouth (oral pain). The stinging has been reported to disappear upon continuation of the treatment, however if it persists it is recommended that treatment be discontinued. For details of rare and very rarely reported adverse events see SmPC. Reporting of adverse reactions: Reporting suspected adverse reactions after authorisation of the medicinal product is important. It allows continued monitoring of the benefit/risk balance of the medicinal product. Healthcare professionals are asked to report any suspected adverse reactions via HPRA Pharmacovigilance, Earlsfort Terrace, IRL – Dublin 2; Tel: +353 1 6764971; Fax: + 353 1 6762517. Website: www.hpra.ie. E-mail: medsafety@hpra.ie. Adverse reactions/events should also be reported to the marketing autorisation holder at the email address: pv.ireland@viatris.com or phone 0044(0)8001218267.
Legal Category: Product not subject to medical prescription Marketing Authorisation Number: PA2010/030/002-003
Marketing Authorisation Holder: Mylan IRE Healthcare Limited, Unit 35/36, Grange Parade, Baldoyle Industrial Estate, Dublin 13, Ireland Full prescribing information available on request from: Viatris, Dublin 17. Phone 01 8322250
Date of Revision of Abbreviated Prescribing Information: 29 March 2021 Reference Number: IE-AbPI-Difflam-Spray+OR-002
References: 1. DifflamTM Spray Summary of Product Characteristics. 2. Agarwal A et al. An evaluation of aspirin and benzydamine hydrochloride gargle for attenuating postoperative sore throat:a prospective sore throat: a prospective,randomized, single-blind study. Anesth Analg 2006; 103(4): 1001-1003. Viatris, Newenham House, Northern Cross, Malahide Road, Dublin 17. www.difflam.ie www.viatris.ie
Job code: DIFF-2022-0066 Date of Preparation: October 2022
Irish Pharmacy News has been working with data analysts IQVIA for over eight years in compiling and bringing this information to our readers, pharmacy professionals of Ireland.
Irish Pharmacy News has been working with data analysts IQVIA for over eight years in compiling and bringing this information to our readers, pharmacy professionals of Ireland.

The Top 100 data is collated each year and summarises activity from May ‘22 to April ‘23. IQVIA uses data, technology, advanced analytics, and expertise to help customers across healthcare drive health forward. For many of these customers, having an accurate, timely view of product performance is critical to ensuring they are improving both business and patient outcomes.
The Top 100 data is collated each year and summarises activity from May ‘22 to April ‘23. IQVIA uses data, technology, advanced analytics, and expertise to help customers across healthcare drive health forward. For many of these customers, having an accurate, timely view of product performance is critical to ensuring they are improving both business and patient outcomes.
The Top 100 Over the Counter (OTC) Market Report is based on the total value of wholesale sales for OTC products into retail pharmacy over the course of the previous 12 months to April 2023 (May 2021- April 2023).
The Top 100 Over the Counter (OTC) Market Report is based on the total value of wholesale sales for OTC products into retail pharmacy over the course of the previous 12 months to April 2023 (May 2021- April 2023).


Present in Ireland since 1990, IQVIA pioneered the country as a hub for clinical research.
Present in Ireland since 1990, IQVIA pioneered the country as a hub for clinical research.
In addition to supporting life sciences in their clinical efforts across Europe and the globe, IQVIA’s activity in Ireland includes supporting the life sciences industry from R&D through to commercialization, as well as healthcare providers, to improve treatment outcomes and patient pathways.
In addition to supporting life sciences in their clinical efforts across Europe and the globe, IQVIA’s activity in Ireland includes supporting the life sciences industry from R&D through to commercialization, as well as healthcare providers, to improve treatment outcomes and patient pathways.
In looking at this years’ data, General Manager of IQVIA, Gwynne Morley told us “The 5 major OTC categories (including Pain relief, Cough and Cold remedies, Vitamins and Minerals, Skin Digestive Health) account for ¤378 million of the total value.
In looking at this years’ data, General Manager of IQVIA, Gwynne Morley told us “The 5 major OTC categories (including Pain relief, Cough and Cold remedies, Vitamins and Minerals, Skin Digestive Health) account for ¤378 million of the total value.
“The 5 major OTC categories (including Pain Relief, Cough,
“The 5 major OTC categories (including Pain Relief, Cough,














Cold and Respiratory products (CCR), vitamins and minerals, skin and digestive health) account for ¤445 million of the total value. Double digit growth in the pain relief and CCR categories are driving the growth in Ireland.
Cold and Respiratory products (CCR), vitamins and minerals, skin and digestive health) account for ¤445 million of the total value. Double digit growth in the pain relief and CCR categories are driving the growth in Ireland.



“Innovation in the OTC market in Ireland has primarily been driven by the launch of new products recommended for the treatment of pain, sore throat and erectile dysfunction, and to support digestive health and immune system. These launches have contributed sales of ¤2.2 million MAT April 2023 to the Irish OTC market.
“Innovation in the OTC market in Ireland has primarily been driven by the launch of new products recommended for the treatment of pain, sore throat and erectile dysfunction, and to support digestive health and immune system. These launches have contributed sales of ¤2.2 million MAT April 2023 to the Irish OTC market.

“Today’s healthcare consumer is expecting a holistic approach to their wider healthcare lifestyle - solutions that combine the physical product with value-added services such as on-going support via an app; or digital therapeutic products that have a direct impact on their health.”
“Today’s healthcare consumer is expecting a holistic approach to their wider healthcare lifestyle - solutions that combine the physical product with valueadded services such as on-going support via an app; or digital therapeutic products that have a direct impact on their health.”
In looking towards the current challenges for consumer health companies, Gwynne adds, “As the world emerges from the pandemic, consumer trends such as rising awareness of the option to self-medicate and interest in wellness continue to influence the market. While the serious short-term trends still need to be tackled, its crucial to focus on the longer-term established trends that will shape the future of the consumer health market – especially in e-Commerce and digital innovation.”
In looking towards the current challenges for consumer health companies, Gwynne adds, “As the world emerges from the pandemic, consumer trends such as rising awareness of the option to self-medicate and interest in wellness continue to influence the market. While the serious short-term trends still need to be tackled, its crucial to focus on the longer-term established trends that will shape the future of the consumer health market – especially in e-Commerce and digital innovation.”
*Disclaimer: Please note that the six year comparison listed opposite details a range from Jan-April for the years 2018-22 and from Jan-May for 2023. These, along with other comparisons with previous years, may include brands and categories whose classification may have changed over that period. The IPN/IQVIA Top 100 OTC products and the method of its collation evolves with the pharmacy sector and in this context, comparisons with previous years are for indicative purposes only. As such, all comparative data published in this issue is designed to offer readers a broad reference tool rather than a like for like comparison.
*Disclaimer: Please note that the six year comparison listed opposite details a range from Jan-April for the years 2018-22 and from Jan-May for 2023. These, along with other comparisons with previous years, may include brands and categories whose classification may have changed over that period. The IPN/IQVIA Top 100 OTC products and the method of its collation evolves with the pharmacy sector and in this context, comparisons with previous years are for indicative purposes only. As such, all comparative data published in this issue is designed to offer readers a broad reference tool rather than a like for like comparison.
Please refer to Summary of Product Characteristics (SmPC) before prescribing Viagra Connect (sildenafil) 50 mg film-coated tablets Indications, Dosage and Administration: Indications: For erectile dysfunction in adult men. Dosage and Method of use: Adults: one 50 mg tablet taken with water approx. one hour before sexual activity. The maximum dosing frequency is once per day. The onset of activity may be delayed if taken with food. Patients should be advised that they may need to take Viagra Connect a number of times on different occasions (max of one 50 mg tablet per day), before they can achieve a penile erection satisfactory for sexual activity. If patients are still not able to achieve a sufficient penile erection they should be advised to consult a doctor. Elderly: no dosage adjustments required (≥ 65 years old). Renal Impairment: No dosage adjustments for patients with mild to moderate renal impairment. Dosage adjustments required for those with severe renal impairment, see SmPC. Hepatic Impairment: Dosage adjustments required for those with mild-moderate hepatic impairment, see SmPC. Viagra Connect is contraindicated for patients with severe hepatic impairment (see contraindications). Presentation: Blue, rounded diamond-shaped film-coated tablets measuring 11.2 mm x 8.1 mm, marked “PFIZER” on one side and “V50” on the other. Contraindications: Hypersensitivity to the active substance or to any of the excipients. Co-administration with nitric oxide donors (such as amyl nitrite), nitrates, ritonavir, guanylate cyclase stimulators (such as riociguat) is contraindicated. Agents for the treatment of erectile dysfunction, including sildenafil, should not be used by those men for whom sexual activity may be inadvisable, and these patients should be referred to their doctor. This includes patients with severe cardiovascular disorders such as a recent (6 months) acute myocardial infarction (AMI) or stroke, unstable angina or severe cardiac failure. Sildenafil should not be used in patients with severe hepatic impairment, hypotension (blood pressure < 90/50 mmHg) and known hereditary degenerative retinal disorders such as retinitis pigmentosa (a minority of these patients have genetic disorders of retinal phosphodiesterases). Sildenafil is contraindicated in patients who have loss of vision in one eye because of non-arteritic anterior ischaemic optic neuropathy (NAION), regardless of whether this episode was in connection or not with previous PDE5 inhibitor exposure. Viagra Connect should not be used in patients with anatomical deformation of the penis (such as angulation, cavernosal fibrosis or Peyronie's disease). Viagra Connect is not indicated for use by women. The product is not intended for men without erectile dysfunction. This product is not intended for men under 18 years of age. Warnings and precautions: Erectile dysfunction can be associated with a number of contributing conditions, e.g. hypertension, diabetes mellitus, hypercholesterolaemia or cardiovascular disease. As a result, all men with erectile dysfunction should be advised to consult their doctor within 6 months for a clinical review of potential underlying conditions and risk factors associated with erectile dysfunction (ED). If symptoms of ED have not improved after taking Viagra Connect on several consecutive occasions, or if their erectile dysfunction worsens, the patient should be advised to consult their doctor. Cardiovascular risk factors: Since there is a degree of cardiac risk associated with sexual activity, the cardiovascular status of men should be considered prior to initiation of therapy. Agents for the treatment of erectile dysfunction, including sildenafil, are not recommended to be used by those men who with light or moderate physical activity, such as walking briskly for 20 minutes or climbing 2 flights of stairs, feel very breathless or experience chest pain. For a list of patients who are considered at low cardiovascular risk from sexual activity see SmPC. Patients previously diagnosed with the following must be advised to consult with their doctor before resuming sexual activity: uncontrolled hypertension, moderate to severe valvular disease, left ventricular dysfunction, hypertrophic obstructive and other cardiomyopathies, or significant arrhythmias. Sildenafil has vasodilator properties, resulting in mild and transient decreases in blood pressure. Patients with increased susceptibility to vasodilators include those with left ventricular outflow obstruction (e.g. aortic stenosis), or those with the rare syndrome of multiple system atrophy manifesting as severely impaired autonomic control of blood pressure. Priapism: Patients who have conditions which may predispose them to priapism (such as sickle cell anaemia, multiple myeloma or leukaemia), should consult a doctor before using agents for the treatment of erectile dysfunction, including sildenafil. Prolonged erections and priapism have been occasionally reported with sildenafil in post-marketing experience. In the event of an erection that persists longer than 4 hours, the patient should seek immediate medical assistance. Concomitant use with other treatments for erectile dysfunction is not recommended. Effects on vision: Patients should be advised that in the event of any sudden visual defect, they should stop taking Viagra Connect and consult a physician immediately. Concomitant use with CYP3A4 inhibitors: patients should be advised to consult a doctor before taking Viagra Connect as a 25 mg tablet may be more suitable for them. Concomitant use with alpha-blockers: Caution is advised when sildenafil is administered to patients taking an alpha-blocker, as the co-administration may lead to symptomatic hypotension in a few susceptible individuals. This is most likely to occur within 4 hours post sildenafil dosing. In order to minimise the potential for developing postural hypotension, patients should be hemodynamically stable on alpha-blocker therapy prior to initiating sildenafil treatment. Thus, patients taking alpha blockers should be advised to consult their doctor before taking Viagra Connect. Treatment should be stopped if symptoms of postural hypotension occur, and patients should seek advice from their doctor on what to do. Effect on bleeding: the use of sildenafil is not recommended in those patients with history of bleeding disorders or active peptic ulceration, and should only be administered after consultation with a doctor. Hepatic impairment: Patients with hepatic or renal impairment must be advised to consult their doctor before taking Viagra Connect, since a 25 mg tablet may be more suitable for them. Lactose: The film coating of the tablet contains lactose. Viagra Connect should not be administered to men with rare hereditary problems of galactose intolerance, total lactase deficiency or glucose-galactose malabsorption. Sodium: This medicinal product contains less than 1 mmol sodium (23 mg) per tablet. Patients on low sodium diets can be informed that this medicinal product is essentially ‘sodium-free’. Use with alcohol: Drinking excessive alcohol can temporarily reduce a man's ability to get an erection. Men should be advised not to drink large amounts of alcohol before sexual activity. Interactions with other medicinal products and other forms of interaction: Individuals receiving concomitant treatment with CYP3A4 inhibitors must be advised to consult their doctor before taking Viagra Connect, dosing adjustments may be required, see SmPC. Patients receiving alpha blocker treatment should be stabilised on therapy prior to initiating sildenafil treatment and must be advised to consult their doctor before taking Viagra Connect as dosing adjustments may be required, see SmPC. Caution when sildenafil is initiated in patients treated with sacubitril/valsartan, see SmPC. Fertility, pregnancy and lactation: There was no effect on sperm motility or morphology after single 100 mg oral doses of sildenafil in healthy volunteers. Viagra Connectis not indicated for use by women. Undesirable effects: Very common (≥1/10): headache. Common (>1/100, <1/10): dizziness, visual colour distortions, visual disturbance, vison blurred, flushing, hot flush, nasal congestion, nausea, dyspepsia. For details of uncommon, rare and very rarely reported adverse events and those of unknown frequency, see SmPC. Legal Category: Not subject to medical prescription. Supply through pharmacies only. Marketing Authorisation Number: PA23055/016/001

Reporting of adverse reactions:
Reporting suspected adverse reactions after authorisation of the medicinal product is important. It allows continued monitoring of the benefit/risk balance of the medicinal product. Healthcare professionals are asked to report any suspected adverse reactions via HPRA Pharmacovigilance, Website: www.hpra.ie. Adverse reactions/events should also be reported to the marketing autorisation holder at the email address: pv.ireland@viatris.com or phone 0044(0)8001218267.
There remains an urgent need to maintain a specific focus on men’s health. This is grounded in continued sex differences in life expectancy and mortality, health inequalities between different subpopulations of men, a substantial body of evidence supporting a gender-specific approach to engage more effectively with men, and the imperative to build on progress achieved to date.
What is clear, is that many forces shape men’s health behaviours and lifestyle routines, but what is not always well recognised is that men do want to talk about their health—they just need the right environment in which to do so.
Many of Ireland’s men over the age of 45 are at risk of developing heart disease leading to a heart attack. Combined with rising levels of obesity, diabetes and smoking, many are literally a ticking time bomb.
Research shows that men are nearly three times more likely than women to die prematurely from cardiovascular disease. Inactivity is a major risk for heart attack and stroke. Men typically spend 40 minutes longer sitting down in comparison to women. Blood pressure is also higher in men (69%) compared with women (59%).
Pharmacists can help teach the warning signs of a heart attack. A man’s risk of heart attack greatly increases at 45 so it’s important that all men at the age of 45 (or earlier if a known family history) see their GP for a heart health check to calculate their risk of having a heart attack.
Pharmacists can also educate on heart disease risk factors and encourage male patients to take their health seriously, being well placed to provide men with a wide range of advice, including, the importance of taking their medications, quitting smoking, engaging in regular physical activity and eating a healthy diet.
A recent study has found that 49% of young Irish men under the age of 30 believe themselves to be experiencing some form of hair loss. Hair loss can be caused by a number of conditions, with some being more “permanent” than others.
Traumatic alopecia: This is a man-made form of hair loss caused by hairdressing techniques.
For example, damaging the hair with strong chemicals, such as bleach.
Alopecia areata: In this condition, there are localised areas of hair loss. The cause is unknown and the underlying skin appears normal. There is no specific treatment. The hair growth usually returns to normal within a few months.
Telogen effluvium: This is a type of hair loss that happens two to three months after the body has suffered something very stressful, such as a major surgery.
The most common type of baldness is male pattern baldness (androgenic alopecia). Most people recognise this type of baldness immediately. The hairline begins to recede at the temple, and the hair at the top of the head starts to thin out. After a period of time, the crown area may become completely bald, leaving a piece of hair around the back and sides of the head only.
Because hair loss may cause emotional distress and affect self-esteem, pharmacists and pharmacy staff should be supportive and empathetic to men experiencing it. There is only one medicine licensed to treat male-pattern baldness In Ireland, Minoxidil, available as a lotion which is rubbed on the scalp every day.
While not life-threatening, erectile dysfunction can be devastating for any man to experience. It also has an upsetting effect on partners. Together with the loss of a satisfying sex life is the concomitant loss of self-esteem. Impotence may be the result of a medical condition, such as diabetes, or can be an unwelcome side-effect of some types of surgery. But surprisingly, it is anxiety and stress that are most commonly to blame for a man’s inability to sustain an erection. Abusing drugs or alcohol can also be a source of the problem. For those men who are struggling with a medical issue that inhibits
their ability to perform, new drug treatments offer new hope. Everyone is now aware of the existence of the drug sildenafil (Viagra), the first of a number of well-known anti-impotence medications to come on the market. But there are alternatives to drug treatments for people with erectile dysfunction.
In Ireland men are 5 times more likely to die by suicide than women, and worldwide the rates average out at about three men to one woman. University College Dublin Sociologist Anne Cleary found a common theme among 52 young Irish men who survived suicide attempts: all expressed reluctance to disclose to anyone the “significant, long-lasting” emotional pain they felt. Instead they used alcohol and drugs to cope, worsening their levels of distress, and ultimately leading to a time where suicide seemed to be the only credible way of managing their pain.
Learn to identify the indicators of mental and emotional distress in men and increase awareness of how men express mental and emotional distress. Look out for changing patterns; risky behaviours; excessive work or exercise; or somatic problems like aches, pains, or digestive problems. If they are coming into the pharmacy with injuries,
are irritable or angry, losing concentration, dishevelled and socially isolated, these are factors whereby you should be thinking there might exist some symptoms of mental health issues.
By getting involved in Men’s Health Week and other similar campaigns (such as Movember in November), pharmacists may attract more men in-store and discuss relevant pharmacy services.

Men perceive health and community services as feminine and feminised and as such, think it is not set up for them. Those interested in focusing on men’s health should consider the store’s colour scheme, layout, signage, product placement and the health information available.

Do you have signs with pictures of men on them? What products do you stock that appeal to men, and where are they placed?
Displaying and disseminating health information in nonthreatening retail settings may improve men’s health awareness and encourage men to visit their pharmacy and/or GP more regularly. You will also often see men coming into their local community pharmacy for a range of OTC medicines or treatments for minor injuries such as sports injuries. This gives you further opportunity to target the male population.












Sub-heading:
The number of births in Ireland has decreased by 15.9% in the last year, CSO figures show there were just over 14,000 births in the third quarter of 2022 compared to over 16,500 in the previous year but according to Industry research (IRC) During the projection period of 2023-2030 , the worldwide MoM and Baby products Market is anticipated to grow at an impressive Compound Annual Growth Rate (CAGR)
 Written by Jackie Kelly, Marketing and Trade Director McCauley Health & Beauty Pharmacy
Written by Jackie Kelly, Marketing and Trade Director McCauley Health & Beauty Pharmacy

market and influencing the way parents care for and raise infants and by that nature influence and impact on how they shop and seek advice.
want a wide range of high-tech product designed to enhance safety and convenience, Products like smart baby monitors that offer real tine monitoring to advance sleep and breathing detection – all things that pharmacist are constantly asked about and are in prime position to recommend.
For the purposes of this article, I am not going to focus on what we do best –Advise, consult, recommend, educate and be the first point of call for every future parent or worried parent that stands in our pharmacies needing and receiving expert health and advice from our wonderful caring and thorough pharmacy team but instead look at the business of retailing products in this market space.
The number of births in Ireland has decreased by 15.9% in the last year, CSO figures above show there were just over 14,000 births in the third quarter of 2022 compared to over 16,500 in the previous year but according to Industry research (IRC) During the projection period of 2023-2030, the worldwide MoM and Baby products Market is anticipated to grow at an impressive Compound Annual Growth Rate (CAGR)

For the purposes of this article, I am not going to focus on what we do best –
Advise, consult, recommend, educate and be the first point of call for every future parent or worried parent that stands in our pharmacies needing and receiving expert health and advice from our wonderful caring and thorough pharmacy teams but instead look at the business of retailing products in this market space.
Our core position as pharmacy is to lead with expertise, advice and customer service, this will always be the beating heart of pharmacy. But to compete in a fast moving highly competitive retail space we need to consider what our competitors are doing and what innovation is happening in the space and watch emerging customer trends internationally and combine this with how we traditionally served this market as it is ever evolving.
Smart baby Gear – Technology is revolutionising the baby market, Parents now have access to and want a wide range of high-tech product designed to enhance safety and convenience, Products like smart baby monitors that offer real tine monitoring to advance sleep and breathing detection – all things that pharmacist are constantly asked about and are in prime position to recommend.
Consumption of data is how we live now, and this led to innovation in the space with parents now having access to an entire connected nursery with data feedback from bottles, dummies, sleep mats and more shifting task that where once intuition based to fully automated and relieving stress for the worried parent.
Our core position as pharmacy is to lead with expertise, advice and customer service, this will always be the beating heart of pharmacy But to compete in a fast moving highly competitive retail space we need to consider what our competitors are doing and what innovation is happening in the space and watch emerging customer trends things internationally and combine this with how we traditionally served this market as it is ever evolving.
We have seen growth in the category, by moving away from the traditional retailing of baby food (and low margin/ high stock write off product areas) and other lines that supermarket have more space and depth of offer and taken our lead by researching changing consumer preference. The baby market is constantly evolving and there are some key emerging trends that are shaping the baby market and influencing the way parents care for and raise infants and by that nature influence and impact on how they shop and seek advice.
We have seen growth in the category, by moving away from the traditional retailing of baby food (and low margin/ high write off product areas) and other lines that supermarket have more space and depth of offer and taken our lead by researching changing consumer preference. The baby market is constantly evolving and there are some key emerging trends that are shaping the baby
Smart baby Gear - Technology is revolutionising the baby market, Parents now have access to and
Health and
FocusParents are increasingly prioritizing the health and wellbeing of their babies; this has menaifested in
manifested in
a surge in demand for organic and natural baby care products such as skincare items free from harmful chemicals. Brands are responding with developing products that align with these health-conscious values, this along with the overriding concern for the environment with everyone
Consumption of data is how we live now, and this led innovation in the space with parents now having access to an entire connected nursery with data feedback from bottles, dummies, sleep mats and more shifting task that where once intuition based to fully automated and relieving stress for the worried parent.
Data-obsessed parents can gat a head start on the connected nursery even before birth with smart pregnancy trackers (Credit: Alamy)

From falling birth rates to increased competition from online retailers it is hard to see how pharmacy can maintain its position, never mind find growth in this market.
In today’s busy world if we can guide parents not only in areas when baby is sick but give them options to prevent worry and stress this also feeds into pharmacy being on the frontline with healthcare and in a future world where pharmacy offer more services this is an area that could easily be expanded into.
While the birth rate is falling Ireland remains at above the European average with a fertility average of 1.8 children per woman in 2020 to 1.6 in Europe
Jun 21, 2022The average age of mothers giving birth in Ireland in 2020 was 33.1 years, the highest average age since the age of mothers was first recorded in 1955.
Rise to the challenge
Price increase, pure play
Ecommerce and Digital stores
toward more sustainable and eco – friendly baby products – compostable Water Wipes is a key example. Another area we are seeing growth in and sits very well in the pharmacy sphere is Sensory Product, pharmacist are often asked for recommendation to help regulate and calm children emotions and sensory toys, weighted blankets and ear defenders are a wonderful option for both neurotypical and neurodivergent children .
pharmacy blog content you can maximise shopping opportunities during parents quite moments

The Baby growth rate may fluctuate from year to year but it is in no danger of disappearing and worth the time and investment to protect and prepare for future growth. The Mother figure in the family makes so many health decisions not only for themselves but for all members and if you can be of service, offer expertise and advice at this most crucial time you are creating a strong bond of trust that can flow in to all elements of the Pharmacy journey.
Online Retail – The convenience of online shopping has transformed the baby market .Parents can now easily browse and purchase a vast array of products from the comfort of their home , this can free up valuable space in Pharmacy that may have a smaller footprint but an online presence and even offer smaller stores a space to sell where there is no retail space available while boosting your online offer and drawing the consumer into your business and the vast array of goods and service provided by an already trusted outlet and reflective of the day to day experience had by the customer / patient in your pharmacy provide this end to end retail experience expected by customers and creating an opportunity for growth, in these busy time with the possibility of both parent working and on the go ,shopping on the their mobile is there go to and use the internet to browse ,compare and educate them selves is already standard practise .
While economic challenge persist along with a rising price consciousness, in 2022 Mother and Baby specific products have seen a reliable and stable dynamic, with parents willing to spend and invest in products that care and protect and enhance their children life – a good example of this the children’s Sun Care market, this category has entered a period of rapid growth – I AM WILLING TO BET THAT FACTOR 50 WITH WATER RESISTANCE FOR KIDS IS YOUR TOP SELLER!!!!!
We pride ourselves as pharmacy teams at being at the heart of the community and being able to offer anyone who is on this journey insights on product that can gives them peace of mind for themselves and their little one as well as health advise, this is all part of the service.
Skin protection and vulnerability to allergy is on high awareness for today parent and present growth opportunities for pharmacies with extension of an into existing areas in skin concern This is a space in which we have always had traditional market share and we are best positioned to offer advice of prevention or support on care and treatment and compete with supermarkets and other various non pharmacies retailers.
offering good category segmentation and offering tools that simplify the experience along conjoined with some advice led pharmacy blog content you can maximise shopping opportunities during parents quite moments McCauley Pharmacy


Online Retail - The convenience of online shopping has transformed the baby market. Parents can now easily browse and purchase a vast array of products from the comfort of their home, this can free up valuable space in Pharmacy that may have a smaller footprint but an online presence and even offer smaller stores a space to sell where there is no retail space available while boosting your online offer and drawing the consumer into your business and the vast array of goods and service provided by an already trusted outlet and reflective of the day to day experience had by the customer / patient in your pharmacy provide this end to end retail experience expected by customers and creating an opportunity for growth, in these busy time with the possibility of both parent working and on the go, shopping on the their mobile is there go to and use the internet to browse, compare and educate them selves is already standard practise.
By offering good category segmentation and offering tools that simplify the experience along
Supermarkets especially since covid one stop shopping habits and the tough Regulatory Environment all factor into increased challenges in this market space but despite that the Mom and Baby Market offer significant opportunity for growth in Pharmacy, it is our unique position as trusted advisors that will naturally bring your customer into this space it is within our grasp to provide and full 360 cohesive and integrated journey where we can help advise with all aspects of the parenting journey combing retail growth all the while with our underlying position of always putting our customer /patients first, in conclusion the Mother and Baby market continues to thrive driven by evolving need and customer preferences and it is essential we rise to and met the expectations and help patients navigate the challenges while offering advise led choices.
Key take aways for driving retail growth in other and baby market in Pharmacy.
eCommerce - is becoming the main channel to drive Mother and Baby sales.
Diversify product portfolios
- customer expect that we will lead in this space.
Focus on innovation - Be aware of shopping trends and of how consumers shop them.
New Parents are highly motivated to provide the best for their baby making them a critical target audience – and they shop before baby is born.
Use technology - And as with all our categories advised, inform and educate all hose who seek the advice .
The sleep and stress category is no longer the boring industry it once was referred to. Today, stress and sleep are officially the fastest growing global food supplement category for the second year in a row. With the current socioeconomic climate and rising cost of living, it’s expected that many of us are having trouble sleeping and experiencing stress.
Written by Michelle O’Hagan, Superintendent Pharmacist, The Pharmacy Hub Tallaght
use of screen time, busy lifestyles and work stress. Increased focus on mental health in recent years has resulted in this rising demand of supplements. According to Euromonitor stress and sleeping disorders like insomnia, central sleep apnoea and obstruction sleep apnoea have been in the top three consumer health concerns in recent years.
demand has soared across all age cohorts especially under 75 years. The global stress management treatments market should reach $20.6 billion by 2024 from $17.2 billion in 2019 at a compound annual growth rate (CAGR) of 3.7% for the forecast period of 2019 to 2024. The global stress management market has been segmented on the basis of mode of treatment, end user and age group.
The sleep aid market valued at $67.51 million in 2022 and is expected to grow in at a CAGR of 6.5% during the current forecast period.
ie, 53% report feeling stressed in the 18-35 age group. An increase in elderly population and density in Ireland has contributed to direct market growth.
In 2022, STaDa published a health report in which 37% of European countries said their stress levels worsened during the pandemic and 59% stated they experienced or felt close to burnout.

Historically, sleeping issues were not even discussed as it was identified as an age-related change in sleeping patterns. But in today’s society, it’s an ever-increasing issue in all ages and lifestyles, especially since the excessive

The category is flourishing and is not merely a fleeting trend. The last forecast by Euromonitor leaves us in no doubt with growth in the market at 14.5% in 2021, 14.9% in 2022, and 17.3% predicted in 2023. The pandemic induced sales increase of stress and sleep supplements have certainly sustained and there is no sign of plateauing as the market becomes more innovative and customer
Sleep and General Health of the Nation’s Impact on the Category Stress and sleep are closely linked, and both can lead to chronic health conditions and mental health problems. Latest report in general health of the nation, shows a decrease in health of 4% from 2016 to 2021 in under 75 years of age. As a result, there is more focus now on well being and health of the nation. From the RedCResearch.
Consumers hold a relative share of influence within the industry (51%) and this is evident with the recent rise in innovation and technology. Shopper trends amongst the younger generation drive the industry forward. Nytol is the market leader clinically proven OTC sleep aid in Pharmacies and apart from Panadol Night, it’s the only Pharmacy licensed product available. We do have many other options to choose from when advising on the most appropriate products suitable for self-management of stress and insomnia, e.g., Valerian

*Based on IQVIA sales data MAT 07/2022.
Nytol One-A-Night 50 mg Tablets contains diphenhydramine hydrochloride. A symptomatic aid to the relief of temporary sleep disturbance in adults. Adults: One tablet to be taken 20 minutes before going to bed, or as directed by a physician. Do not exceed the maximum dose of one tablet in 24 hours. Elderly patients or patients with liver or kidney problems should consult their doctor before taking this medicine. Children under 18 years: Not recommended. The product should not be taken for more than 7 days without consulting a doctor. Contraindications: Hypersensitivity to the active substance or to any of the excipients, stenosing peptic ulcer, pyloroduodenal obstruction, phaeochromocytoma, known acquired or congenital QT interval prolongation, known risk factors for QT interval prolongation. Special warnings and precautions: Pregnancy/lactation, renal and hepatic impairment, myasthenia gravis, epilepsy or seizure disorders, narrow-angle glaucoma, prostatic hypertrophy, urinary retention, asthma, bronchitis, COPD. Patients should be advised to promptly report any cardiac symptoms. Tolerance and / or dependence may develop with continuous use. Do not take for more than 7 consecutive nights without consulting a doctor. Should not be used in patients currently receiving MAO inhibitors (MAOI) or patients who have received treatment with MAOIs within the last two weeks Use in the elderly should be avoided. Avoid concomitant use of alcohol or other antihistamine-containing preparations. Do not drive or operate machines. Cases of abuse and dependence were reported in adolescents or young adults for recreational use and/or in patients with psychiatric dis-orders and/or history of abuse disorders. Contains lactose. May suppress the cutaneous histamine response to allergen extracts and should be stopped several days before skin testing. Interactions: Alcohol, CNS depressants, MAO inhibitors, anticholinergic drugs (e.g. atropine, tricyclic antidepressants), metoprolol and venlafaxine, CYP2D6 inhibitors, Class Ia and Class III anti-arrhythmics. Side effects: Dry mouth, fatigue, sedation, drowsiness, disturbance in attention, unsteadiness, dizziness, thrombocytopenia, hypersensitivity reactions, confusion, paradoxical excitation, convulsions, headache, paraesthesia, dyskinesias, blurred vision, tachycardia, palpitations, thickening of bronchial secretions, gastrointestinal disturbance, muscle twitching, urinary difficulty, urinary retention. Legal classification: P. PA1186/016/001. MAH: Chefaro Ireland DAC. The Sharp Building. Hogan Place. Dublin 2. Ireland. Date of preparation: 07/2022. RRP (ex. VAT): 20s €9.00. SPC: https://www.medicines.ie/medicines/nytol-one-a-night-50-mg-tablets-34889/smpc IRE NYT

Root containing products like Kalm Night, FabU Relax, Rescue Remedy and the A.Vogel Stress and Sleep Range.
Other products Pharmacies can stock to extend their category include aroma therapy (e.g. lavender oil), CBD products, herbal teas, pillow sprays and scented candies.
In 2023 there are a lot of sleep aids that have sold well, top ten being:
1. Better Sleep Mattress
2. CBD products
3. Melatonin Infused Oil
4. Weighted Blanket
5. Herbal Teas
6. Headphones for Sleep
7. Sleep Earbuds
8. Deep Sleep Pillow Spray
9. White Noise Sound Machine
10. Essential Oil Diffuser
Many customers are excited by the latest trends in sleep and embracing non-medical options, driving this industry into the future. They include, Smart Bed, SleepCast (e.g., Headspace), Sleep Sensor, App Controlled Mattress Cooler and Contactless Sleep Tracker.
Online evidence shows two thirds of consumers prefer natural healthcare products as they want to avoid unpleasant side effects and get on with their busy lives. Pharmacists can aim to offer a holistic approach to stress management and sleep hygiene rather than solely referring the patient for a prescription medicine. User friendly formulations are growing popular, like increased demand for chewable and gummies and driving innovation in product development. Albeit slow, expect to see products being launched aimed for children. 30% affected by a childhood sleep disorder and only last year Holland Barret launched sleep gummies for kids.
Some people are hesitant to approach Pharmacies and instead choose to purchase online and this is potentially driving revenue away from Pharmacies. Pharmacists need to recognise their value in educating and informing their customers well. There is hesitancy for innovation in Pharmacy licensed products due
to regulatory barriers along with increase in popularity in alternative solutions. Rising cost of bringing OTC products to the market and end sale of the product could potentially become an issue.


The sleep and stress global economy has a current value estimated share of 5.2% of the market and this is significantly increasing year on year. The economy is more than what we know, i.e., prescription medicine, supplements, stress and sleep aids, includes ecommerce as having the edge in this growing market. Whilst Pharmacy business is competing with many new development and innovation it is clear we still have a percentage of the market and are in a key position to increase this OTC share value. Referring to the 1QVIA data report, quarter one 2023 demonstrates the growth in market share and value of the category in Pharmacy. As well as this current increase as shown in the Calm Sleep and Mood category, the vitamins and minerals section have grown 14% in value ad 6% in class and as the consumer looks for alternative sleep aid, this market is one we can capture our niche in.
Building a strong sleep and stress category is an opportunity in increasing Pharmacy revenue. Allocate space to extend your range, make sleep and stress products easy to find, monitor ongoing sales and keep abreast of trends in the market. Consumer request can vary considerably, so it’s important to know your customer base and stock your Pharmacy accordingly.
To grow a category, it is essential to
understand mental health, stress, insomnia, and anxiety and how these causes can be prevented or best managed as we have the potential to make positive impact on our consumers’ wellbeing. Consumers need someone to talk to and Pharmacists can give the reassurance that they are not alone as many may feel. This Sleep and Stress category is one where massive impact may be made in conversation with a patient that can really help lift them and provide direction and support. Pharmacists have opportunities to showcase products in the Pharmacy and encourage consumers to evaluate their lifestyle and diet and play a key role in health promotion by offering OTC medicines and alternative remedies.
Evidence indicates customers are not happy with the amount of treatment choices and are looking for new solutions and turning to technology. Psychological dependence towards mobile phone use is causing sleep deprivation and increased stress and this association with mobile phone usage is reducing sleep quality and spins out into our work/life. Improving sleep habits by one hour from 6-7 hours can significantly impact the economy and a person overall health.Health experts warn society needs to get more sleep. Scientists, like Michael Gradisar, are joining software companies to ensure the industry remains as close as possible to the latest finds.
Ironically, sleep is one of the most undervalued medicines in the world. We as healthcare professionals understand this well
and encourage sleep as far as possible. In the busy world we live in today, 62% people suffer from sleep issues globally. 8 in 10 adults are actively looking for things to help them sleep.
The customer will come in already quite informed and it’s important for healthcare professionals that we have a good knowledge on all the products we sell in the category and to train our staff not only on the products but to recognise red flags. A customer may present with one product in mind and when you explore with further questioning, if this is the most appropriate product for the customer, you often find there is something more suitable to offer. Listen to your customer, hear the question as they may be anxious and need the support and confidence to start a conversation, and some may suggest they are experiencing anxiety, yet we need to consider that there may be an element of depression.
Community Pharmacies can provide a supportive environment to assess a patient, consider your approach of care. Of course, we would love the opportunity to sit the consultation and allow the patient to open, listen to them and discuss a self-management plan for them, however this is rarely possible in a busy community Pharmacy. Set up a simple step approach of products and referral pathway whether that be to other HCPs, GPs, or charities, e.g., Pieta House, Aware, or local counselling services, even social groups, as isolation plays a big part for some in growing anxiety. Direct your customers to reliable resources and have leaflets to hand.
The value of growth may well be tempered by the increased willingness of the Irish consumers to explore alternative methods to improve the duration and quality of their sleep. Expect more premium products to come to the market.
References
TheGoodBody 2022 RedCResearch.ie
EuroMonitorInternational Pharmacy Pulse Quarter One 2023 / 1QVIA 2023 BCCResearch.com
A strong cough and cold season, starting earlier than anticipated with a high incidence worldwide has been one of the driving factors positively impacting OTC market growth in 2022, according to the most recent research from IQVIA.


General Manager with IQVIA, Gwynne Morley, reflects, “In the final week of 2022, the estimated level of total influenza cases in the US was 2.1 times the same level of the corresponding week of the baseline period – three-year average of 2016/17, 2017/18, 2018/19, - further strengthening the fact that unusually high levels of incidence were being experienced over the total season, however by mid-January a slowdown had taken full effect with illnesses trending in line with the most recent 3-year seasonal average.
“This drop off was similar to the one witnessed in Australia, which started fast but then dropped off rapidly.
“Ireland witnessed the same trends with the ‘tripledemic’, that overwhelmed our healthcare system in the autumn and winter of 2022 to mid-January 2023. The term ‘tripledemic’ is used to refer to a collision of RSV (Respiratory Syncytial Virus), flu, and COVID-19 to the extent that it might overwhelm hospital emergency departments.”
The term “common cold” is widely used to describe an upper respiratory tract infection of viral origin. Adults in general suffer from cold approximately two to four times annually while children can contract the virus three to eight times as their immune systems aren’t as developed. Distinctive symptoms means that people often diagnose and treat themselves through a combination of self-care and OTC products, without needing to go to the doctor. If there is no improvement then an appointment with a doctor should be arranged. A GP can do an investigation to rule out whether the symptoms are being caused by a more serious infection, such as pneumonia or glandular fever. All members of staff should be trained up on when to refer a patient for further medical attention, especially if they present with cold or flu-like symptoms that are accompanied by any of the following: high fever, vomiting, a non-blanching rash, photophobia, severe headache
and/or confusion. Children presenting with high-pitched screaming, floppiness, bulging fontanelle, convulsions or stiff neck should go straight to A&E. There is no cure for a cold, but certain measures can be taken to improve comfort levels while the virus dissipates: decongestants, antihistamines and pain relievers might offer some relief from symptoms however they won’t stop a cold from developing and will not shorten its duration. Vitamin C is useful for people in high risk groups who are at high risk of colds due to frequent exposure — for example, nurses or pharmacy staff. Echinacea and Zinc may also benefit patients during the cough and cold season however people should check with their doctors first as these can interfere with some medications. In general though, the best advice to patients suffering from a cough or cold this winter season is to rest, sip liquids, wash your hands, and to stay away from workplaces and school/college until symptoms have improved.
During winter, most coughs are caused by viruses such as colds and flu and can be safely managed at home using OTC remedies. Coughs are classified as “acute” or “chronic”. An acute cough is most common and lasts up to three weeks. It’s usually caused by a cold or flu virus and most improve after one to two weeks.
Chronic cough lasts for eight or more weeks. The most common causes include acid reflux, asthma, TB, COPD, bronchitis and smoker’s cough. Red-flag signs include:
• Coughing up blood
• Unexplained weight loss
• Night sweats
• Cough worsening after three weeks
• Shortness of breath
• Voice changes
• Lumps/swellings in neck
• Chest pain
Dry or chesty cough?
A dry cough is caused by inflamed airways due to a viral infection such as a cold or flu. A chesty cough produces phlegm. This is caused by the lungs producing extra fluid due to an infection.
It is important to get a detailed overview of the patient’s symptoms. Is their cough productive? How long have they had the cough and what action has been taken? Pharmacists should ask if a patient has any medical conditions that may affect any treatment or product you recommend.
Influenza
Influenza is the winter ailment most likely to drive sufferers to the GP or to A&E, and nearly half of them will require antibiotics.
The European Commission estimates that the seasonal flu vaccine prevents somewhere in the region of 37,000 deaths per annum in Europe. Pharmacists have been authorised to administer the flu vaccine, once appropriately trained, since October 2011. The uptake on the flu vaccine has increased every year since and research from the NHS has shown that people are more likely to avail of the flu vaccination service if it is convenient, quick and locally available.
As the vaccine can only be developed once the virus has been identified (which can take months), the European Commission and the European Medicines Agency work together to “speed up the marketing authorisation procedure once a pandemic has been declared.”
In order for the flu vaccination programme to maintain its ongoing success, there must be a high
level of uptake among those aged sixty five years and older. At risk groups should also be targeted by pharmacy teams and the EU urges member countries to commit to vaccinating 75% of at risk groups each year. Those most at risk of developing serious complications from the flu virus include the youngest and the oldest, pregnant women, persons with a BMI over 40, patients with pre-existing long term conditions such as heart, kidney, liver, neurological disease or diabetes, smokers, and patients who are immunosuppressed or immunocompromised. It can also disproportionately affect people with Down syndrome and the virus is known to spread quickly in congregated settings, such as nursing homes or supported living environments. The HSE estimates that over one million people should be vaccinated in Ireland for the programme to be fully effective.
From the flu vaccine to OTC remedies to prescription antibiotics, winter is a good time to drive home the message that the local pharmacy is a one-stop-shop for all those seasonal ailments.
The changing season brings opportunities to re-organise your store, to rearrange fixtures and fittings and to develop a clear merchandising plan featuring beacon brands in both the P and GSL sections. Planograms are helpful guides that can be used to assist with arranging retail shelves to help maximise frontend sales. These visual plans, that are backed by research, show exactly where in the store certain products should be placed and they indicate the products that
Cold vs Flu
Symptoms Fever
Headache
General Aches, Pains
Fatigue, Weakness
Extreme Exhaustion
Stuffy Nose
Sneezing
Sore Throat
Chest Discomfort, Cough
Seasonal flu
High fever lasts 3-4 days
Prominent
Usual; often severe
Can last up to 2-3 weeks
Early and prominent Sometimes Sometimes Sometimes Common; can become severe
will increase profits and move quickly. Store plans also show how products should be arranged based on the general categories and subcategories with the most profitable products typically going onto the shelf at eye level, known as the ‘cone of vision’. Products that shoppers seek out no matter where they are, called destination items, can go on shelves outside of the cone of vision.
Have a look at the shelves that are devoted to winter remedies, both on the shop floor and on the medicines counter, and ask yourself the following questions:
• Is it clear to customers and staff which products are suitable for children and which are for adults only?
• Are your staff up-to-date and clear on the risk of analgesic overdose due to combination products?
• Are staff aware of the sales restrictions for certain decongestants?

• How could you make this fixture easier to understand and navigate?
• Are all staff clear on the symptoms that should ring an alarm bell if mentioned by a patient with a cough, cold or flu?
• Are details about your flu vaccination service clearly displayed?
At-risk patients include:
• Persons aged 65 years and older;
• Persons 10-64 with a chronic illness requiring regular follow up, e.g. chronic respiratory disease (including chronic obstructive pulmonary disease, cystic fibrosis, moderate or severe asthma and bronchopulmonary dysplasia), chronic heart disease (including acute coronary syndrome), chronic renal disease, diabetes mellitus, haemoglobinopathies, chronic liver disease, chronic neurological disease (including multiple sclerosis, hereditary and degenerative disorders of the central nervous system);
• Those who are immunosuppressed due to disease or treatment including those with missing or non-functioning spleens;
• All cancer patients;
• Patients with any condition that can compromise respiratory function, e.g. spinal cord injury, seizure disorder or other neuromuscular disorder;
• Persons with Down syndrome;
• Those with morbid obesity, i.e. body mass index over 40;
• all pregnant women (vaccine can be given at any stage of pregnancy);
• Healthcare workers;
• Household contacts of atrisk persons;
• Out-of-home care givers to at-risk persons
• Residents of nursing homes and other long-stay institutions;
• carers; and
• People with regular contact with pigs, poultry or water fowl.






What are the most common types of pain that people present to the pharmacy with?
• Headache (tension, sinus, migraine)
• Muscle pain
• Joint pain
• Anti-inflammatory effect may take more than one dose but analgesic effect is immediate
• For children from 3months
• Variance between licensed OTC dose and prescription doses
• Caution not to take with other NSAIDs
intervention such as surgery or side-effects of medication. Community pharmacies are most often the first destination for pain relief. Pharmacists and friendly trained pharmacy colleagues take the time to engage with patients one -on-one to offer some practical tips and recommend suitable products to meet their needs. A simple WWHAM interview is the starting point for all clinical consultations in the pharmacy.
• Back pain
• Dental pain
• Sports injuries
• Ear pain
• Soft tissue injuries (bruises, strains, tendonitis, bursitis, sprains)
The three OTC oral analgesics
• Refer to pharmacist for patients on anticoagulants (blood thinners)
• Refer to pharmacist for patients with a history of gastrointestinal symptoms
Some other ingredients seen in combination analgesic products
Caffeine
What is PAIN?
• Pain is exactly what the patient says it is!
• Feeling triggered in the nervous system
• Sharp or dull
• Come and go, or it may be constant
• Feel pain in one area of the body – back, head, stomach etc.
• Feel pain all over, such as when your muscles ache from the flu.
• Way of body protecting itself –prevent serious injury by forcing patient to stop or alert patient to presence of underlying medical
• Acute Pain – goes away after treatment
• Chronic pain- can last for weeks, months even years
Pain is a natural part of life, affecting us all at different times throughout or lives. It can be recurrent pain that we experience regularly and are familiar with (such as back pain and joint pain). It can be pain that is caused by injury (sports injury or a fall). It can be pain with no obvious cause or it can pain resulting from a medical
A concise yet conversational WWHAM interview will allow the pharmacy colleague to recommend an appropriate product. The WWHAM interview will also capture information about symptoms that may be of concern. Such symptoms may require referral to the patient’s doctor or in more serious cases, the local emergency department.
When pharmacy colleagues should refer to the pharmacist before recommending a product:
• Request for a codeine containing OTC medicine
• Patient taking other medicines
• Recurrent headache
• Tried another OTC medicine, no improvement
• a baby or young child
• Suspected misuse of product

• Patient is pregnant
• Patient is breastfeeding
• Eye pain
• Ear pain
• Dental pain
• Elderly
• Severe debilitating pain
• Pain after trauma or head injury
• Pain post hospitalisation or surgery
• Pain associated with other acute symptoms
There are three oral analgesics available over the counter. They are available in products as the sole active ingredient or in combination with other active ingredients.
Aspirin
• Analgesic
• Antipyretic (reduces a fever)
• Anti-inflammatory
• Contra-indicated in under 16s
• Refer to pharmacist for patients on anticoagulants (blood thinners)
• Refer to pharmacist for patients with a history of gastrointestinal symptoms
Paracetamol
• Analgesic
• Antipyretic
• First line agent for pain and fever in children over 2 months
• Not an anti-inflammatory
• Caution not to take other products that contain paracetamol. Always read the label!
• Licensed for use in pregnancy when required
Ibuprofen
• Analgesic
• Antipyretic
• Anti-inflammatory. Ibuprofen is a Non Steroidal Anti-Inflammatory Drug (NSAID).
• Stimulant – lifts mood, increases alertness
• May increase the rate of absorption of the analgesic
Buclizine
• Helps reduce nausea and vomiting
• Found in Migraleve® pink tablets
Diphenhydramine
• Drowsy antihistamine
• Useful where nighttime pain prevents sleep
• Found in Panadol Night®
Topical NSAIDs
Topical non-steroidal antiinflammatories (NSAIDs) are creams, gels, rubs, solutions or sprays that contain a nonsteroidal anti-inflammatory agent and are designed to be applied directly to the skin overlying a painful joint or area of bone. OTC topical NSAIDs contain the active ingredient diclofenac or ibuprofen.
• Absorbed through the skin
• Painkilling, anti-inflammatory action
• Fewer side-effects than when taken by mouth
Ibuprofen: Nurofen 5% Gel
Diclofenac (available in 1% and 2%): Voltarol Emulgel®, Diclac®
Category trends and growth
Moving Annual Total (MAT) is a








































tool used to analyse and compare sales over a period of time. The MAT (sourced from IQVIA)for the OTC pain relief category in Ireland for March 2023 (March 2022 to February 2023) compared to the MAT for March 2022 (March 2021 to February 2022) reveals growth of a massive 36%! However, this figure is misleading as the period from March 2021 to February 2022 was a time when pharmacy footfall was much lower and people were far less active due to the COVID-19 pandemic and associated public health advice.
The current year to date (YTD) trends show far less growth. There is 2% growth in terms of value on overall pain OTC products. The growth as per active ingredients is as per the below table:
Codeine +3%
Ibuprofen +2%
Paracetamol +1%
This level of growth however has been driven primarily by price inflation. Some other trends of note from the data suggests:
• Paracetamol unit sales have dropped post the peaks seen during the COVID-19 waves.
• Topical pain relief sales are showing steady growth (+ 4%)
• Out of stocks and are skewing figures, however it clear to see that generics market share is growing. Eg. Core Nurofen -22%/ Brupro +22%
• One thing that remains constant is the continued demise of Aspirin as an OTC pain relief medicine. Paracetamol and ibuprofen are the two pillars upon which the OTC pain market is built.

Whilst there hasn’t been the introduction of a new molecule to the OTC pain market, in recent years there has been some innovation with formulations and combination products. Examples include:
• Nurofen Durance 200mg Medicated Plaster
• Nurofen Long Lasting 300mg prolonged-release tablets/ capsules
• Easolief Duo 500mg/150mg tablets (paracetamol/ibuprofen combination product)
It is essential that all colleagues working in the pharmacy are trained to comply with the PSI’s Guidance for Pharmacists on the safe Supply to Patients of NonPrescription Medicines containing Codeine. The superintendent and supervising pharmacist are responsible for ensuring that the pharmacy has a standard operating procedure (SOP) in place to ensure that the guidance is complied with. Key points from the guidance include:
• The supply of codeine medicines may only be made by or under the personal supervision of a pharmacist who would be in a position to determine the appropriateness of the request.
• Such medicines must not be available for self-selection and must not be visible to the public.
• Every time a codeine medicine is supplied, the pharmacist must be satisfied that in the exercise of his or her professional judgement, the supply of such a medicine is the most appropriate treatment available at the time and that such supply is in the best interest of the patient. It should also be taken into account that non-codeine
containing medicinal products for the same indications should be considered as first-line treatments, e.g. ibuprofen, paracetamol or aspirin
• The pharmacist has an important role to discharge the correct management of pain. This includes providing appropriate advice or medication and recognising the need for referral for further medical investigation.

• Codeine medicines should only be taken when the pharmacist considers it necessary and for the shortest period considered necessary. Combination products with ibuprofen and paracetamol recommend that the duration of treatment should be for no longer than three days. Any requirement for more prolonged use should only be considered under medical supervision.
• Patients should be advised of the importance of adhering to the recommended dosage and duration of use. Patients should be informed that chronic use and consumption of quantities in excess of the recommended dose, or for a prolonged period of time, may lead to tolerance, psychological and physical dependence and may result in the development of symptoms such as restlessness and irritability upon cessation of this medicine.
• The risks associated with overdose and/or prolonged use should be addressed with the patient.
• For products which also contain paracetamol or ibuprofen, the patient should be informed that these medicines have the potential to be harmful in overdose quantities or if used for a prolonged period of time.
• If patients experience the need to use codeine medicines over a prolonged period of time (i.e. more than three days) for pain relief or relief of another symptom, the patient should be referred to a medical practitioner who would be able to review their symptoms and provide appropriate treatment under medical supervision.
• Patients should also be counselled in the course of each supply in respect of other potential adverse reactions or side effects, including nausea, constipation, dizziness and drowsiness (which may impair their ability to drive safely). They should also be counselled, as appropriate, regarding the contraindications for use, drug interactions, or existing medical conditions, which may preclude the use of these medicines. The need for safe storage of these medicines should also be addressed with patients.




Call for papers: make your contribution to Irish Pharmacy News







Articles



Research Papers
Reviews
Programme Descriptions
Reports
Case Reports

Letters to editor
In-depth review articles critique fundamental concepts, issues, and problems that define a field of research or practice and support advanced practitioners as well as aspiring early-year pharmacists.
Practice reports share innovations on any area of practice, including delivering clinical services, pharmacy administration, or new approaches to inform and engage with patients with the aim to improving pharmacy practice.
Perspective articles focus on a specific field or discipline and discuss current advances or future directions, and may include original data as well as expert insight and opinions.
Contact: Kelly Jo Eastwood at: kelly-jo@ipn.ie or Aoife Jackson at: aoife@ipn.ie

Cough is a natural defence reflex which is important in airway clearance. Cough is the most common presentation in primary care and it can cause numerous complications including insomnia, urinary incontinence, ruptured blood vessels, fractured rib and vomiting.
Cough can be acute (duration of less than 3 weeks), subacute (duration of 3–8 weeks) or chronic (duration of greater than 8 weeks). Acute cough is usually caused by upper respiratory tract viral infections, subacute cough is often the residual cough after an infection has resolved and chronic cough can be due to a variety of medical conditions. These medical conditions can include upper airway cough syndrome, gastroesophageal reflux induced cough, cough-variant asthma and non-asthmatic eosinophilic bronchitis. Diagnosing is often through taking medical history, examining clinical symptoms, observing response to treatment, physical examination or diagnostic tests. Various treatment options are possible, depending on the nature of the cough and the underlying aetiology.
Expectorants, demulcents, antihistamines and non-opioid antitussives can be effective in treating cough, depending on the aetiology. Opioid antitussives are no longer recommended in treating cough. Prescription options such as corticosteroids, bronchodilators and leukotriene receptor antagonists are also possible treatment options available on prescription. Pharmacists can be involved in triaging patients, taking a thorough medical history, referring patients with warning signs and counselling patients on their treatment.
AUTHOR: Written by Damien O’Brien, Pharmacist, Adrian Dunne Pharmacy Baldoyle
1. REFLECT - Before reading this module, consider the following: Will this clinical area be relevant to my practice?
2. IDENTIFY - If the answer is no, I may still be interested in the area but the article may not contribute towards my continuing professional development (CPD). If the answer is yes, I should identify any knowledge gaps in the clinical area.
3. PLAN - If I have identified a

knowledge gap - will this article satisfy those needs - or will more reading be required?
4. EVALUATE - Did this article meet my learning needs - and how has my practise changed as a result? Have I identified further learning needs?
5. WHAT NEXT - At this time you may like to record your learning for future use or assessment. Follow the

4 previous steps, log and record your findings.
Published by IPN. Copies can be downloaded from www.irishpharmacytraining.ie
Disclaimer: All material published is copyright, no part of this can be used in any other publication without permission of the publishers and author. broncho has no editorial oversight of the CPD programmes included in these modules.
Cough is a natural defence reflex that involves the sudden expulsion of air from the breathing passage. Coughing is vital in preventing aspiration and is important in airway clearance of foreign particles, fluid, microbes and irritants. Although, cough is a vital protective mechanism, excessive and chronic coughing can be disabling for patients and reduce quality of life.1 Cough is a common presentation in primary care and is the leading cause of outpatient visits, more than any other symptom.2 In most cases, cough is relatively benign but the prognosis relies on the underlying aetiology of the cough.3
Cough can be classified on the basis of duration of the symptom. Acute cough is defined as cough lasting for less than 3 weeks, subacute cough lasts 3–8 weeks and chronic cough has a duration of greater than 8 weeks. Acute cough is often as a result of an upper respiratory tract viral infection such as influenza, the common cold or covid-19. Subacute cough is often the residual cough that remains after an infection has resolved. Chronic cough can be as a result
of a wide variety of medical conditions. Chronic cough can be further categorised into two different subtypes: (i) presence of pulmonary lesions on radiography and (ii) lack of identifiable abnormalities on radiography. Cough can also be classified as non-productive, also known as a dry cough, or productive, also known as a wet cough. A nonproductive cough will produce a sputum volume of less than 10 ml per day, while a productive cough will produce a volume of more than 10 ml per day.4
There are a number of complications associated with chronic cough. Patient groups such as infants, the elderly, smokers, immunocompromised patients or patients with comorbidities are also susceptible to complications with chronic cough. Insomnia is often associated with nocturnal cough. Patients can also have issues with urinary incontinence as the coughing action increases pressure within the abdomen, which can cause loss of bladder control. Other potential complications include ruptured blood vessels, headache, vomiting, fractured rib and hoarseness.3
The underlying cause of cough can be difficult to ascertain. There are a wide variety of causes of cough and it is important to determine the cause to ensure the correct treatment option is selected. Aetiology can depend if the cough is acute, subacute or chronic.
A patient’s medical history alongside a physical examination and specific diagnostic tests may need to be performed to exclude severe illnesses. These illnesses include myocardial infarction, heart failure, pulmonary embolism or pneumothorax as the cause of the acute cough. The most common cause of acute cough is upper respiratory tract viral infections.4
The common cold is a viral respiratory infection that can be caused by a variety of viruses including coronaviruses, adenoviruses, rhinoviruses, influenza and parainfluenza viruses. Other symptoms of the common cold include headache, runny nose and sore throat. In the majority of cases, the common cold is self-limiting and resolves within two weeks.5

Influenza is another common respiratory virus that has cough as one of the main symptoms. Symptoms of influenza usually present suddenly and other symptoms include high fever, fatigue, muscle pains and headache. Symptoms are usually more severe than the common cold but are usually self-limiting and resolve within two weeks.6 Vaccination is the most effective way to protect against influenza.7
Covid-19
Covid-19 has been another common cause of cough in recent years, with a non-productive cough commonly reported as an initial symptom. Acute Covid19-associated cough with other symptoms such fever, loss of taste and loss of smell is common (60–70% of symptomatic patients). Chronic cough after Covid-19 infection is less frequent but can be observed in post-Covid syndrome, where it is usually associated with symptoms including chronic fatigue, chronic pain, and cognitive impairment.8
Subacute cough is most commonly a post-infectious cough (PIC). After the acute stages of the viral infection in the upper respiratory tract, there can be inflammation still present in the airways, which can lead to a persistent cough. The chest radiograph findings are generally normal and the cough usually resolves within 8 weeks. If symptoms continue to persist,
it can be a sign of a chronic cough with potentially a different aetiology. A bronchoprovocation test or further investigations may be necessary.9

Infection is not related to the majority of patients with chronic cough and it can be due to a variety of medical conditions.4

UACS is also known as postnasal drip and occurs when secretions from the nose drip down the back of the throat. These secretions can irritate the throat and trigger a cough, as well as other symptoms including blocked nose, runny nose, sneezing and a frequent need to clear the throat. The main cause of UACS is most commonly seasonal allergic rhinitis but can also be due to rhinosinusitis and laryngopharyngitis. Some patients may have silent UACS, which occurs when patients become tolerant of other symptoms and only the cough persists.4, 10, 11
GERC is one of the main causes of chronic cough and is a subtype of gastroesophageal reflux disease, that presents with chronic cough as the predominant symptom. Some patients with GERC may have no other symptoms, while some may have classical reflux symptoms. The cough will generally occur after meals, particularly after ingesting acidic or fatty foods,
and is usually non-productive or accompanied by a small amount of mucus. The pathogenesis of GERC is due to reflux triggering the cough by direct effect of acid on the proximal part of the oesophagus or by indirect vagal stimulation of the reflux on distal parts of the oesophagus.12
CVA is an atypical form of asthma and one of the most common causes of chronic cough. Other symptoms of asthma including dyspnea and wheezing are not observed, with cough as the predominant or sole symptom. The cough is generally severe, non-productive and occurs particularly at night or early morning. It is often triggered by dust, smoke, cold air, odours or other irritants. Approximately 30-40% of patients with CVA will develop typical asthma.4
Drug-induced cough is another potential cause of chronic cough. Drug withdrawal is the best method of relieving drug-induced cough, therefore it can reduce complications of cough and use of additional drugs. Angiotensinconverting enzyme inhibitors (ACEIs) are the most common drugs that have a cough as an adverse reaction. The incidence of ACEI associated cough is estimated at up to 10%, with a higher incidence among elderly patients. Angiotensin receptor blockers (ARBs) can be used as an alternative therapy for patients with intolerance to ACEIs. The
incidence of ARB-associated cough is significantly lower than the incidence of ACEI-associated cough and obtains similar antihypertensive effects. Cough is a potential adverse effect of opioids, with an incidence of opioid-induced cough estimated between 28–66%. Other drugs such as statins, omeprazole, pantoprazole, leflunomide and sitagliptin have cough as a rare adverse reaction. Pharmacists are ideally placed to assess a patient’s medication history to see if any medications were initiated recently and discuss with a physician about potentially changing drug therapy if necessary.12
Non-Asthmatic Eosinophilic Bronchitis (NAEB)
NAEB is another potential cause of chronic cough. NAEB has characteristics of chronic eosinophilic inflammation of the airway and inflammation of the central airway. It is similar to CVA but the degree of inflammation and level of oxidative stress are lower in patients with NAEB. Patients with NAEB often have concurrent allergic rhinitis.4
Chronic bronchitis is a condition where the airways are irritated causing coughing, sometimes with associated mucus. Chronic bronchitis may be diagnosed when a patient has a history of chronic productive cough lasting for longer than 3 months of the year, for at least 2 consecutive years and when other diagnoses have been ruled out. Patients with chronic bronchitis are often current or past smokers. Other factors can include second-hand exposure to smoke or environmental exposure to toxins.4
The exact aetiology of psychogenic cough (habitual cough) is unknown, however, it is caused by psychological conditions and is more common in children than adults. It often only occurs during the day, with the cough disappearing when concentrating and sleeping. Other less common causes of chronic cough include lung cancer, chronic heart failure and rheumatoid arthritis.4
A thorough medical history is the first step in the diagnosis of cough. Physical examination, and diagnostic tests can be used to exclude severe disease as the
cause of acute cough. Most acute coughs are caused by upper respiratory tract viral infections. Diagnosis can be made based on medical history and clinical symptoms in most cases, but viral culture or polymerase chain reaction (PCR) lab techniques can be used if necessary. Cough caused by allergic reactions can be observed for response to treatment or allergen testing can also be carried out if necessary.3 A chronic cough is much more difficult to diagnose and typically requires referral to a pulmonologist. Conditions such as UACS are generally based on medical history, observing treatment response and physical examination if necessary. CVA is similar but a bronchial provocation test can be carried out and response to asthmatic treatment observed. In the case of NAEB, a sputum eosinophil count greater than 2.5% is required for diagnosis. Chest radiography can be carried out to check for abnormalities, with CT scans and pulmonary ventilation function also possible options.4
Pharmacists are often a patient’s first port of call when they initially develop symptoms. Pharmacists can be involved in screening for warning signs that may require immediate referral to another healthcare professional. Pharmacists are accessible healthcare experts and can be involved in a more systematic approach to arriving at a diagnosis and ensuring the patient receives the right treatment and guidance. If it is a regular patient, pharmacists can check the patient medication record to see if any recently initiated medications are causing a drug-induced cough. Pharmacists can also provide advice and thorough counselling about the use of over the counter (OTC) treatment options.
Pharmacists are excellently placed to carry out a full and detailed medical history of the patient. Information that should be collected by the pharmacist includes duration of cough, smoking status, aggravating or relieving factors, use of other medication and occupation. The pharmacist should also get full information on symptoms including if the cough is productive or non-productive, colour and
consistency of sputum, as well as any other associated symptoms A systemic approach should be used to identify comorbidities, which may be the origin or compounding factor of a cough. Pharmacists can encourage and be involved in helping patients keep a diary of symptoms and triggers of the cough, which can include smoking, air pollution, dust, allergies, acid reflux and medications.13
Smoking is one of the main causes of chronic cough and production of sputum is much higher in smokers than non-smokers.14 Pharmacists are well-placed to make interventions to help patients with smoking cessation. Motivational interviewing is one tool that can be useful in helping people to stop smoking, which involves counselling that has the objective of helping people explore reasons that they want to quit smoking. This helps people gain confidence in their ability to change behaviours. A pharmacist can use this technique to encourage people to change behaviours, which can lead to improvement in their cough, among other health benefits.15
There are a number of OTC treatment options available in Ireland for the treatment of cough, depending on the nature of the cough or the underlying aetiology.
Expectorants and mucolytics are commonly used to treat productive cough. They exert their effect by increasing the volume of sputum in the airway and decreasing its viscosity, therefore promoting effective coughing and clearance of mucus.17 Clinical studies have shown the efficacy of expectorants in both acute upper respiratory tract infections and in chronic respiratory conditions, where excess mucus and cough are symptoms.18 Guaifenesin and Carbocisteine are the two most commonly used expectorants that are available OTC to treat respiratory tract disorders characterised by excessive mucus. Guaifenesin is licensed for OTC use in children over the age of 6 years and Carbocisteine can be used from 2 years old.19,20 Bromhexine is available on prescription (S1B) as a mucolytic to treat viscous mucous secretions in patients over 2 years old.21
Supply of codeine products must be under the personal supervision of a registered pharmacist due to the risk of tolerance, dependence and other potential adverse effects.23 Codeine was considered the gold standard in the treatment. However, recent controlled studies have demonstrated that codeine is not more effective than placebo in suppressing cough caused by upper respiratory disorders. Codeine does not have a favourable adverse effect profile with potential for dependence, drowsiness, nausea, constipation and respiratory depression. Therefore, the use of codeine in treating cough is no longer recommended.24
Warning signs
When pharmacists are involved in the triage of patients upon initial presentation with symptoms, they can play a vital role in identifying warning signs of cough (as outlined in the table below) and referring when appropriate.16
Codeine is available OTC in Ireland as an antitussive for an unproductive cough, although use is contraindicated in children below the age of 12 years.22

When pharmacists are involved in the triage of patients upon initial presentation with symptoms, they can play a vital role in identifying warning signs of cough (as outlined in the table below) and referring when appropriate (16).
Warning Symptoms
Shortness of breath.
Chest pains.
Cough lasting 3 weeks or more.
Pain on inspiration.


Wheezing.
Excessive sputum production.
Haemoptysis.
Systemic symptoms including fever, night sweats and unexplained weight loss.
Weakened immune system due to diabetes or chemotherapy.
Difficulty swallowing when eating or drinking.
Suspected adverse drug reaction.
Change in the nature of the smoker’s cough. Swollen glands.
Treatment
There are a number of OTC depending on the nature of the cough or the underlying aetiology.
Expectorants and Mucolytics
5 1
Non-opioid antitussives are preferred in the treatment of cough. Dextromethorphan is the most commonly used drug in this class. It lacks the inhibitory effect on the respiratory centre compared to codeine, as well as the analgesic and sedative effects. The most common side effects include nausea, drowsiness and dizziness. Dextromethorphan is well tolerated and has a wide therapeutic window, making it an amenable drug for clinical use. It should not be co-administered with selective serotonin reuptake inhibitors (SSRIs) and monoamine oxidase inhibitors (MAOIs), due to the risk of serotonin syndrome.25 According to studies, a single dose of dextromethorphan hydrobromide has a clear antitussive effect on cough.26 Dextromethorphan is licensed for OTC use in those over 12 years of age for the relief of non-productive and irritating cough.27
Antihistamines are often used in the treatment of cough. Diphenhydramine is a firstgeneration H1-antihistamine that has been demonstrated to have efficacy in treating cough. It is particularly useful for acute cough caused by the common cold and chronic cough caused by UACS, in particular in combination with a decongestant such as pseudoephedrine. Second generation antihistamine including cetirizine, loratadine and fexofenadine can also be effective in treating UACS.28, 29 Side effects associated with diphenhydramine include drowsiness, dry mouth and blurred vision. A cough syrup containing diphenhydramine is licensed for OTC use in Ireland to treat symptoms of non-productive cough in patients aged 6 years or older.30
Expectorants and mucolytics are commonly used to treat productive cough. They exert their effect by increasing the volume of sputum in the airway and decreasing its viscosity, therefore promoting effective coughing and clearance of mucus (17). Clinical studies have shown the efficacy of expectorants in both acute chronic respiratory conditions
Adults and adolescents from 12 years of age:
Demulcents, such as honey, glycerin and syrup, are used to provide a soothing protective layer over the mucous membrane and to provide some relief from pain and inflammation. One drawback associated with demulcents is that they generally only provide very short-term relief from symptoms.31 Honey has been shown to relieve symptoms of cough and to reduce duration of cough when compared to placebo.32 As well as having a demulcent effect, honey has antimicrobial properties, which may explain its effectiveness in treating acute cough. Furthermore, honey is relatively low cost and has an excellent safety profile.32 Honey may also be used for younger patients instead of some other treatment options. Honey can be used from 1 year old, however, it should not be used in infants younger than this due to the risk of infantile botulism.33
Corticosteroids, either oral or inhaled, are effective in treating UACS and CVA. The therapeutic principles for CVA are similar to those for asthma. A combination of budesonide or fluticasone with formoterol (β2 receptor
agonist) for 8 weeks can greatly reduce chronic cough. A shortterm oral corticosteroid course (10-20 mg per day for 3-5 days) is recommended for patients not responsive to inhaled corticosteroid therapy, or in patients suffering from severe inflammation of the airway. Oral corticosteroids use does not have a favourable side effect profile and can cause nausea, weight gain, fluid retention, mood swings and adrenal insufficiency. Meanwhile, the main side effects of inhaled corticosteroids include oral thrush and hoarseness. Intranasal corticosteroids including budesonide and fluticasone propionate can be used to effectively treat allergic rhinitis that has caused UACS. Intranasal corticosteroids have a much better side effect profile than oral corticosteroids, however, rare side effects may include nose bleeds or throat irritation. Leukotriene receptor antagonists can be used as add-on therapy in UACS and CVA and are effective in improving cough, airway inflammation and quality of life.4

Most acute coughs are caused by viral infections and antibiotics will not be an effective treatment. In the case of bacterial infection, broad spectrum oral antibiotics such as β-lactams and quinolones
can be used prior to obtaining the culture results before specific antibiotics are chosen based on sensitivity results.4 Oseltamivir can be used to treat symptoms of influenza and has shown efficacy when treatment is initiated within two days of symptom onset.34 Paxlovid is indicated for treatment of acute covid-19 if the patient is at risk of progressing to severe covid-19 but does not require supplemental oxygen.35


Herbal medicines are popular in the treatment of minor medical conditions, including coughs. Herbal medicinal products on the Irish market must be either authorised or registered with the HPRA. Effective regulation of herbal medicines is considered necessary in order to ensure that safe products of appropriate quality continue to be available in pharmacies and other outlets. Some complementary and alternative medicines including eucalyptus, marshmallow, liquorice and thyme are commonly used in treatment of cough. These products can also interact with other medications, which should be taken into consideration.36 It is always important to check with the pharmacist if traditional herbal remedy products for coughs or other illnesses are suitable, and if
there are any contraindications or possible interactions with its use for the individual person.
Some other non-pharmacological therapy options are also available for cough. Patients should be counselled to ensure they drink plenty of fluids and get sufficient sleep. Steam inhalation and drinking warm fluids can help to loosen mucus. Dairy products should be avoided as they can increase viscosity of mucus and alcohol should be avoided as it can impair the immune system.16
Non-pharmacological treatment options also include breathing techniques and cough suppression, but these would require referral to a physiotherapist or a speech and language therapist.
Lifestyle modifications such as weight loss, smoking cessation, avoiding acidic food, limiting coffee and alcohol can be effective in the treatment of GERC. Proton pump inhibitor (PPI) treatment can be initiated to determine if the cough resolves or significantly improves. Prokinetic agents such as domperidone can also have a positive effect on GERC.4
References available on request

As pharmacists have now become the first port of call for many patients, it is necessary to have basic knowledge of common eye disorders and their appropriate interventions and treatment.
Recent data analysis for IQVIA have placed eyecare into the Top 5 Minor OTC classes by value accounting for 29% of the total. In that period there has been a 9% growth.
Dry eye disease is increasing in prevalence with GPs reporting a 65% increase in the past decade alone potentially relating to the use of modern technology. The impact of COVID 19 with increased screen usage and stress has had a significant effect on dry eye disease with 72% of patients advising that it had a negative effect on their lives.
From recent data across all dry eye treatment categories there has been an increase of greater than 17% from the previous year. This clearly demonstrates that pharmacists’ intervention in this area is critical as over a third of patients will attend the pharmacy seeking support and advice on how to help with their symptoms.
It is important that patients are advised on the proper use of ophthalmic drops so that the medication is applied correctly. Leaflets that instruct patients on how to instil eye drops should be made readily available and should be used to reinforce the explanation.
There has also been an increase in recent years in the number of eye care supplements available over the counter in pharmacies. By far the most common OTC eye supplements are those used to prevent and slow the progression of Age-related Macular Degeneration (AMD).
Dry eye syndrome is due to decreased production of tears or excessive tear evaporation and causes discomfort and soreness. Patients may also complain about a sensation of feeling grit in their eye. Underlying causes of dry eye include Sjögren’s syndrome, aging, staring at a screen for too long, blinking problems, and environmental factors.
Written by Denis O’Driscoll, Superintendent Pharmacist, LloydsPharmacy
Additionally, patients taking such medications as oral contraceptives, antihistamines, and beta-blockers may experience dry eyes.
Dry eye syndrome can be managed using non-prescription artificial tear products. Many OTC products are available, and preservative-free formulations are recommended if the patient experiences itching and irritation with the drops. Dryness can also be prevented by the use of humidifiers.
Age-related Macular Degeneration (AMD)
AMD is a leading cause of vision loss. It’s mainly associated with aging, but some forms of macular degeneration affect younger people as well.
AMD occurs when there’s deterioration of light-sensitive cells in the macula area of the retina. This is the part of the eye responsible for:
• recording what we see and sending the information to our brains
• seeing fine detail
• focusing
Other Common eye conditions presented in community pharmacy
• Red Eye
• Allergic Conjunctivitis
• Bacterial Conjunctivitis
• Subconjunctival Haemorrhage
• Blepharitis
• Floaters
• Styes
• Watery Eyes
• Foreign Body in the Eye
• Meibomian Cysts (Chalazia)
Questions to ask during an eyecare consultation in the pharmacy (Elton M. Ocular conditions from A to Z (ii). Pharm J. 2007;278:255-258):
• How long have you had this problem?
• Have you had this problem before?
• What is the pattern of occurrence of this problem?
• Has it gotten worse or better over time?
• Is there any pain?
• Is there any discharge?
• Is your vision affected?
• Do you know what the problem could be? Is there an obvious cause?
• Have you been using a computer screen for prolonged periods of time?
Symptoms that require immediate referral (Elton M. Ocular conditions from A to Z (ii). Pharm J. 2007;278:255-258):
• Pain in the eyes
• Blurred or distorted vision
• Worsening symptoms
• Any doubt about the diagnosis
• No improvement with any OTC medications previously used. What vitamins and nutrients may help Eye Health?
Lutein and zeaxanthin
Lutein and Zeaxanthin are carotenoids. Carotenoids are pigments found in plants and in your retina. Supplementing these pigments helps increase their density in your retina. They also absorb high-energy blue and ultraviolet light that can damage your eyes. Dark green leafy vegetables are the primary source of lutein and zeaxanthin, as well as other colourful fruits and vegetables like broccoli, corn, peas, persimmons and tangerines.
Photoreceptors cells in the retina contain a large quantity of omega-3 fatty acid. It’s believed that docosahexaenoic acid (DHA), a type of omega-3 fatty acid, helps in the development of retinal cells. It’s also thought to have a role in reducing inflammation and helping cells of the retina and the cornea heal and regenerate after damage due to light exposure and aging.







































Salmon, tuna and other coldwater fish are the best sources of omega-3 fatty acids and can help reduce inflammation, enhance tear production and support the eye’s oily outer layer.
Zinc
Also found naturally in your eyes, zinc is a powerful antioxidant that protects against cell damage.
Vitamin B1 is essential for the health of your eyes. Known as one of the “anti-stress” B vitamins, vitamin B1 reduces inflammation.
Vitamin C
Vitamin C may lower the risk of developing cataracts and when taken in combination with other essential nutrients, it can slow the progression of age-related macular degeneration and visual acuity loss. For your daily dose, try incorporating oranges, grapefruit, strawberries, papaya, green peppers, and tomatoes into your diet.
Some practical tips to promote eye health
• Avoid environments with dusty or dirty air.
• Use cold compresses, cucumbers, or dampened and cooled green or black tea bags on your eyes.
• Do not smoke. Smoking damages blood vessels in the eyes and can lead to cataracts, macular degeneration, and other sight problems.

• Protect your eyes from ultraviolet light. Wear sunglasses when you’re outdoors and avoid staring directly into bright lights.
• Maintain a healthy weight and an active lifestyle.
Zinc plays a vital role in bringing vitamin A from the liver to the retina in order to produce melanin, a protective pigment in the eyes. Impaired vision, such as poor night vision and cloudy cataracts, has been linked to zinc deficiency. For natural dietary sources of zinc, try red meat, oysters and other shellfish, and nuts and seeds.
• Drink plenty of water.
• Keep your eyes moist with artificial tears. There are a wide range of lubricants for the eyes available in community pharmacies.
• If you live or work in a building with air conditioning, the filter should be changed as required.
• After age 60, get a dilated eye exam each year.
• Make sure your diet contains plenty of green leafy vegetables, spinach, corn, oranges, eggs, yellow carrots. These foods contain high levels of nutrients, including those found in the AREDS2 formulation.
The HSE Diabetic RetinaScreen programme has launched a new screening initiative for women who have diabetes and become pregnant. The risk of diabetic retinopathy may increase during pregnancy and this new initiative will provide more frequent screening to women, protecting their sight during pregnancy. Part of the National Screening Service (NSS), the HSE Diabetic RetinaScreen programme is encouraging women with diabetes to take up their invitation of this free screening during their pregnancy.
Diabetic Retinopathy is a complication of Type 1 and Type 2 diabetes that affects the small blood vessels at the back of the eye, in an area called the retina. It can cause the blood vessels in the retina to leak or become blocked and damage a person’s sight. However, when retinopathy is caught early, treatment is effective at reducing or preventing damage to the sight.
Speaking at its launch at the Diabetic Retinopathy Treatment (DRT) Service in the Mater Misericordiae University Hospital in Dublin, Minister for Health Stephen Donnelly said, “This new initiative provides women with Type 1 or Type 2 diabetes with more frequent

and potentially sight-saving eye screening during their pregnancy, given that the risk of diabetic retinopathy may increase during their pregnancy. It brings together maternity services and screening services in a way that supports a multi-disciplinary approach and provides local, targeted care for this specific group of women during their pregnancy.
“I was delighted to support the pilot phase of this project through a grant from the Women’s Health Fund and I commend all those involved in implementing the national roll-out of this important screening. I would particularly like to thank all those involved in the delivery of maternity services
across the country, for their support of this new initiative.”
Dr David Keegan, Diabetic RetinaScreen Clinical Director, added, “For women with diabetes, the risk of diabetic retinopathy and sight loss may increase during pregnancy. This new initiative, through the Diabetic RetinaScreen programme, will deliver a specific service for women with diabetes who are pregnant. This will improve equality and quality of access to eye care for women at risk of sight loss.”
Helen Kavanagh, Diabetic RetinaScreen Programme Manager said: “The roll out of screening for women during pregnancy shows how population-based screening
can protect people who are more at-risk of eye disease. We piloted the scheme last year to great success and this week, as we announce that it’s now available nationwide, we are asking all women who have diabetes and become pregnant to talk to their maternity care provider about their diabetes, and the availability of eye screening.
“This initiative has been welcomed by all the national maternity units and together we will provide a more systematic approach to eye screening for these women. We also urge friends and family members of anyone with diabetes to stay informed about the benefits and limitations of eye screening.”
The oral market is one that has been growing substantially over the past while with new innovations in products and more consumer awareness and focus on their oral health being at the forefront of contributing factors.
 Written by Fatimah Kara, Supervising Pharmacist, Reidy’s Pharmacy, Rathcoole
Written by Fatimah Kara, Supervising Pharmacist, Reidy’s Pharmacy, Rathcoole

rise of oral health brands have increased demand for them in the pharmacy which gave rise to a focus on updating staff training to better support consumers in making educated choices on the best products for their needs. We have seen a lot of consumers coming with photos or videos of products they have seen online and it has been fantastic to see such a revival especially amongst younger consumers.
rise in the value of the category. Although the costs have increased, the quality too has which has led to increased consumer trust in the category and repeat sales of brands and products.

Consumer behaviour has changed, and we have seen an increase in interest and engagement in the oral health market. The engagement has grown from the once standard care of toothbrush, toothpaste, and some string of floss! We have seen the buying habits of consumer move to more advanced care such as interdental brushing, water flossing and advanced whitening products as recommended from their dentists and social media influences.
Technology changes have shone a light for consumers on the oral market with more access to new products and brands and to developments on oral care and the need to include it as another component to overall health and wellbeing. The emergence and
Shopper trends have changed in the sense that we have seen an increase of more cosmetic based products such as the whitening toothpastes or whitening strips and pens. There has been more engagement from younger consumers as well as those who have an established oral care routine but who are also open and willing to add to their routine.
The value of the category is quite high and has become one of the top categories in the pharmacy. Prices have changed and increased but in a fashion that accurately reflects the advances and changes in the category to match the times. Products such as electric toothbrushes have evolved incredibly with advances which include phone apps to monitor pressure on the teeth to ensure it’s not too hard or damaging. Water flossers are emerging as a great addition to help with a full whole mouth clean and have added a
Innovation in the category has been second to none and should be admired. Brands have invested in developing new products and ways for consumer engagements. There has been emphasis on sustainability and recycling such as natural, bamboo toothbrushes and product extensions such as different heads for water flossers such as targeted flossing and tongue scrapers. Demands have also been seen for gift sets or oral health products and although it seems unlikely, sales for such products were substantially more than expected!
I feel more engagement from dentists in addition to consultations when consumers attend them to help to highlight the category outside of appointments and visits to dentists will greatly help the category. Brands could do more in store promotional events such as holding staff training and perhaps having a stand on the pharmacy floor for one day to engage with consumers who maybe have not thought about incorporating new products or expanding their oral health routine. The risks to the category may be an unwillingness to change an established oral health routine amongst consumers or older consumers unable to use newer products which require smartphone connections to get the full value and advantage of the products.
The consumer, from experience holds the power in the category. From the demand of advances in the category with new products to give the professional, dentists results at home to whether or not to engage with certain products depending on if it fulfils their requirements and needs.
I feel more instore promotional material such as leaflets or QR codes for websites would be very beneficial to help improve revenue in the category. Window displays have and still are very effective in catching the consumers attention and perking up their interest and curiosity in certain products and brands. More interaction and engagements from brands and companies with pharmacies would greatly improve revenue to help with staff training and consumer engagement.
The oral health category, no matter how well established has seen a revamp and increase in utilising social media and online platforms has opened up the category to a whole new demographic which may have not engaged with the category as much before. There has been a huge increase in consumers taking control of their oral health and consider it vital in their wellbeing and it has been fantastic to see. The category may have been neglected for a while but advances from companies in technology and innovative products and to make these more accessible to consumers has been phenomenal and has greatly empowered consumers. In the past few years alone, this category has boomed, and the future is very promising and exciting!

The Digestive Health category, a longstanding pillar of over-the-counter (OTC) offerings within community pharmacies, has traditionally seen a firm dominance by established brands such as Nexium and Gaviscon. However, recent developments in the healthcare sector, coupled with a discernible shift in consumer behaviour, have unveiled a plethora of potential opportunities in this field. This particularly rings true for preventative categories such as probiotics, antidiarrheals, and rehydration products.
Written by Mark McPhillips, Superintendent Pharmacist, Mark’s StayWell Pharmacy, Ardee
within pharmacies. However, it does not negate the need for expert advice. McPhillips goes on to stress the importance of ensuring that pharmacy support staff are well-equipped and welltrained to discuss lifestyle factors that could be impacting a patient’s digestive health.
customers about their symptoms and needs, and shifting our focus towards long-term management and prevention, we can navigate this evolving landscape effectively.
for OTC antidiarrheals such as loperamide has made it essential for pharmacists to maintain well-stocked antidiarrheal sections in their establishments. Equally crucial is the provision of necessary guidance on the correct usage of these products, as well as on potential safety concerns that users should be aware of.
In recent years, the gut microbiome has increasingly captured consumer interest, leading to a parallel surge in the popularity of probiotics. People, especially those grappling with conditions like irritable bowel syndrome (IBS), have begun to play a more active role in managing their health, often turning to preventative measures such as probiotics. As community pharmacists, it becomes imperative to stay at the forefront of the latest developments in this field. This includes keeping abreast of the various probiotic strains available and making informed recommendations on the most suitable formulations to cater to the diverse needs of our patients.
Despite their integral role in providing immediate relief for common conditions like diarrhoea, antidiarrheals often don’t receive the recognition they deserve. A rising demand
Rehydration solutions, once primarily targeted towards athletes, are now resonating with a broader demographic. With use-cases spanning recovery support to hangover relief, these products are increasingly being recognised for their value across a variety of scenarios. Consequently, the demand for rehydration solutions has been on the rise. To cater to this burgeoning market, pharmacists should offer a diverse range of rehydration solutions. They should also be equipped to provide expert advice on the correct usage of these products to ensure optimal results.
The shift we’re witnessing in the Digestive Health category is reflective of a larger trend - the increasing consumer preference for preventive health measures. StayWell Pharmacist, Mark McPhillips, points out that “digestive health shoppers often prefer off-the-shelf remedies.” This consumer behaviour underlines the importance of effective merchandising strategies and strategic product placements
Community pharmacies can enhance digestive health outcomes by widening their service offerings to include programmes like smoking cessation and weight management. These initiatives can significantly contribute to improving overall digestive health. Additionally, reviewing patients’ prescription medicines can help identify if any of the prescribed medications may be contributing to their digestive issues. This way, pharmacists can proactively address potential conflicts and suggest alternatives, where necessary.

Merchandising strategies play a pivotal role in the promotion of the digestive health category. Established brands such as Nexium and Gaviscon should be given prominent visual presence within the OTC section of pharmacies. This helps guide customers towards this category. Moreover, when patients are purchasing medicines to treat symptoms, offering preventive solutions can be beneficial. This not only addresses the underlying issue but also strengthens the relationship between the pharmacy and the patient.
While established brands continue to hold significant market shares, emerging trends in digestive health present exciting opportunities for growth in other categories. By strategically expanding our product offerings, engaging in constructive dialogue with our
Recognising when a patient’s symptoms warrant further medical attention is a critical aspect of our role as pharmacists. If symptoms don’t respond to treatment or if ‘red flags’ such as severe symptoms persisting for more than three weeks, worsening and unexplained abdominal pain, vomiting blood, dark stools, or unexplained fever are present, a referral to a GP or other medical professional should be made immediately.
As the holiday season approaches, a time notorious for overindulgence, the role of community pharmacists becomes even more critical. With GP surgeries and health centres typically closed over the holidays, community pharmacists become the first line of medical advice for those dealing with the discomforts resulting from Christmas excesses. Our preparations for this seasonal peak should include a wellstocked supply of indigestion and heartburn remedies. In addition, we can play a pivotal role in educating our customers about the importance of moderation during the holiday season and offering advice on maintaining digestive health amidst the festivities.
In conclusion, community pharmacists stand at the cusp of a paradigm shift in the Digestive Health category. We can foster a stronger relationship with our customers by identifying and embracing emerging trends, evolving our services to meet changing demands, and providing expert advice. By doing so, we will not only improve health outcomes for our patients but also ensure the future prosperity of our profession.
Food supplement, not to be used as a substitute for a balanced diet. Always read the label. Clonmel Healthcare Ltd. Date prepared: April 2023. 2023/ADV/ELE/128H

electrosal.ie


Stretching from your head to your bottom, the digestive system (made up of the gut, bowel, and stomach) breaks down all that delicious food and drink we consume, absorbing the useful nutrients and energy, whilst getting rid of the waste. It’s a complex system that comes with various health concerns, from simple problems like indigestion to disorders which may be lifelong, such as IBS.
Many of the products in the Digestive Health category offer patients solutions and symptom relief. Generally the most common concerns presenting in pharmacy are constipation, diarrhoea, bloating, heartburn, and irritable bowel syndrome ( IBS).
Lifestyle advice can prevent and alleviate many of the symptoms related to this category. Such as avoiding trans and fatty foods, reducing sugar intake, eating more fibre, drinking water, not smoking, reducing caffeine and alcohol intake, eating regular healthy meals, and staying active. However, this advice is often easier said than done. So throughout our lives, at some stage many of us will need to visit a pharmacy to get something to alleviate digestive discomfort and symptoms.
Patient behaviour is changing in this category. Pharmacists are seeing well informed, welleducated patients who are pro-active about their health and wellness as well as the traditional symptom reactive patient.
There is huge growth in the rehydration category. Post covid, there has been an increase in runners and gym active customers who are proactively rehydrating post workout with Dioralyte,
ORS, Phizz. Oxylent and other rehydration products
Pro biotics are also growing and expanding and appealing to proactive and reactive consumers alike. Pro-biotic ranges are expanding with new products. Alforex and Zenflore have expanded there range to include new and broader products additions. Patients and customers alike are well informed on the benefits of gut health and good bacteria. There is also increasing awareness of the impact of gut health and diet on our mood and an understanding of the research of Professor Ted Dinon in UCC in this area.
Indigestion or dyspepsia refers to pain or discomfort in the upper abdominal area after eating, while heartburn refers to the burning pain felt behind the sternum associated with acid reflux, which is often accompanied by nausea, water brash or regurgitation of acid or bile.
Dyspepsia usually occurs when stomach acid irritates the stomach lining, oesophagus or top part of the bowel, perhaps after a heavy meal, whereas most cases of acid reflux or gastro-oesophageal reflux disease (GORD) occur due to weakening of the lower oesophageal sphincter.
For anyone experiencing the discomfort associated with heartburn and dyspepsia, finding rapid relief is a top priority. Heartburn and dyspepsia are common gastrointestinal (GI) complaints that, if left unresolved, may negatively affect an individual’s overall quality of life and restrict or limit activities or ingestion of certain foods. Heartburn, or pyrosis, is characterised as a burning sensation arising from the substernal area and moving toward the neck or throat. There are 2 main types: postprandial heartburn occurs within 2 hours after a meal, when bending over, or when lying down, and nocturnal heartburn occurs during sleep and often is responsible for interrupting it. Dyspepsia is pain that manifests in the gastroduodenal region. Symptoms may include postprandial fullness, epigastric pain, and burning.
GORD is caused by acid leaking up from the stomach and coming into contact with the oesophagus. While the stomach is able to withstand litres of acid without pain, the gullet is not. GORD has a significant impact on quality of life and productivity, with sufferers reporting impaired sleep and interference with social activities and work.
Incidence of GORD is certainly rising as obesity rates accelerate. People are also binge drinking and eating more fatty or calorific food, which increases acidity levels and contributes to poorer digestive health.
IBS patients are very well educated and understand the balance of lifestyle and self-management of their condition.
Nexium is still the category leader in heartburn, despite generics entering the marketplace. However Gaviscon still is a relevant and strong category leader and is a unique liquid offering in the category.
The role of the pharmacist is key in selling restricted sale products like Motilium appropriately and sales in this product are also growing and the importance of pharmacist advice and counselling is essential.
Pharmacists play a vital role in supporting customers with their digestive health wellness and educating them on the different solutions available in pharmacy, lifestyle options and health advice. Pharmacists have a role empowering patient to self-care and self-manage digestive health symptoms.

VALUE FOR RECURRENT SUFFERERS











Product Information: Please consult the Summary of Product Characteristics for full product information. Nexium Control 20 mg gastro-resistant tablets and hard capsules (esomeprazole). Indications: The short term treatment of reflux symptoms (e.g. heartburn and acid regurgitation) in adults. Dosage: The recommended dose is 20 mg esomeprazole (one tablet or capsule) per day. Tablets or capsules may need to be taken for 2-3 consecutive days to achieve symptom improvement. Maximum treatment duration: up to 2 weeks. Contraindications: Hypersensitivity to the active substance, substituted benzimidazoles or to any of the excipients. Esomeprazole must not be used concomitantly with nelfinavir. Precautions: Refer to doctor if patient has: Jaundice or severe liver disease, unintentional weight loss, recurrent vomiting, dysphagia, haematemesis or melaena and when gastric ulcer is suspected or present, malignancy should be excluded as treatment with esomeprazole may alleviate symptoms and delay diagnosis, gastric ulcer or gastrointestinal surgery, continuous treatment of indigestion or heartburn for 4 or more weeks, or is over 55 years old with new or recently changed symptoms. Not suitable for long term use. Treatment with proton pump inhibitors (PPIs) may lead to a slightly increased risk of gastrointestinal infections such as Salmonella and Campylobacter and in hospitalised patients, also possibly Clostridium difficile. Consult doctor prior to have an endoscopy or urea breath test. Co administration with atazanavir is not recommended. Interactions with medicinal products metabolised through CYP2C19 should be considered. The use of esomeprazole with clopidogrel should be discouraged. Patients should not take another PPI or H2 antagonist concomitantly. PPI are associated with very infrequent cases of SCLE. If lesions occur, especially in sunexposed areas of the skin, and if accompanied by arthralgia, the patient should seek medical help promptly. Side effects: Common: headache, abdominal pain, constipation, diarrhoea, flatulence, nausea/ vomiting, fundic gland polyps (benign). Uncommon: peripheral oedema, insomnia, dizziness, paraesthesia, somnolence, vertigo, dry mouth, increased liver enzymes, dermatitis, pruritus, rash urticaria. For rare, very rare and other side effects please refer to the SPC for full information. Legal category: Supply through pharmacy only. Product licence number: EU/1/13/860/001; EU/1/13/860/002; EU/1/13/860/003; EU/1/13/860/004 and EU/1/13/860/005. MAH: GlaxoSmithKline Dungarvan Limited, Knockbrack, Dungarvan, County Waterford, Ireland. Additional information is available upon request. Text prepared: June 2022. Contains esomeprazole. Always read the label/leaflet. Trade marks are owned by or licensed to the Haleon group of companies. PM-IE-NEX-23-00004
Product Information: Please consult the Summary of Product Characteristics for full product information. Nexium Control 20 mg gastro-resistant tablets and hard capsules (esomeprazole). Indications: The short term treatment of reflux symptoms (e.g. heartburn and acid regurgitation) in adults. Dosage: The recommended dose is 20 mg esomeprazole (one tablet or capsule) per day. Tablets or capsules may need to be taken for 2-3 consecutive days to achieve symptom improvement. Maximum treatment duration: up to 2 weeks. Contraindications: Hypersensitivity to the active substance, substituted benzimidazoles or to any of the excipients. Esomeprazole must not be used concomitantly with nelfinavir. Precautions: Refer to doctor if patient has: Jaundice or severe liver disease, unintentional weight loss, recurrent vomiting, dysphagia, haematemesis or melaena and when gastric ulcer is suspected or present, malignancy should be excluded as treatment with esomeprazole may alleviate symptoms and delay diagnosis, gastric ulcer or gastrointestinal surgery, continuous treatment of indigestion or heartburn for 4 or more weeks, or is over 55 years old with new or recently changed symptoms. Not suitable for long term use. Treatment with proton pump inhibitors (PPIs) may lead to a slightly increased risk of gastrointestinal infections such as Salmonella and Campylobacter and in hospitalised patients, also possibly Clostridium difficile. Consult doctor prior to have an endoscopy or urea breath test. Co administration with atazanavir is not recommended. Interactions with medicinal products metabolised through CYP2C19 should be considered. The use of esomeprazole with clopidogrel should be discouraged. Patients should not take another PPI or H2 antagonist concomitantly. PPI are associated with very infrequent cases of SCLE. If lesions occur, especially in sunexposed areas of the skin, and if accompanied by arthralgia, the patient should seek medical help promptly. Side effects: Common: headache, abdominal pain, constipation, diarrhoea, flatulence, nausea/ vomiting, fundic gland polyps (benign). Uncommon: peripheral oedema, insomnia, dizziness, paraesthesia, somnolence, vertigo, dry mouth, increased liver enzymes, dermatitis, pruritus, rash urticaria. For rare, very rare and other side effects please refer to the SPC for full information. Legal category: Supply through pharmacy only. Product licence number: EU/1/13/860/001; EU/1/13/860/002; EU/1/13/860/003; EU/1/13/860/004 and EU/1/13/860/005. MAH: GlaxoSmithKline Dungarvan Limited, Knockbrack, Dungarvan, County Waterford, Ireland. Additional information is available upon request. Text prepared: June 2022. Contains esomeprazole. Always read the label/leaflet. Trade marks are owned by or licensed to the Haleon group of companies. PM-IE-NEX-23-00004

2023_Nexium_Irish_Pharmacist_FPA 4 PRESS_READY.indd 1
15:52
22/03/2023 15:52
Allergic rhinitis, better known as hay fever, is the most common form of allergic condition and affects around 26% of Irish people.
 Written by Deirdre Butler, Superintendent Pharmacist, Higgins Pharmacy, Market Cross
Written by Deirdre Butler, Superintendent Pharmacist, Higgins Pharmacy, Market Cross

The allergy and hay fever market in Ireland is growing steadily. The prevalence of allergic rhinitis is rising as found in studies such as ISAAC study of 2006, which found an increase of 13 to 19% during an 8-year period in 13-year-olds.
Dr Ranbin Kaulsay, a Consultant in the Beacon Hospital, also referenced in his article ‘Global warming and Hay fever in Ireland’ that a marked increase in temperature has caused high levels of tree pollens to surge and this can cause a phenomenon known as a ‘pollen bomb’ to occur. Any pharmacist can attest to our Summer this year as being particularly difficult for hay fever sufferers. A large number of over the counter consultations are allergy related.
An increase in pollen levels has been noted to cause significant health concerns especially in patients with asthma. The asthma society specify that 80% of asthma sufferers also suffer with allergies and hay fever. This in turn can exacerbate asthmatic symptoms so caution is required.
NICE guidelines suggest that selfmanagement and environmental strategies are key, such as;
allergen avoidance
avoiding drying washing outdoors
keeping windows shut in cars/ buildings
planning holidays to avoid pollen season where possible
showering, wash hair, changing clothes following exposure
wraparound sunglasses
using Vaseline around the nostrils
using saline rinses or sprays to help flush out the allergens
Ectoin a new innovative product which is in the Fusion Allergy range and HyloDual eye drops. This forms a water like shield over the mucous membranes (eye, nose, skin) and helps block the effects of histamine and prevents allergens and irritants from penetration and causing a reaction.
NICE guidelines for medication treatment reflects the market leaders in the pharmacy market. First line treatment for 2 years and over is non-sedating antihistamines e.g., cetirizine, loratadine and telfast (over 12 years). Cetirizine is the market leader due to general effectiveness and cost.

Intranasal antihistamines are more effective than oral antihistamines but a barrier to access is the fact they are prescription only. If they were allowed to be purchased over the counter this could be a significant opportunity for the pharmacy market.
In moderate to severe hay fever an intra nasal corticosteroid is recommended and Flixonase is the market leader. However there have been many shortages this
year where it has been difficult to stock the various over the counter corticosteroid nasal sprays. It is very important to give the correct advice when recommending a corticosteroid nasal spray for example, the correct technique and in some instances, it can take up to two weeks to reach its maximum effect. Failure to do so could result in poor compliance and the medication not working.
In very extreme cases where all techniques and medications have failed, the GP may be able to refer the patient to a specialist.
Dr Ranbin Kaulsay, in his article, speaks about other treatments available such as Intranasal UV phototherapy. This is a new non-interventional and nonpharmacological treatment of rhinitis. This involves using specialised UV lights that are administered into the nostrils for 3 minutes each time for up to 6 to 8 sessions. This is only performed by a trained healthcare professional. This procedure reduces the mucous and allergy cells within the nostrils. Another treatment option is immunotherapy. Success rates have demonstrated 80 to 90% for certain allergens. A considerable body of clinical evidence has established the effectiveness of high dose allergy subcutaneous injections in reducing symptoms and medication requirements.
There are also 2 sublingual immunotherapy treatments for grass pollens available on the GMS and DPS schemes. Oralair (5 grass pollen extract) and Grazax (Timothy grass extract). These treatments are for people with severe grass pollen allergies where standard medications have failed. They can be effective in dampening hay fever for at least 5 years after completion of treatment thus maybe considered to have disease modifying effect.
Pharmacists have an important role in supporting and educating patients. It’s important for each pharmacist or trained colleague to hold a comprehensive consultation with the patient. It’s important to ask them to return to you in 2 to 4 weeks to check their response to treatment.
Identify which symptoms are bothering them, nose, eyes, sinuses, even skin and treat accordingly. Also, open up conversations e.g., if a patient comes in and requests a product by name ask questions such as ‘Is this product sufficient at treating your symptoms? Do you have asthma? If a product hasn’t worked, why? Check compliance, technique, lifestyle factors can all be a cause of treatment failure. These simple steps will help build trust and confidence in you and your team.
References available on request
Cetrine Allergy 10mg Film-Coated Tablets available in packs of 7s and 30s. Always read the leaflet.


ABBREVIATED PRESCRIBING INFORMATION
Product Name: Cetrine Allergy 10mg lm-coated tablets & 1 mg/ml oral solution. Composition(s): Each tablet contains 10 mg cetirizine dihydrochloride. One ml of the oral solution contains 1 mg cetirizine dihydrochloride. Description(s): White, oblong lm-coated tablets, scored on one side. Can be divided into equal halves. Clear, colourless liquid with banana avour.
Indication(s): Tablets: Adults and paediatric patients 6 years and above. Oral solution: Adults and children 2 years and above. Relief of nasal and ocular symptoms of seasonal and perennial allergic rhinitis (hay fever); relief of symptoms of chronic idiopathic urticaria.


Dosage: Tablets: Adults, elderly and children aged 12 years and over: 10 mg once daily. Children from 6 years to 12 years: 5 mg (half a tablet) twice daily. Moderate renal insu ciency (creatinine clearance CrCl 30-49 ml/min): 5 mg once daily. Severe renal insu ciency (creatinine clearance ≤30 ml/min): 5 mg once every 2 days. Children under 6 years: Not recommended. Oral solution: Children aged from 2 to 6 years: 2.5 mg twice daily (2.5 ml oral solution twice daily (half a measuring spoon twice daily)). Children aged from 6 to 12 years: 5 mg twice daily (5 ml oral solution (a full measuring spoon twice daily)). Adults and adolescents over 12 years of age: 10 mg once daily (10 ml oral solution (2 full measuring spoons)). Not recommended in children aged less than 2 years. Moderate renal insu ciency (creatinine clearance CrCl 30-49 ml/min): 5 mg once daily. Severe renal insu ciency (creatinine clearance ≤30 ml/min): 5 mg once every 2 days. In paediatric patients su ering from renal impairment: Adjust dose on an individual basis taking into account the renal clearance of the patient, his age and his body weight. Contraindications: History of hypersensitivity to the active substance, to any of the excipients, piperazine derivatives or hydroxyzine. Severe renal impairment < 10 ml/min creatinine clearance.
Warnings and Precautions for Use: Cetirizine may increase risk of urinary retention, therefore caution in patients with predisposition factors of urinary retention (e.g. spinal cord lesion, prostatic hyperplasia). Caution in epileptic patients and patients at risk of convulsions. Discontinue use of cetirizine three days before allergy testing. Pruritis and/or urticaria may occur when cetirizine is stopped, even if the symptoms were not present before treatment initiation. In some cases, the symptoms may be intense and may require treatment to be restarted. The symptoms should resolve when the treatment is restarted. Tablets contain lactose. Oral solution contains sorbitol, propylene glycol, sodium (essentially ‘sodium free’), methyl - & propyl-parahydroxybenzoate.
Interactions: Caution is advised when taken concomitantly with alcohol or other CNS depressants. Cetirizine does not potentiate the e ect of alcohol (0.5 g/l blood levels). The extent of absorption of cetirizine is not reduced with food, although the rate of absorption is decreased.
Pregnancy and Lactation: Caution during pregnancy and breast-feeding.
Ability to Drive and Use Machinery: Usually non-sedative, patients should take their response to the product into account. In sensitive patients, concurrent use with alcohol or other CNS depressants may cause additional reductions in alertness and impairment of performance.
Undesirable E ects: Cetirizine at the recommended dosage has minor adverse e ects on the CNS, including somnolence, fatigue, dizziness and headache. In some cases, paradoxical CNS stimulation has been reported. Although cetirizine is a selective antagonist of peripheral H1-receptors and is relatively free of anticholinergic activity, isolated cases of micturition di culty, eye accommodation disorders and dry mouth have been reported. Instances of abnormal hepatic function with elevated hepatic enzymes accompanied by elevated bilirubin have been reported which resolves on discontinuation of the drug. Uncommon: Agitation, diarrhoea, pruritus, rash, asthenia, malaise, paraesthesia. See SPC for all adverse reactions.
Marketing Authorisation Holder: Rowex Ltd, Bantry, Co. Cork.
Marketing Authorisation Number: PA0711/075/002-003. Further information and SPC are available from: Rowex Ltd., Bantry, Co. Cork. Freephone: 1800 304 400 Fax: 027 50417
E-mail: rowex@rowa-pharma.ie

Legal Category: Not subject to medical prescription.
Date of Preparation: March 2021
Adverse events should be reported. Reporting forms and information can be found on the HPRA website (www.hpra.ie) or by emailing Rowex pv@rowa-pharma.ie

Professor Judith Strawbridge, School of Pharmacy and Biomolecular Sciences at RCSI University of Medicine and Health Sciences, has been appointed to the Expert Taskforce to Support Expansion of the Role of Pharmacy.
 Professor Judith Strawbridge
Professor Judith Strawbridge
and Director of the Masters of Pharmacy (MPharm) Programme. She is widely recognised nationally for her scholarly expertise and passion for standards in pharmacy education and practice.
Comprehensive approach
The taskforce will initially consider options to enable pharmacists to extend prescriptions for a range of medicines and medical conditions where appropriate.
Minister Donnelly said these initiatives would make it easier and faster for patients to get the medication they need. He said:
Established by Minister for Health Stephen Donnelly, the taskforce will examine how pharmacists in Ireland can be enabled to operate at the top of their licence for the
benefit of patients and the wider health service.
Professor Strawbridge was a founding lecturer on the pharmacy degree programme at RCSI and is currently Deputy Head (Education) of the School of Pharmacy and Biomolecular Sciences
It will also advise on a comprehensive approach to facilitate pharmacist prescribing. This will include, but not be limited to, empowering pharmacists to assess and prescribe for common minor ailments within a community pharmacy setting and to use their expertise to operate as independent prescribers.
“Pharmacists are highly trained, valued healthcare professionals who already use their extensive training and expertise in medicines to help people every day. They were tremendous partners during the recent COVID-19 pandemic and made a hugely positive contribution to our vaccination programme.
“Empowering pharmacists to use their expertise to assess and treat certain ailments will help patients get the care they need sooner and closer to home – but the benefits go much further. It can help reduce demand on hospitals, walk-in clinics and GP practices.”
For more information on the Kalms range please contact your local BR Healthcare representative or our office on 01-885 0800.
Kalms Night One-A-Night Tablets are a traditional herbal medicinal product for use in the temporary relief of sleep disturbances. Exclusively based on long standing use as a traditional remedy. Always read the label.


Researchers from Trinity are collaborating with those from the University of Oxford on a new project that will provide access to high quality, “live” human brain biosamples. They believe this approach has the potential to revolutionise research for the benefit of patients.
The UK Brain BioLink project (2023-2026), funded by the Medical Research Council, will facilitate the move from static (descriptive) to dynamic (functional) human neuropathology through regular, quality-assured provision of live tissues using a network of laboratories in the UK and Ireland (Aston, Dublin, Oxford and Southampton).
The project aims to facilitate rapid access to high quality, well characterised human brain biosamples and data for translational and basic neuroscience research.
The current system of collecting brain tissue from donors to promote research into disorders of central nervous system does not offer what neuroscientists need. It is focused on traditional post-mortem approaches (not living nervous tissue); is biased towards end-stage neurodegeneration; is not technology-driven; is inflexible; and in many cases is expensive due to fragmentation.
Professor Mark Cunningham, Ellen Mayston Bates Professor of Neurophysiology of Epilepsy at Trinity,said, “This work will ultimately benefit patients by improving the approaches by which new drugs can be developed for conditions such as epilepsy and other diseases of the human nervous system.”
The project will impact on academic translational neuroscience, allowing researchers to use biosamples to define normal or abnormal function of the human nervous system.
This builds on Professor Cunningham’s work that has pioneered the establishment of a research platform with colleagues at Beaumont Hospital/ RCSI and the SFI-funded FutureNeuro centre to conduct electrophysiological studies on live human brain tissue obtained from patients undergoing neurosurgical procedures as part of their treatment for drugresistant epilepsy.
In her final report on the provision of child and adolescent mental health services (CAMHS) in the State, the Inspector of Mental Health Services, Dr Susan Finnerty, has said that she cannot currently provide an assurance to all parents in Ireland that their children have access to a safe, effective and evidence-based mental health service.
 Dr Susan Finnerty, Inspector of Mental Health Services
Dr Susan Finnerty, Inspector of Mental Health Services
The Inspector’s independent review into CAMHS, which she commenced in April 2022 - and included the publication of an interim report in January 2023has now been finalised complete with 49 recommendations.
Due to the seriousness of the concerns raised by the review, the Inspector has recommended that a comprehensive strategy for CAMHS and all other mental health services for children be prepared and approved by the HSE Board.
Despite targeted improvements by the HSE to solve some of the issues, the Inspector states in the report that it is a major concern that there are ongoing and serious deficits in CAMHS which is increasing the risk to children and young people.
And while she acknowledged that there are good CAMHS services in the State – calling out in particular “the excellent and skilled staff” who provide services as the “main CAMHS asset” - she stated, “I cannot currently provide an assurance to all parents or guardians in all parts of Ireland that their children have access to a safe effective, and evidencebased mental health service.”
The Inspector found that the issue of access to CAMHS, or any mental health service for a child, was causing “profound” distress and frustration to parents who “expressed concern at how their child deteriorated while waiting for an assessment”.
“Parents did not know where they can get help and information about services for their child and felt that a crisis needed to be reached before appropriate services are offered to them, or that they have to battle with services before help is provided,” she said.
She added that many young people and their families are “frustrated, distressed and are trying to cope with deteriorating mental health difficulties while
waiting for lengthy periods on waiting lists for essential services”. Dr Finnerty also found that there are certain groups of children and their parents who have difficulties in accessing CAMHS due to language, culture, stigma, fears and location.
The Chief Executive of the Mental Health Commission, John Farrelly, noted the finding in the report that one of the primary reasons why CAMHS is not functioning as it should is the lack of effective governance and accountability at both clinical and corporate level.
“The report clearly demonstrates that current systems for governing CAMHS services are not working,” he said. “They lack basic management, information gathering and oversight structures that are needed to operate safe and effective services. The Inspector has recommended immediate reform of these structures and has also recommended the independent regulation of CAMHS by the Mental Health Commission to help guarantee that all children have access to evidence-based and safe services, regardless of geographical location or ability to pay.
“The Inspector has found that ineffective governance in some areas is contributing to inefficient and unsafe CAMHS, through
failure to manage risk, failure to fund and recruit key staff, failure to look at alternative models of providing services when recruitment becomes difficult, and the failure to provide a standardised service across and within CHOs.
“Regulating CAMHS, under the Mental Health Act, as recommended by the Inspector, would provide the MHC with the statutory powers to immediately work with stakeholders and clinical staff to develop standards and rules for the provision of CAMHS community services in Ireland. Currently the MHC has powers to intervene and safeguard children in inpatient units. However, there has been no oversight of community services and this will continue to be the case until the Government introduces regulation of CAMHS community services.
“It is clear from the report that there must now be a root and branch rebuilding of CAMHS, “added Mr Farrelly. “The HSE, with support from the Department of Health, must immediately put together and publish a formal strategy for this rebuild, including how all the recommendations from the Inspector’s report will be addressed and how the implementation of the recommendations will be overseen.”
Introduc�on
Homecare companies specialise in suppor�ng the movement of pa�ents out from the hospital se�ng to the community for their clinical care. Without this type of service, many would have to either remain in hospital or travel frequently to hospital for care. Many IV infusions and other treatments can be safely given in the home either by a nurse, or by the pa�ent themselves. There is a small number of companies working in the area in Ireland, and it presents a unique and rewarding opportunity as a career choice. Homecare can differ from community in that the pa�ent may be located anywhere in the country, it is by its nature, always community based. Homecare is aligned with the concepts of Sláintecare, suppor�ng the success of keeping people in their own communi�es for as long as possible. Sláintecare “focuses on providing the right care, in the right place, at the right �me, where the pa�ent / service user is paramount and strong emphasis is placed on preven�on and public health. Programmes will design integrated services to provide care and support at, or near, home where appropriate and to ensure hospital stays are minimised”. Medica�on is dispensed to the home, and a nurse then visits the pa�ent to administer an IV infusion at home, avoiding a trip to hospital, and suppor�ng the pa�ents in their own environment.

Homecare companies specialise in supporting the movement of patients out from the hospital setting to the community for their clinical care. Without this type of service, many would have to either remain in hospital or travel frequently to hospital for care. Many IV infusions and other treatments can be safely given in the home either by a nurse, or by the patient themselves. There is a small number of companies working in the area in Ireland, and it presents a unique and rewarding opportunity as a career choice. Homecare can differ from community in that the patient may be located anywhere in the country, it is by its nature, always community based. Homecare is aligned with the concepts of Sláintecare, supporting the success of keeping people in their own communities for as long as possible. Sláintecare “focuses on providing the right care, in the right place, at the right time, where the patient / service user is paramount and strong emphasis is placed on prevention and public health. Programmes will design integrated
My name is Caroline Crowley the Superintendent and Supervising Pharmacist in Point of Care pharmacy. A�er many years in community pharmacy, I decided to take my career in a different path and took my current role in Point of care outpa�ent dispensing facility. My skillset from my community pharmacy background has been part and centre of my suitability for the role. My current role has helped give me greater insight into the Irish healthcare system, home care for pa�ents in Ireland, warehousing, wholesale, good distribu�on processes and enhanced my clinical knowledge.
services to provide care and support at, or near, home where appropriate and to ensure hospital stays are minimised”. Medication is dispensed to the home, and a nurse then visits the patient to administer an IV infusion at home, avoiding a trip to hospital, and supporting the patients in their own environment.
My name is Caroline Crowley the Superintendent and Supervising Pharmacist in Point of Care pharmacy. After many years in community pharmacy, I decided to take my career in a different path and took my current role in Point of care outpatient dispensing facility. My skillset from my community pharmacy background has been part and centre of my suitability for the role. My current role has helped give me greater insight into the Irish healthcare system, home care for patients in Ireland, warehousing, wholesale, good distribution processes and enhanced my clinical knowledge.

In my current role we co-ordinate supply of HOPAT –(Home outpa�ent Parenteral an�microbial therapy) to pa�ents na�onwide daily enabling them to recover at home. We run a compassionate care programme for pa�ents na�onwide with a alpha- 1 deficiency. We dispense pa�ent specific parenteral Nutri�on for a leading na�onal homecare provider. We have just concluded an early access programme for an oral epilepsy medica�on which is now been licenced on the Irish market. We
In my current role we co-ordinate supply of HOPAT – (Home
outpatient Parenteral antimicrobial therapy) to patients nationwide daily enabling them to recover at home. We run a compassionate care programme for patients nationwide with a alpha- 1 deficiency. We dispense patient specific parenteral Nutrition for a leading national homecare provider. We have just concluded an early access programme for an oral epilepsy medication which is now been licenced on the Irish market. We operate the OTC sales programme for Allcare’s online pharmacy. We support a virtual nursing service and supply ancillaries for our nursing teams who deliver several homecare programmes nationwide.
The role is varied and challenging in a different way to community pharmacy, yet all the foundations of community pharmacy are applied. I often see my role as bridging the gap between primary and secondary care to improve patient outcomes and quality of life. In my role I am always learning, developing my skillset, and exploring new ways of working. Other aspects of my role include people management,
financial management, regulatory compliance, quality compliance, logistics planning. I am grateful to have the opportunity to explore a different avenue of my career and hopefully contribute to the evolution of homecare in Ireland and improve access to healthcare for patients.

I have been working as the Superintendent Pharmacist in TCP for 10 years now, and the role is as interesting and rewarding now, as it was when I started. I have never looked back in my career choice. The key thing that has kept me motivated throughout this time, is that patient care and quality of service is at the heart of what we do.


We are no “normal” pharmacy, in that some of the drugs we dispense are only available through ourselves and nowhere else! We specialise in moving patients out from the hospital setting to the community, the medicines we supply include orphan drugs, IV therapies, haemophilia blood clotting factors, and immunotherapies. These medicines are generally not available in the patient’s local community pharmacy and may not even be available in hospital in some cases.
I’m lucky to work with an amazing team of pharmacists, drivers, warehouse, pharmacy technicians, quality, and customer service. Delivering specialised cold chain medicines to the
patient home takes a lot of work in the background, whether it is the validation of our vans, providing patient counselling on the appropriate use of medicines or problem solving so that we help our patients with fridge emergencies. Our patients are scattered all around the country, which can provide logistical challenges at times. I will always remember the big storm of 2018 when our drivers left Dublin early morning for some very long days in dreadful snow, just on the cusp of the red weather alerts to get all of the medicines to all of our patients on time. That was a proud day, and I felt our drivers were phenomenal.
Many of our pharmacy patients are lifelong, and although we don’t see them face to face, we build up a rapport with them over the phone, so that we feel we have known them forever. It means a lot when we hear good reports back from patients. It is not uncommon for our patients to tell us their positive news stories. It’s heartening to hear from a patient who let us know that she can’t live without her treatment and that is has been life changing for her. At Christmas time the pharmacy is swamped with thank you messages, cards, and boxes of chocolate and biscuits.
Every day is different in my role. One of the days that stands out for me over the years include the day we got a thank you card from the family of a patient my own age who had passed away tragically before his time from cancer – how our service had allowed him to spend his final months at home with his family and children and avoid hospital – how much that time meant to his family and how grateful they were for that.
Sometimes standing in the fridge checking TPN for a patient seems so ordinary and mundane, when you receive a thank you card of that nature, it brings it all home – how much we support our patients, and how the little things are actually big things.
A Career with Baxter Working in homecare pharmacy with Baxter Healthcare offers a unique opportunity for pharmacists to provide vital services to patients requiring aseptically compounded parenteral therapies in the comfort of their own homes. As a registered pharmacy with the Pharmaceutical Society of Ireland, Baxter Pharmacy adheres to the same regulatory requirements as a standard community pharmacy. However, it exists within the infrastructure of a pharmaceutical industry environment and is situated onsite in Baxter Healthcare Ltd, the global multinational healthcare company.
Homecare Pharmacies providing Outpatient Antimicrobial Services (OPAT) enable patients who would have required hospital care to receive care at their home. Nurses either administer the antimicrobial to the patient for the full course of treatment or train the patient to administer it to themselves. This facilitates admission avoidance, frees up resources within hospitals through reduced bed use and increases patient satisfaction as they can recover in the comfort of their home.
Counselling is completed with patients remotely via phone and any adverse events or queries are resolved quickly by working and reporting of any issues with internal or external teams. Pharmacists are in constant close communication with both internal departments and external stakeholders with a lot of communication been carried out via email. Internal departments include Customer Services, Transport, Compounding, Pharmacovigilance, Quality and Dispatch teams. External stakeholders include home nursing providers and hospital multidisciplinary teams.
Pharmacists are trained in quality areas such as; document review, control and access, corrective and preventative actions (CAPAs) and nonconformance reviews (NCRs). Pharmacists can then use this to training, as well as their own clinical knowledge, to continuously improve on processes and procedures, as well as engaging on important projects with commercial and marketing teams.
The attractive career path of homecare pharmacy with Baxter Healthcare gives pharmacists an insight into all the services and roles involved in both a homecare pharmacy service as well as a compounding company. It gives them the opportunity to develop skills both clinically as part of the HomeCare service as well as in quality while working in a Pharmaceutical Company.
Overall, the focus on providing vital services to patients in need within the pharmaceutical industry environment makes homecare pharmacy with Baxter Healthcare a fulfilling and attractive career path for pharmacists in Ireland with lots of opportunities for progression and development.
in constant close communica�on with both internal departments and external stakeholders with a lot of communica�on been carried out via email. Internal departments include Customer Services, Transport, Compounding, Pharmacovigilance, Quality and Dispatch teams. External stakeholders include home nursing providers and hospital mul�disciplinary teams.
Pharmacists are trained in quality areas such as; document review, control and access, correc�ve and preventa�ve ac�ons (CAPAs) and nonconformance reviews (NCRs). Pharmacists can then use this to training, as well as their own clinical knowledge, to con�nuously improve on processes and procedures, as well as engaging on important projects with commercial and marke�ng teams.
What sets our homecare pharmacy apart from community is; (i) that we are dispensing to patients at a distance and (ii) the types of medications that are dispensed, which are primarily aseptically compounded intravenous (IV) therapies. Some of these medications include, IV antimicrobials, subcutaneous (SC) iron chelator products, SC methotrexate, and parenteral nutrition products. Prescriptions are received via healthmail or post and medications are dispensed and delivered directly to patients’ homes, without patients ever presenting themselves to the pharmacy in person.
Every day is different in my role. One of the days that stands out for me over the years include the day we got a thank you card from the family of a pa�ent my own age who had passed away tragically before his �me from cancer – how our service had allowed him to spend his final months at home with his family and children and avoid hospital how much that �me meant to his family and how gratefu for that. Some�mes standing in the fridge checking TPN for a pa�ent seems so ordinary and mundane, when you receive a thank you card of that nature, it brings it all home –pa�ents, and how the litle things are actu
The role of a pharmacist at Baxter involves completing a more comprehensive clinical review of prescriptions than community. Prescription referrals provide us with significantly more information on the patient’s medical history which enables a more holistic care of the patient with their transition from hospital to community care.
The atrac�ve career path of homecare pharmacy with Baxter Healthcare gives pharmacists an insight into all the services and roles involved in both a homecare pharmacy service as well as a compounding company. It gives them the opportunity to develop skills both clinically as part of the HomeCare service as well as in quality while working in a Pharmaceu�cal Company.
Overall, the focus on providing vital services to pa�ents in need within the pharmaceu�cal industry environment makes homecare pharmacy with Baxter Healthcare a fulfilling and atrac�ve career path for pharmacists in Ireland with lots of opportuni�es for progression and development.
More than a quarter of heart failure patients in Ireland (26.9%) feel abandoned after being discharged from hospital, new data has shown.
Dr Angie Brownincome household, to one, but still face mortgages, bills and medical costs and have dependants to support.
“The least we deserve is a medical card once diagnosed with heart failure.”
patients, removal of prescription charges and an assessment of the economic impact of the condition on patients;
in Leinster House on to express alarm over the “persistent underprioritisation in care” - as one patient claims many feel invisible.
‘The needs of heart failure patients in Ireland’ survey paints a grim picture of post-hospital care.
It reveals that 74% said their psychological support needs are not being met, half are failing to get the cardiac rehabilitation they need, while almost 40% of working age patients have neither a medical card nor GP visit card.
Heart failure occurs when the organ stops working as well as it should and finds it more difficult to pump blood around the body efficiently.
There are more than 10,000 new cases in Ireland every year and at least 90,000 people are living with the condition.
Over a third (36%) experience a five-year mortality, higher than for most cancers and it accounts for an estimated 7% of all in-patient bed days in Irish hospitals.
• Expansion of services to tackle the psychological impact of the disease - currently available in just four hospitals nationwide;
• Investment in practical, social and emotional supports in the community that reduce readmissions and improve quality of life;
• Full access for all patients to cardiac rehabilitation.
“Awareness and understanding of the condition among both the public and policymakers is low,” said Dr Angie Brown, Consultant Cardiologist and Medical Director with the Irish Heart Foundation.

And three quarters say their psychological needs to help them cope with the chronic disease are not being met, according to the Irish Heart Foundation research. The charity recently met a delegation of TDs and Senators
“Heart failure affects people of all ages and stages of life in Ireland, a large proportion of whom can be of working age, but unable to work or having to work part time,” said Clare-based Pauline O’Shea, 50, who was diagnosed 11 years ago.
“People in my situation have been invisible and we need to be recognised; there are thousands like me, who went from a two
The Irish Heart Foundation will tell politicians it wants action on five key areas:
• A national Heart Failure Registry equipping health service planners with the information to plan future services and help cut excessive mortality and hospital readmission rates;
• Medical cards for all heart failure
“This is contributing to a persistent, long-term underprioritisation of heart failure.
“Although a lot has been achieved, more needs to be done. Our survey of almost 200 heart failure patients reveals a population of all ages, all walks of life and from throughout the country who are struggling amid a variety of unmet needs.”
Around two thirds of the public want the Government to ban the sale of disposable electronic cigarettes, new research shows.
“In 2019, 18.1% of teens admitted to using vapes but this number will have soared since the introduction of disposable vapes,” he said.
Just over one thousand adults aged 15 and over took part in the Ipsos survey between July 3-15.
The results are published ahead of the Government’s public consultation period on disposable e-vaping devices which ended on July 27.
Of the 1,016 people questioned, 57% in the 15-24 age group supported a disposable vape ban, while half of the 24-35 cohort were in favour.
A similar pattern was found by EU health researchers, the national stroke and heart charity said, who found that e-cigarettes were a gateway to smoking for young people.
Mr Murphy added that research carried out earlier this year by antismoking group Action on Smoking and Health revealed that 69% of the youngsters across the UK who vaped used disposable vapes – up from just 7.7% in 2021.

A survey carried out by the independent polling organisation Ipsos found that 64% of respondents support the banning of disposable e-cigarettes, also known as vapes, while only 28% opposed the measure and 8% were unsure.
Welcoming the Ipsos research, Mark Murphy, Advocacy Manager, Environmental Health and Tobacco, with the Irish Heart Foundation said it showed the public know disposable vapes are not only a health risk but also pose a threat to the environment.
He said only a comprehensive ban of all forms of disposable e-cigarettes could prevent “another generation of young people” from becoming nicotine addicts.
The majority of all other age groups who took part in the survey also agreed the sale of disposable vapes in Ireland should end.
In its submission to Government, the Irish Heart Foundation said a Health Research Board study showed that teenagers who use vapes are between three and five times more likely to start smoking than those who don’t.
“A similar pattern could easily emerge in this country,” he said. The charity’s submission also highlighted the risk to the environment from disposable vapes, which cannot be recycled and which contain plastic, copper and a lithium battery.
Turn to page 73 for our feature on e-cigarettes and vaping in Ireland.
Students at RCSI University of Medicine and Health Sciences have pitched ideas to help solve global healthcare challenges as part of the 2023 Student Innovation Challenge.

The challenge is a part of the RCSI Research Summer School which has been taking place over the month of June, immersing Undergraduate students in the diverse RCSI research environment.
The Student Innovation Challenge Pitch Day is the culmination of four weeks of work by the student teams, who, supported by training in market research, intellectual property and research commercialisation, develop innovations that have the potential solve challenges in healthcare.
The innovation challenge provides undergraduate students with a unique opportunity to work solving challenges under the supervision of an RCSI clinician scientist Challenge Leader, allowing them to acquire key problem-solving, innovation and entrepreneurial skills.
Led by RCSI Head of Innovation Dr Aoife Gallagher, this year’s challenge saw 60 RCSI Research Summer School students working with expert challenge leaders on real clinical problems to become innovators, communicators and ultimately help them become skilled clinical practitioners.
At the pitch event yesterday, The Pink Pathway Team led by Dr Sandra Hembrecht successfully presented their ideas to a panel of judges, including industry experts, to become the winners of the challenge. The team developed a rapid access breast cancer pre-operative care pathway to streamline a breast cancer patient’s journey from diagnosis to treatment.
Commenting on the high quality of all of the team pitches, Dr Gallagher said: “This year’s teams showcased remarkable ingenuity in addressing real-world problems across key healthcare areas. The solutions pitched are a great demonstration of the active collaboration between academics, clinicians and patients that we support and encourage at RCSI to drive advancements in healthcare.”
The teams were tasked with addressing challenges presented by RCSI researchers in key RCSI research areas: neurological and psychiatric disorders, vascular biology, cancer, endocrinology, cardiology and microbiology.

The full list of innovation challenges presented by the RCSI Challenge Leaders were:
• Dr Peter Widdess Walsh: Detection of nocturnal seizures in epilepsy patients.
• Dr Douglas Mulholland: Improved deployment of inferior vena cava filters
• Dr Katie Giblin: Prevention of surgical site infection
• Dr Leanne Cusson: Dispelling myths and increasing awareness of polycystic ovary syndrome
The winners of the 2023 RCSI Student Innovation Challenge ‘The Pink Pathway Team’ with team leader Dr Sandra Hembrech
• Dr Sandra Hembrecht: Optimisation of the breast cancer pre-operative care pathway
• Dr JJ Coughlan: Improved left radial access in coronary catheterisation procedures
• Dr Liah McElligott: Dance therapy to help Parkinson’s disease patients




Friday,
TICKETS

Ageing experts at Trinity College Dublin and the University of Limerick have shown associations of vitamin D status with C-reactive protein (CRP, a measure of inflammation) in older adults.
Inflammation and CRP
CRP can be a blood measure of inflammation in the body. High levels can indicate infection while lower, but still higher than normal - levels can indicate low-grade inflammation. Scientists think that this low-grade constant inflammation (which is common in older adults) can lead to a slow accumulation of damage and be a major risk factor for many of the chronic diseases of ageing including cardiovascular disease, mental health decline, diabetes etc.
Anything that could help decrease CRP levels in the blood may have a positive impact on chronic disease prevention.
Vitamin D
Vitamin D (‘Sunshine vitamin’) is needed for bone health and recently has been linked with immune function. Previous research from the Irish Longitudinal Study On Ageing (TILDA) has
shown that 1 in 8 older Irish adults are deficient in the vitamin with those most at risk including the oldest, smokers, those with low household incomes, smokers, those living with obesity.
Previous work from Professor Rose Anne Kenny and Dr Eamon Laird has also reported on the association of vitamin D with COVID.
The new study used data from TILDA, and examined participants aged 50 years and over who were assessed at Wave 1 of the study and who provided measurement of vitamin D and CRP.
Key Findings:
• The study finds that a deficient vitamin D status was associated with significantly higher CRP levels (inflammation).
• Having a sufficient vitamin D status reduced the risk of a high CRP level compared to being deficient
• These findings remained even after adjusting for other factors such as physical activity, smoking and alcohol, obesity, educational level, kidney function, biological sex and age.
• Overall, those who were younger, male, had tertiary education, not obese, a nonsmoker, and had less than three chronic diseases had significantly lower CRP levels
• Factors that increased the risk of high CRP levels included: included obesity, smoking, being female, physical inactivity, chronic conditions and poorer kidney function and diabetes.
• These observations also provide reassurance for food policy makers that fortification of foods to increase levels of vitamin D could have the potential for health benefits and is not linked with adverse results for inflammation
Dr Eamon Laird, Lead author of the study, said, “This study is very important given the high prevalence of vitamin D deficiency and chronic disease in older adults living in Ireland. Our findings along with previous trials in this area suggest that optimising vitamin D status to above deficient levels could help to benefit the inflammation pathway in community dwelling older adults. “Given that the FSAI just recently changed the vitamin D intake guidelines for older adults to 15ug per day (600 IU), our findings should provide further reassurance for policy makers to show that maintaining a sufficient vitamin D status is actually linked with lower levels of inflammation and did not increase the risk. Remember vitamin D is one component: in order to have the lowest risk of inflammation people should think about vitamin D in combination with regular physical activity, healthy lifestyle, adequate sleep and social interactions.”
The Department of Health has launched an innovative new online visual health data monitoring tool, created to provide an overview of the performance and health outcomes of the health service.
Operated by the Department of Health in partnership with the Health Service Executive (HSE), the Prototype Visualisation Platform for the Health System Performance Assessment (HSPA) Framework will help policymakers, healthcare providers, researchers and patients to better assess and improve system accountability, fairness, and efficiency as we progress towards universal healthcare for all.
The new HSPA website has been populated with health data in the areas of life expectancy, disease outcomes, health risk factors such as; smoking and obesity, the level of access to health services, affordability, the quality of the care provided, as well as the efficiency of health services.

HSPA data indicates that life expectancy at birth in Ireland is consistently above the EU average, at 84.3 years for women and 80.5 years for men in 2021, with increases of 1.2 years and 1.8 years respectively in the last decade, compared with a decrease of 0.2 years and an increase of 0.1 years respectively for EU-27 member countries in the same period.
Figures for 2022 show the leading causes of death in Ireland include respiratory diseases, circulatory diseases (like stroke and heart attack) and cancer, with overall mortality rates continuing to decline steadily. Ongoing investment, through the National Cancer Strategy, Sharing the Vision, Healthy Ireland
initiatives and wider health service reforms and improvements, is intended to support increases in life expectancy, and to reduce mortality rates from chronic disease.
HSE National Director for Operational Performance and Integration, Joe Ryan said, “Where we have previously focused on recording the quantity of our services, ultimately our aim is to measure the outcomes of what we deliver, the experience of patients in accessing and receiving our services together with assessing the value of our services. In the HSE we will work with our committees and our Board to transform the way in which we plan, measure, report and improve. The HSPA will assist with this.”
All pharmacy technicians and pharmacists working in community pharmacy are being invited to take part in a research study, by a pharmacist, which aims to assess the use of and adherence to adjuvant endocrine therapy in early breast cancer in Ireland. Results will be used in a thesis for submission to the MSc Health Economics programme in University of Galway.
The survey applies to community pharmacists and pharmacy technicians working in Ireland only. It is conducted online via Microsoft Forms and can be completed on a smartphone or computer/laptop. To access, please use the link: https://lnkd.in/ehDpY-Gi
Participation is voluntary and you can withdraw your consent at any time by closing the survey. If you have any questions about the survey or research project, you can contact Laoise Wallace at l.wallace4@nuigalway.ie
Thousands of people at risk of hepatitis C are now able to order a test to their home, as the HSE steps up its bid to eliminate the deadly disease.
Over 4,000 at-home hepatitis C testing kits have been ordered and delivered since the HSE home test service went live in April.
Launched on the 5th April 2023, the discreet, at-home tests are free to order online from www.hse.ie/hepc as part of the HSE’s Hepatitis C Treatment Programme, which has already treated over 7,000 people, 95 per cent of whom are now cured. The test involves a finger prick test, with a tiny blood sample dropped into a test tube, which is posted in a pre-paid envelope to a lab for analysis. Those who require follow up treatment will then be contacted and referred to a participating clinic or hospital. Treatment for Hepatitis C is free, tablets are effective and well-tolerated, with over 95% of people cured in as little as 8 to 12 weeks.
The National Hepatitis C Treatment Programme estimates that up to 3,000 people in Ireland may currently have the bloodborne virus, which infects the liver and if left untreated can cause serious and potentially life-threatening damage, leading to cirrhosis, possible liver failure and cancer – as well as a risk of spreading the disease to others. The new self-test aim to reach people who may not be engaged with other services such as drug and alcohol support, as well as people who may have potentially been exposed to virus in the past, through previous injecting drug use, or they could have come into contact with infected blood through medical procedures, blood transfusions and blood products, or equipment used in cosmetic services.
Professor Aiden McCormick, HSE Clinical Lead for the Hepatitis C Programme, said, “One of our biggest challenges is that as patient numbers get smaller, remaining Hepatitis C cases are harder to find and treat. Therefore, it’s vital that we offer a free, easy to access home test – especially for those who have been exposed to the virus but are reluctant to come forward. This latest tool is critical to ensuring more people can receive the treatment they need, or peace of mind, at the earliest opportunity. The results of these tests will help contribute to understanding the prevalence of Hepatitis C.”
A new National Clinical Guideline for treatment of patients with breast cancer has been published by the HSE National Cancer Control Programme (NCCP).

 Professor Risteárd Ó Laoide, National Director, NCCP
Professor Risteárd Ó Laoide, National Director, NCCP
Under the new guideline, for some patients, their total radiotherapy dose can be provided over a shorter timeframe, i.e. within one week compared with three to five weeks while other new techniques recommended will reduce the burden on other patients attending for radiotherapy treatment. The new guideline is an update to 2015 guidelines and includes 10 new recommendations, as well as updated evidence to support previous recommendations.
Professor Risteárd Ó Laoide, National Director, NCCP, said, “This is welcome news for patients undergoing treatment for breast cancer. The guideline sets out recommendations that will mean shorter treatment time for some patients, and therefore fewer inhospital appointments. This will create some additional capacity in the service, meaning more patients can be treated in the same timeframe than previously.”
The guideline was developed by a multi-disciplinary group chaired by Dr Eve OToole, Head of Evidence and Quality Hub in the NCCP, who said: “We worked with radiation oncology clinicians and engaged with patient representatives to develop this evidence-based guideline. We integrated their clinical experience and patient values with the best current evidence to formulate recommendations for clinical practice. The patient focus group provided views of
those who are most impacted by its recommendations, and their valuable feedback shaped the overall guideline.”
Breast cancer is the second most commonly diagnosed cancer in Ireland, and the most common cancer among females (National Cancer Registry Ireland, 2022). According to the National Cancer Registry of Ireland (NCRI), there was an average of 3,392 cases of invasive breast cancer diagnosed in Ireland annually between 2018–2020.
A breast cancer survivor and participant in the patient focus group, Ms Kathleen O’Connor said, “It is fantastic to see these new recommendations. I was delighted to be involved in the patient focus group as I feel that incorporating the patient’s perspective when developing guidance is really valuable.”
A policy toolkit aimed at member organisations of the International Pharmaceutical Federation (FIP) and seeking to accelerate pharmacy-based life-course immunisation has been published recently.
A life-course immunisation approach recognises that health is shaped by a series of events that occur throughout life, including vaccinations known to benefit specific age groups and vulnerable groups. Disease prevention and health promotion is just as important during older age as it is in childhood, the authors of the toolkit write.
For example, older adults are more vulnerable to more severe forms of several vaccine-preventable diseases, including influenza,
COVID-19 and pneumococcal pneumonia. The World Health Organization Immunization Agenda 2030, recommends that all member states adopt a lifecourse approach to immunisation and the United Nations Decade of Healthy Ageing Action Plan 2021–2030 urges the scale up of age-friendly primary health care to provide a comprehensive range of services for older people, including vaccination. Harnessing the power that pharmacists have to
deliver the life-course approach to vaccination is key, the authors say The toolkit “Supporting life-course immunisation through pharmacybased vaccination: enabling equity, access and sustainability” outlines three key policy areas that need to be addressed:
1) Regulations and prescribing;
2) Service remuneration models; and
3) Access to data and vaccination records. For each area, case studies from different countries are presented along with enablers and barriers.
A community pharmacy environment that fosters teamwork ensures high levels of consumer satisfaction. This series of articles is designed for you to use as a guide to assist your team in focusing on meeting ongoing CPD targets and to identify any training needs in order to keep the knowledge and skills of you and your team up to date.
however I would advise slow introduction to prevent over-drying of the skin and also use of a suitable moisturiser for hydration. (non-comedogenic, nonblackhead forming moisturiser) If during a consultation with a customer one can see any sign of early scarring then the person should be directed to their GP to commence systemic therapies as early as possible to prevent further scarring.
Combination therapies are important for the treatment of acne as they have a synergistic effect, therefore you may see patients being prescribed oral therapies such as tetracycline antibiotics or hormonal therapies such as the COCP or Spironolactone as well as prescription retinoids, as studies show that patients commenced on retinoids combined with the above oral therapies have a better outcome.
The below information, considerations and checklist provide support to enable you to run a team training session and identify opportunities for learning within the topic of Acne.
Acne is a very common inflammatory skin condition affecting > 80% of teenagers and up to 20-40% of adults. Recent studies show a rate of 9.4% of the global population is affected.
Most commonly it affects the face, however it may also occur on the back, chest, upper arms, neck and scalp. The cause is multifactorial with a complex interplay between genetics, hormonal influences, especially for females, and also environmental factors.
At puberty, hormone levels suddenly increase resulting in our oil glands becoming oversensitive to these hormones causing an increase in oil/sebum production. This sticky oil/sebum combines with our dead skin cells which are
Consider:
ineffectively shed from the skin’s surface, resulting in blockage of our pores and the formation of a blackhead (comedone).
Adult-onset acne is becoming increasingly common affecting up to 20% of men and 20-40% of women. This may occur in those who previously suffered as a teenager or it may occur for the first time as an adult. In women, hormonal acne is more commonly noted on the lower face, jawline, chin and neck and often flares pre-menstrually.
Treatment of acne depends on severity, however the first port of call is often to one’s pharmacy. It is therefore important to distinguish between mild, non-scarring acne and those who are scarring.
If one has mild acne suitable therapies include over the counter topical treatments containing salicylic, glycolic and lactic acid which may come in the form of a wash or leave on product. This
Is the pharmacy team fully trained on the indications and benefits of all products for the treatment of acne?
How are acne and skincare products displayed in the pharmacy?
Do we make the most of the potential for linked sales?
Am I up to date with the latest guidance?
Am I aware which preparations are recommended first-line?
combination of AHA’s and BHA’s help to keep the skin smooth, unblock the pores and reduce oil production. OTC benzoyl peroxide may also be effective for it’s anti-bacterial effect on the skin, without the risk of resistance. This may be used on a nightly basis,
Key Points:
Acne can affect the quality of life
The importance of asking questions to enquire about symptoms because the nature of Acne varies enormously
Who suffers from Acne
Common causes and signs/symptoms of Acne
The areas most affected on the body
The problem of the itchscratch cycle
The importance of emollient therapy and how it works
Types of emollients and their role in different situations and times of day
Which emollient to choose
The role of urea in emollient products
When to refer.
It is also important to recommend products which provide adequate skin hydration to those patients who are taking oral isotretinoin for the management of scarring acne or acne which has failed other therapies. These patients may need preservative free eyedrops, nasal sprays, sunscreen and emollients for both face, body and especially the lips.
Actions:
Ensure support staff understand the following key points:
The common presenting symptoms
The characteristics of a good analgesic for OTC use in the treatment of acne
The benefits and limitations of OTC medicines
The importance of what outcome a patient presenting with acne wants

Lifestyle issues that may impact on acne flare-ups
When to refer customers to the pharmacist.











Prescribing medication is a significant addition to a registered nurse’s scope of practice. As a professional skill it builds on the qualifications and competencies traditionally recognised at the point of general nurse registration.
knowledge, skills and competence the prescribing candidate must achieve in order to prescribe safely and effectively.
Theresa notes that good prescribing practice should support patient care and encourage treatment concordance and adherence while considering clinical response, tolerability, and lifestyle factors.
including side effects and possible interactions. They must be proficient in practice and demonstrate the understanding, skills and knowledge required to carry out a competent history, assessment and examination specific to the patient’s presenting condition.

We recently spoke to Theresa Lowry Lehnen, RGN, RNP, PhD, Clinical Nurse Specialist and Associate Lecturer with South East Technological University to discuss how systematic clinical decision-making and rigorous risk management processes within relevant clinical governance frameworks inform prescribing decisions and help maximise safe and effective practice as a Registered Nurse Prescriber (RNP).
A nurse prescribing candidate attains the competencies of prescriptive authority by completing an accredited nurse prescribing educational programme. When considered competent to prescribe as per the HEI’s standards for the theoretical and clinical components of the programme, the prescribing candidate gains formal recognition by entry to the Registered Nurse Prescriber division of the register maintained by the NMBI.
“Minimising risk and maximising effectiveness are two key underlying principles of nurse prescribing practice,” Theresa told us.
“Safe and effective practice is founded on a thorough understanding of the theory, concepts, legislation, frameworks, policies, procedures and guidelines pertaining to nurse prescribing. Patient safety is paramount. Therefore, professional and ethical nurse prescribing practice must be based on systematic clinical decision-making and rigorous risk management processes within
relevant clinical governance frameworks. Such processes inform prescribing decisions and help maximise safe and effective practice as a registered nurse prescriber (RNP).
“Prescribing medication is a complex and multi-faceted process which can be associated with adverse risks and inadvertent consequences. Prescriptive authority is therefore governed by a dual framework of professional regulation and legislation pertaining to medication and its associated regulations.
“Practice standards, decisionmaking frameworks, clinical governance structures and NMBI guidelines outline the criteria for safe and effective nurse prescribing practice. They provide a regulatory framework and professional guidance for prescriptive authority which should be subject to continuous quality assurance and regular audits. The laws and regulations, the standards, frameworks and criteria are designed to assure the public of the RNP’s accountability and professional competence. They ensure that appropriate measures of clinical- and self-governance are in place.”
The NMBI Practice Standards and Requirements for Education Programmes for Nurses and Midwives with Prescriptive Authority sets out the educational standards and requirements for nurse and midwife prescriptive authority. The domains of competence represent the levels of
“Patients should be included in clinical decision-making processes which affect them, providing them with choices, while ensuring that prescriptive practice is also safe and appropriate,” she says. “Unsafe practices are a leading cause of medication errors worldwide. The World Health Organisation’s Global Patient Safety Challenge: Medication

Without Harm outlines key local, national and global actions required to reduce the level of medication-related harm, among them patient engagement, education and training, communication and teamwork, professional competence and incident reporting and learning.
“Continuous professional development, education, audit, and evaluation of nurse prescribing practice maximise safe and effective prescribing. Audit, monitoring and evaluation of prescribing practice is a continuous process. It promotes best practice and measures the clinical outcomes and effectiveness of care.”
Prescribing medication is a complex process often associated with side-effects, risks, and unintended consequences.
It is paramount. Teresa says, and in the patient’s best interest to minimise risk and maximise the effectiveness of prescribed medications. “While most medication errors are avoidable, risk cannot always be eliminated. However, as a registered nurse prescriber every step must be taken to ensure that safety is maximised, and risk is minimised within professional practice,” she told us.
“Nurse prescribers must have a thorough understanding of the medication they prescribe,
“This includes understanding the relevance of any diagnostic tests and results in relation to specific conditions and medications. In practice, the RNP must be satisfied that the patient’s presenting condition is within their scope of clinical and prescriptive practice. An understanding of pharmacology, the patient’s needs and the condition being treated help determine the most appropriate medication including dose, form, frequency and route of administration based on the individual patient’s characteristics. “Prescribed medication must be safe, evidence-based and in the patient’s best interest. Underlying principles of good prescribing practice involve selecting appropriate, safe and cost-effective medicines, individualised for the patient’s needs. While pharmaceutical reference books such as the BNF and Irish Medicines Formulary inform prescribing decisions and guide safe practice, each individual consultation must also closely examine the patient’s past medical history, current medications (including OTC, herbal remedies, vitamins and food supplements, homeopathic medications, and any possible interactions), known allergies, sensitivities, and previous drug reactions.
“Other relevant factors that may need to be addressed include pregnancy, breastfeeding, co-morbidities, polypharmacy, cognitive impairment, or difficulties adhering to medication regimen. In addition, social, occupational, and family history must be taken into consideration, and lifestyle factors such as smoking, alcohol and illicit drug use explored to assess potential risks or interaction with the medication prescribed.”
Theresa goes on to highlight that good prescribing practice involves patient education and a


Prescribing Information for Enstilar® (calcipotriol/betamethasone)
50 micrograms/g + 0.5 mg/g cutaneous foam
Please refer to the full Summary of Product Characteristics (SmPC) (www.medicines.org.uk/emc or www.medicines.ie) before prescribing.
Indication: Topical treatment of psoriasis vulgaris in adults. Active ingredients: 50 µg/g calcipotriol (as monohydrate) and 0.5 mg/g betamethasone (as dipropionate). Dosage and administration: Flare treatment: Apply by spraying onto affected area once daily. Recommended treatment period is 4 weeks. If it is necessary to continue or restart treatment after this period, treatment should be continued after medical review and under regular supervision. Longterm maintenance treatment: Patients who have responded at 4 weeks’ treatment using Enstilar once daily are suitable for long-term maintenance treatment. Enstilar should be applied twice weekly on two non-consecutive days to areas previously affected by psoriasis vulgaris. Between applications there should be 2-3 days without Enstilar treatment. If signs of a relapse occur, flare treatment, as described above, should be re-initiated. Maximum dose: The daily maximum dose of Enstilar should not exceed 15 g, i.e. one 60 g can should last for at least 4 days of treatment. 15 g corresponds to the amount administered from the can if the actuator is fully depressed for approximately one minute. A two-second application delivers approximately 0.5 g. As a guide, 0.5 g of foam should cover an area of skin roughly corresponding to the surface area of an adult hand. If using other calcipotriol-containing medical products in addition to Enstilar, the total dose of all calcipotriol-containing products should not exceed 15 g per day. Total body surface area treated should not exceed 30%. Safety and efficacy in patients with severe renal insufficiency or severe hepatic disorders have not been evaluated. Safety and efficacy in children below 18 years have not been established. Shake the can for a few seconds before use. Apply by spraying, holding the can at least 3 cm from the skin, in any orientation except horizontally. Spray directly onto each affected skin area and rub in gently. If used on the scalp, spray into the palm of the hand then apply to affected scalp areas with the fingertips. See hair washing instructions in the package leaflet. Wash hands after use (unless Enstilar is used to treat the hands) to avoid accidentally spreading to other parts of the body as well as unintended drug absorption on the hands. Avoid application under occlusive dressings since systemic absorption of corticosteroids increases. It is recommended not to take a shower or bath immediately after application. Let the foam remain on the scalp and/or skin during the night or during the day. Contraindications: Hypersensitivity to the active substances or any of the excipients. Erythrodermic and pustular psoriasis. Patients with known disorders of calcium metabolism. Viral (e.g. herpes or varicella) skin lesions, fungal or bacterial skin infections, parasitic infections, skin manifestations in relation to tuberculosis, perioral dermatitis, atrophic skin, striae atrophicae, fragility of skin veins, ichthyosis, acne vulgaris,

acne rosacea, rosacea, ulcers and wounds. Precautions and warnings: Adverse reactions found in connection with systemic corticosteroid treatment, e.g. adrenocortical suppression or impaired glycaemic control of diabetes mellitus, may occur also during topical corticosteroid treatment due to systemic absorption. Application under occlusive dressings should be avoided since it increases the systemic absorption of corticosteroids. Application on large areas of damaged skin, or on mucous membranes or in skin folds should be avoided since it increases the systemic absorption of corticosteroids. Visual disturbance may be reported with systemic and topical corticosteroid use. If a patient presents with symptoms such as blurred vision or other visual disturbances, the patient should be considered for a referral to an ophthalmologist for evaluation of possible causes which may include cataract, glaucoma or rare diseases such as central serous chorioretinopathy (CSCR) which have been reported after use of systemic and topical corticosteroids. Due to the content of calcipotriol, hypercalcaemia may occur. Serum calcium is normalised when treatment is discontinued. The risk of hypercalcaemia is minimal when the maximum daily dose of Enstilar (15 g) is not exceeded. Enstilar contains a potent group III-steroid and concurrent treatment with other steroids on the same treatment area must be avoided. The skin on the face and genitals is very sensitive to corticosteroids. Enstilar should not be used in these areas. Instruct the patient in the correct use of the product to avoid application and accidental transfer to the face, mouth and eyes. Wash hands after each application to avoid accidental transfer to these areas as well as unintended drug absorption on the hands. If lesions become secondarily infected, they should be treated with antimicrobiological therapy. However, if infection worsens, treatment with corticosteroids should be discontinued. When treating psoriasis with topical corticosteroids, there may be a risk of rebound effects when discontinuing treatment. Medical supervision should therefore continue in the post-treatment period. Long-term use of corticosteroids may increase the risk of local and systemic adverse reactions. Treatment should be discontinued in case of adverse reactions related to longterm use of corticosteroid. There is no experience with the use of Enstilar in guttate psoriasis. Enstilar contains butylhydroxytoluene (E321), which may cause local skin reactions (e.g. contact dermatitis), or irritation to the eyes and mucous membranes. Pregnancy and lactation: There are no adequate data from the use of Enstilar in pregnant women. Enstilar should only be used during pregnancy when the potential benefit justifies the potential risk. Caution should be exercised when prescribing Enstilar to women who breast-feed. The patient should be instructed not to use Enstilar on the breast when breastfeeding. Side effects: There are no common adverse reactions based on the clinical studies. The most frequently reported adverse reactions are application site reactions. Uncommon (≥1/1,000 to <1/100): Folliculitis, hypersensitivity, hypercalcaemia, skin hypopigmentation, rebound effect,
application site pruritus, application site irritation, application site pain (including application site burning). Not known (cannot be estimated from available data): Blurred vision, hair colour changes. Calcipotriol: Adverse reactions include application site reactions, pruritus, skin irritation, burning and stinging sensation, dry skin, erythema, rash, dermatitis, psoriasis aggravated, photosensitivity and hypersensitivity reactions, including very rare cases of angioedema and facial oedema. Systemic effects after topical use may appear very rarely causing hypercalcaemia or hypercalciuria. Betamethasone: Local reactions can occur after topical use, especially during prolonged application, including skin atrophy, telangiectasia, striae, folliculitis, hypertrichosis, perioral dermatitis, allergic contact dermatitis, depigmentation and colloid milia. When treating psoriasis with topical corticosteroids, there may be a risk of generalised pustular psoriasis. Systemic reactions due to topical use of corticosteroids are rare in adults; however, they can be severe. Adrenocortical suppression, cataract, infections, impaired glycaemic control of diabetes mellitus, and increase of intra-ocular pressure can occur, especially after longterm treatment. Systemic reactions occur more frequently when applied under occlusion (plastic, skin folds), when applied onto large skin areas, and during long-term treatment. Precautions for storage: Do not store above 30°C. Extremely flammable aerosol. Pressurised container. May burst if heated. Protect from sunlight. Do not expose to temperatures exceeding 50°C. Do not pierce or burn, even after use. Do not spray on an open flame or other ignition source. Keep away from sparks/open flames. No smoking. Legal category: POM. Marketing authorisation number and holder: PL 05293/0008 (UK), PA 1025/5/1 (Ireland). LEO Pharma A/S, Ballerup, Denmark. Basic NHS price (UK): £39.68/60 g, £79.36/2 x 60 g. Last revised: March 2021.
Reporting of Suspected Adverse Reactions
Adverse events should be reported.
For the United Kingdom, reporting forms and information can be found at: www.mhra.gov.uk/yellowcard or search for MHRA Yellow Card in the Google Play or Apple App Store.
Adverse events should also be reported to Drug Safety at LEO Pharma by calling +44 (0)1844 347333 or e-mail: medical-info.uk@leo-pharma.com
For the Republic of Ireland, reporting forms and information can be obtained from: HPRA Pharmacovigilance, Earlsfort Terrace, Dublin 2, Tel: +353 1 6764971, Fax: +353 1 6762517, Website: www.hpra.ie, e-mail: medsafety@hpra.ie
Adverse events should also be reported to Drug Safety at LEO Pharma by calling +353 1 4908924 or e-mail: medical-info.ie@leo-pharma.com
management plan for follow-up, monitoring and evaluation of care.
“Reviewing medications and monitoring the effectiveness of treatment at each visit enhances patient safety. This is particularly important when polypharmacy exists and in patients with comorbidities. Patients should be provided with clear explanations and a rationale for the medication prescribed, including name, description, purpose, dose, frequency, duration, route, and any additional instructions required.
“Any potential side effects or interactions with other medicines or food products should be discussed, and patients advised what to do if they have any concerns. Prescriptions issued must comply with legislation and NMBI practice standards. They should state the precise medication, generic name, regimen, dose, strength, route and frequency, the patient’s name, address, date of birth, date of initiation of the medication and maximum duration. Abbreviations are avoided, and only internationally and nationally recognised units are used.
“All prescriptions issued are dated and signed and include the nurse prescriber’s NMBI personal identification number (PIN). Should an error occur, the script should be reissued rather than altered or crossed out.
“In my personal practice, I do not prescribe MDA and off-
label medication. However, it is important to be aware that particular requirements are necessary for Schedule 4 and 5 MDA drugs and a named schedule 2 or 3 MDA drug to be prescribed and issued by an RNP.”
Nurse prescribers have no legal authority to prescribe for any condition or change the route of administration for any Schedule 2 or 3 MDA medication not listed in Schedule 8, she adds.
“Issuing prescriptions for off-label use and EMPs must be within the RNP’s scope of practice. Nurse prescribers must be aware of PPPGs and governance regarding off-label prescribing and the use of medical products outside of the terms of marketing authorisation in Ireland by the HPRA or EMA. Issuing a prescription verbally, by telephone, email or fax, is not permitted under normal circumstances.
“However, provision under Regulation 8 of the Medicinal Products Prescription and Control of Supply Regulations (2003, amended 2007) allows certain prescription-only medicines to be supplied in emergency situations where a written prescription cannot be issued immediately. Legislation changes were issued to facilitate the safe supply of medicines during the COVID-19 pandemic.
“Under the new provision, the National electronic prescription transfer system allows for the transfer of a prescription between
the prescriber and dispensing pharmacy by electronic means. However, any prescription sent outside of the National electronic prescription transfer system by fax or personal or commercial email accounts is not recognised in the legislation as a legally valid prescription.”
Theresa says that important considerations apply within nurse prescriptive practice.
“In the case of repeat prescriptions, an established therapeutic relationship must exist with the patient, and an assessment of the need for continued treatment carried out and documented. The actions of prescribing and administering medication are separated as part of an episode of care, except in agreed circumstances. In keeping with professional practice, prescribing for oneself, family or friends should not be undertaken.
All nurse prescribing decisions and actions undertaken must be documented. Documentation provides information and continuity of care and promotes quality and evidence-based practice. Comprehensive documentation is a legal requirement and an integral part of the prescribing consultation to ensure accountability and patient safety, thus minimising risk in practice.
“To comply with standards and ensure safe and effective nurse prescribing, risk assessment tools and guidelines must be in place, including PPPGs for medication

safety, managing adverse events and incident reporting.
“If a medication error or adverse incident occurs, nursing and medical interventions must be implemented immediately, focusing first on the patient’s physical needs to ensure safety and limit potential adverse effects. Medication adverse risk management guidelines and protocols must be strictly followed and adhered to. Line management and relevant staff must be informed of the incident as soon as possible and the National Medicines Information Centre (NMIC) and/or the National Poisons Information Centre (NPIC) contacted where appropriate. The patient, their family or carer must be made aware and informed of the incident as per the National HSE Open Disclosure Policy. The incident and all actions taken must be documented and incident management forms completed and returned.
“Medication errors resulting in adverse reactions must be reported to HPRA in accordance with their criteria. The National Incident Report Form (NIRF) should be completed and returned as soon as possible after the incident occurs, usually within one working day.”
The main objective of incident reporting and management is to learn from the incident to reduce the risk of its reoccurrence and ensure the safety of future patients.
Theresa concludes, “Registered nurse prescribers’ decisions are based on pharmaceutical knowledge, professional judgement and practical skills, and underpinned by an in-depth understanding of the relevant professional, legal and ethical frameworks and guidelines. Safe and effective practice in the best interest of patients is of the highest importance and must take precedence in nurse prescribing practice.
“A commitment to continuous education and professional development, including regular audit, monitoring and evaluation of care ensures safe and effective prescribing practice within the clinical setting. While risk cannot always be fully eliminated, it can be minimised, and effectiveness maximised, through collaborative working, clear communication, systematic clinical decision-making and rigorous risk management processes within relevant clinical governance frameworks.”
Diabetes Ireland recently launched its 2022 Annual Report summarising its work and activities in the areas of diabetes advocacy, education, support, and awareness. Below we give an overview of their report.
Support & Information
,
with support from Novo Nordisk, this free interactive programme was launched to meet increasing demand from people with Type 2 diabetes who want to learn more about their condition and how to manage it effectively.
8 8 p e o p e a t t e n d e d o n e o f o u r w e l b e i n g w o r s h o p s %
“Throughout 2022, Diabetes Ireland continued to provide its services to the diabetes community ensuring that thousands of people continued to receive education, support, and motivation to maintain good management of their condition. Likewise, the continuing support of our members and the diabetes community has helped Diabetes Ireland enormously in maintaining our services, and for this, we are extremely grateful.
9 8 p e o p l e c o n t a c t e d o u r h e l p i n e w i t h
8 % o f c a l e r s s e e k i n g n f o r m a t i o n a n d s u p p o r t o n d i a b e t e s m a n a g e m e n t a n d a c c e s s i n g d i a b e t e s s e r v i c e s
Many schools supported our Go Blue for World D abetes Day campaign for wh ch we are extremely grateful
We he d our f rst post cov d n-person events for younger children l v ng w th Type 1 d abetes and the r fami ies with summer p cnics held n Dubl n and Cork and Christmas part es held in Cork Donegal an Dubl n More than 120 fam lies attended one or more of these events
In March 2022 a new campaign #CKD was aunched on World K dney Day with the Ir sh Kidney Association h ghl ght ng that peop e liv ng with D abetes should be aware of their k dney health Working n partnership w th the Irish K dney Associat on, CKD Steering Committee and AstraZenca to create an effective campa gn to promote awareness of this issue
High ighting the persona story of Rachel who was diagnosed w th type 1 diabetes at 8 years of age and later diagnosed w th stage 4 chronic kidney disease at 28 years of age Reaching an audience of 667,589 in August 2022 Diabetes Ireland continues to promote this campa gn - see www diabetes ie
“Advocacy was once again a main priority of Diabetes Ireland. Our aim is to see improved public services, better and quicker access to good quality care, diabetes technology and medications, and better recognition of diabetes and the diabetes community by the Government and its public officials. Work is continuously ongoing to achieve improvements that will benefit the diabetes community. Diabetes Ireland launched its 2023 Pre-budget submission in the summer of 2022 which proposed a number of immediate actions for implementation to improve the quality of life for over 295,000 people living with diabetes and reduce the long-term costs of preventable diabetes complications. Following a positive and engaging meeting with the Minister for Health in advance of the budget, we were delighted to see new budgetary funding allocated for a range of diabetes priorities.
In January 2022 Diabetes SMART was aunched as a free nteractive onl ne education platform Deve oped by D abetes Ireland w th support from Novo Nordisk this free programme meets the increasing demand from peop e w

“A campaign to highlight the need for people living with Diabetes to be aware of their kidney health. was launched in collaboration with the Irish Kidney Association and supported by Astra Zeneca. The campaign focused on raising awareness of the link between diabetes and kidney disease and highlighting that screening for kidney disease is a routine part of your diabetes care and encouraged all people with diabetes to discuss their risk of kidney disease with their Doctor or Nurse and to take all the necessary steps to ensure their kidneys remain as healthy as possible.

“The summer months saw a return to face-to-face events with a number of outdoor family events held, followed by various Christmas parties in December.
“Both our Diabetes Ireland Care Centres in Cork and Dublin continue to be extremely busy with high numbers attending each Centre. As well as providing podiatry, Diabetic Retina
2 6 9 p e o p e l v i n g w t h T y p e 2 D i a b e t e s a t t e n d e d o u r 6 m o n t h C O D E E d u c a t o n p r o g r a m m e D abetes Ireland a so cal ed for the sett ng up of a d abetes task force to deve op a 10-year National Diabetes Strategy that prov des v sion eadersh p and d rect on so that the HSE can recruit the staff required and improve the qua ity of l fe for peop e iv ng with d abetes and reduce the long-term costs to the hea th service of diabetes comp ications 2022
th Type 2 d abetes who want to earn more about their condition & how to manage it effective y See wwww diabetes ie for more informat on We ran awareness campaigns promoting the importance of getting both the nfluenza vaccination and pneumococca vacc ne for the d abetes community Our health promotion team de ivered 28 community d abetes educat on sessions to a range of commun ty groups and workp ace staff and 35 d abetes education workshops were del vered to the staff of Nurs ng and Long-Term Res dent a Homes and Intel ectua D sab l ty Centres 2023 Pre-budget subm ssion proposed a number of mmediate act ons for mplementat on to improve the qual ty of fe for over 297 000 peop e l v ng w th d abetes and reduce the long-term costs of preventab e diabetes compl cations New budgetary funding allocated for a range of HSE diabetes priorities D abetes Federat on of Ireland (T/A Diabetes Ire and) is a registered charity CHY 6906 info@diabetes ie www diabetes ie 01-8428118
“Diabetes Ireland also called for the setting up of a diabetes task force to develop a 10-year National Diabetes Strategy that provides vision, leadership, and direction so that the HSE can recruit the staff required and improve the quality of life for people living with diabetes and reduce the long-term costs to the health service of diabetes complications. We are hopeful that we will see this come to fruition in the near future.
Advocacy
“Diabetes Ireland continued to offer excellent support and services to people with diabetes and their families. In 2022, we aimed to deliver services to people with diabetes and their families by increasing awareness of diabetes and encouraging them to make positive lifestyle changes.
“Diabetes SMART was launched as a free interactive online education platform which is available at www.diabeteseducation.ie.


Developed by Diabetes Ireland
Screening and counselling services, our Care Centre’s continue to be a fantastic resource for people seeking support and information on the many facets of diabetes, for both people who may be recently diagnosed and for those living years with the condition and who need some additional support to manage their condition more effectively.
“As ever, our goal is to support, educate, motivate, and empower people with diabetes and their families and to advocate for optimum health care for all those with diabetes in Ireland. As well as maintaining current services, we are committed to growing our services long into the future. We need and want you to become and stay a member so we can mutually support each other.
“Once again, we cannot express enough our appreciation for the ongoing support we receive from our current volunteers, fundraisers, healthcare professionals, members, employees, corporate supporters and the HSE for helping us help our community. We must all continue to work together for people with diabetes in Ireland so that we can all live long and healthy lives.”


an increase in both the number of cancer diagnoses and ongoing improvements in cancer management.
According to the NCRI, cancers with poorer average prognosis have shown substantial relative increases in survival, with more than a doubling of survival for lung cancer since the 1990s. 5-year net survival for lung cancer from 2014-2018 was 19%, which represents a 15%+ change in 5-year net survival compared to data from 1994-1998. (Figure 12)

in environments of care and complex patient presentations. The principal objective of the NCG is to improve the quality of care received by patients. Other objectives include improving patient outcomes, potential for reduction in morbidity and mortality, and improvement in quality of life. In Ireland there are eight hospitals designated as cancer centres.
Introduction
Lung cancer is the most common cause of cancer mortality worldwide and the 3rd most common cancer diagnosis in Ireland.1,2 Smoking is the biggest risk factor in the development of lung cancer in Ireland, followed by radon exposure, which is estimated to account for approximately 300 lung cancer cases per year.3 The HSE and Healthy Ireland has made smoking cessation policy a priority, with a target of a Tobacco-Free Ireland by 2025. The focus on smoking cessation is evidenced by national strategies including the first workplace ban on smoking worldwide implemented in Ireland in 2004. Galway University Hospital, along with many other hospital groups implement a campus-wide smoking ban.
The prognosis of patients with lung cancer is closely related to stage at time of diagnosis, so early recognition, referral and diagnosis is vitally important to improve outcomes. There is growing interest in lung cancer screening programs following large scale UK, European and US studies, with national programs and pilot programs currently in development throughout Europe.
2018-2020 there were a total of 2,672 new diagnosis of lung cancer (1457 male, 2672 female).2
Complete cancer prevalence is defined as the number of persons surviving with or following a diagnosis in Ireland. The NCRI report a prevalence of 3.5% at the end of 2020 in Ireland, amounting to 7321 persons –patients living with a diagnosis of lung cancer, either undergoing active or palliative treatment, or longer-term survivors.2
Cancer is the leading cause of death in Ireland. 32% of deaths occurring in 2019 were attributed to neoplasms, and 30% in 2020. Lung cancer was the leading cause of cancer death in both sexes, with an average of 1,916 deaths per year or 19% of cancer deaths in women and 21% of cancer deaths in men during the period of 20162018. Lung cancer is a common diagnosis, and remains a highfatality malignancy, with only 4% of lung cancer patients still alive at the end of 2020.2
According to the NCRI, cancers with poorer average prognosis have shown substan�al rela�ve increases in survival, with more than a doubling of survival for lung cancer since the 1990s. 5-year net survival for lung cancer from 2014-2018 was 19%, which represents a 15%+ change in 5-year net survival compared to data from 1994-1998. (Figure 1 (2))
Lung cancer is projected to increase by 105% in females, and by 131% in males, predicting annual numbers of cases of 3,137 males and 2,313 females by 2045.4 This will have a major impact on service provision needs to ensure we can maintain access to rapid and appropriate diagnostics and management.
The NCCP National Clinical Guideline (NCG) on Diagnosis, staging and treatment of patients with lung cancer5 was developed in 2017 and applies to adults with newly diagnosed lung cancer, or patients with a suspected diagnosis of lung cancer in a hospital setting. Providing standardised clinical care to patients is a priority. The NCCP guideline aims to provide an evidence-based approach to circumnavigate factors that impact care provision, including variation
The cardinal symptom of lung cancer is haemoptysis, but the British Thoracic Society recommends urgent chest X-ray to all patients with symptoms of cough, fatigue, shortness of breath, chest pain, weight loss or appetite loss, or with signs of finger clubbing, supraclavicular or persistent cervical lymphadenopathy, or chest signs consistent with lung cancer.6 A recent study has demonstrated that an increasing number of patients are now presenting with symptoms of dyspnoea or cough, and, in contrast, symptoms of haemoptysis and decreased appetite have declined.7 Early recognition and referral for symptoms concerning for lung cancer is key to achieving early diagnosis, curative treatment and improved survival rates.8
Rapid Access Lung Clinic: The National Cancer Strategy has prioritised early diagnosis of lung cancer as a quality improvement
Lung cancer is the 3rd most common cancer in men, and 2nd most common cancer in females, comprising 11% and 11% respectively between the years 2018-2020 according to the most recent published NCRI report for cancer registrations. Between
Lung cancer is still the leading cause of cancer death in both sexes (21% and 19% respectively). However, there has been a dramatic increase in cancer survivorship, with the 2022 NCRI annual statistics reporting a >50% increase in numbers of cancer survivors compared with one decade ago, reflecting
priority for the Department of Health, with a goal of a 15% relative increase in lung cancers diagnosed at stage I and stage II. The Rapid Access Lung Clinic pathway, with GPs as the primary referrers, has a vital role in early recognition of symptoms of suspected lung malignancy such as haemoptysis, or an abnormal chest x-ray which should prompt early referral to rapid access pathways.5 The NCCP Key Performance Indicators targets that 95% of referrals to RALC should be offered an appointment to be seen at clinic within 10 working days of receipt of a referral.
The Rapid Access Lung Clinic in Galway University Hospital commenced in 2011 and provides a one-stop-shop for diagnostic investigations in our ambulatory unit in Merlin Park Hospital. This unique approach to RALC allows patients to access imaging, bronchoscopy, pleural investigation, ultrasound +/- neck lymph node sampling and lung function testing in one visit.
In Galway University Hospital, a total of 563 patients attended RALC in 2021, with 499 to the time of reporting in August 2022. 543 patients attended RALC or were offered an appointment within 10 working days of receipt of referral, which equates to 96.4% of all referrals in 2021, meeting the key performance target set by the HSE.9
The GUH Interventional Respiratory Unit offers patients access to initial diagnostic tests and staging procedures in a same-day visit, utilising specialist resources to maximise patient contact and aiming to reduce delay between symptom onset and diagnosis, as well as reducing time and cost-oftravel of patient visits. The aim of the interventional Respiratory Unit is to meet the targets set by the NCCP in time-to-diagnosis and time-to-treatment.
There is an evolving landscape of multimodality invasive diagnostic procedures in the work up of suspected lung malignancy, with a focus in recent research on the importance of neck ultrasound and lymph node sampling. An overview of techniques offered in our centre is provided below, in accordance with the NCCP National Clinical Guideline, complemented by thoracic surgical investigations if indicated.
Contrast enhanced CT scanning: In the majority of cases, the first
line investigation is CT scanning of the chest to identify and further characterise the suspected lung malignancy. The national clinical guideline recommends contrastenhanced CT-scanning of the chest and upper abdomen to include the entire liver and adrenals, regardless of chest X-ray results.
FDG PET CT: PET-CT is recommended for mediastinal
and hilar lymph node staging in patients with potentially radically treatable non-small cell lung cancer, prior to invasive staging. If PET positive hilar/mediastinal adenopathy is identified, the highest stage node can be biopsied by appropriate invasive procedure to confirm metastatic spread.
CT/MRI head: In patients with signs/symptoms of brain metastases, or those with stage III NSCLC who are suitable for curative treatment, a contrast enhanced CT of the head/MRI head should be offered.
The choice of bronchoscopic investigation depends on a number of factors, including the location of the primary tumour, patient performance status, clinical expertise and variability of resources between centres.
Flexible bronchoscopy: Flexible bronchoscopy has a good diagnostic sensitivity (83% - 88%)5 for central lesions, defined as a central tumour within proximal one-third of the hemithorax, or enlarged N1 nodes (>1cm). This investigation is particularly useful in solitary central lesions in order to establish a histological or cytological diagnosis. In Galway University hospital, this is facilitated in our ambulatory Interventional Respiratory Unit as a day-case procedure.
Endobronchial ultrasound (EBUS) and endoscopic ultrasound: EBUS-guided transbronchial needle aspiration has high sensitivity and specificity in identifying malignancy in mediastinal and hilar lymph nodes and patients with lung cancer.10 It plays a central role in diagnostics and is often the first investigation of choice, as accurate mediastinal nodal staging is crucial in non-small cell lung cancer, aiding in the identification of patients who are appropriate for surgical resection. EBUS is performed using a flexible bronchoscope with an ultrasound probe attached and can be performed under conscious sedation as a day-case procedure . Transbronchial needle aspiration of the mediastinal nodes is performed for cytological diagnosis. When used in combination with EUS-B a greater number of mediastinal lymph nodes can be visualised and sampled, providing a more comprehensive nodal staging. (Figure 2)
The NCCP guideline recommends that EBUS-TBNA +/- EUS-FNA should be offered to patients prior to mediastinoscopy, a more invasive procedure which confers a higher risk of complications, morbidity and mortality. The use of these techniques also readily allows for repeat sampling of the mediastinum if required.
In Galway University Hospital, a total of 580 flexible bronchoscopies and 431 EBUS were performed via our Interventional Respiratory Unit in 2022, an increase from 464 and 320 respectively in 2021.

Rigid bronchoscopy: Rigid bronchoscopic procedures are offered to specific patients following MDM discussion, for the purpose of surgical debulking of the cancer, relief of endobronchial obstruction, and airway stenting. It can be performed with therapeutic or palliative intent.
accuracy and therefore diagnostic yield of the procedure.12
presentation demonstrated that MDM-discussed patients were more likely to undergo treatment and had a 25% lower risk of mortality.19
The overall proportion of new attendances at RALC nationally who were diagnosed with a primary lung cancer was 31%.
Our RALC in Galway University Hospital reports similar rates, with 30% of new attendees receiving a diagnosis of primary lung cancer in 2018, 36% in 2017 and 32% in 2016. A high proportion of patients remain diagnosed through nonspecialist respiratory clinics, which can impact on timely access to appropriate diagnostic pathways, multidisciplinary discussion and treatment planning.
The NCCP guideline recommends that EBUS-TBNA +/- EUS-FNA should be offered to pa�ents medias�noscopy, a more invasive procedure which confers a higher risk of complica�ons, and mortality. The use of these techniques also readily allows for repeat sampling of the medias�num if required.
Navigational bronchoscopy: Peripheral pulmonary nodules are a frequent presentation of lung cancer, and present a challenge in obtaining a tissues diagnosis. Development of navigational bronchoscopy has improved diagnostic yield to approximately 71%. Limitations to navigational bronchoscopy include limited access to resources, both in technology and clinician expertise.11 This is an expanding area of interest and research, and appears to be a safe and effective modality which offers the possibility of improved diagnostic yield for peripheral lung lesions.10
The British Thoracic Society recommends that at least 30ml should be sent for cytological examination. The NCCP recommends that 50ml of pleural fluid and cell block preparation are sent, which aids in immunohistochemical diagnosis. In cases where the initial cytological analysis is non-diagnostic, at least one more pleural fluid specimen could be sent , however further invasive investigations should be considered early if there remains a non-diagnosed exudative effusion after initial assessment. The BTS guideline 2022 recommends that in patients with a suspected pleural malignancy and nondiagnostic pleural aspiration, a radiology guided pleural biopsy or thoracoscopy should be performed for tissue diagnosis.
particularly useful for confirmation of staging following PET-CT. Fine-needle aspiration or core biopsy of a pathologically enlarged lymph node is performed under ultrasound guidance on patients with cervical lymphadenopathy identified on clinical examination or CT/PET-CT by trained respiratory physicians . Studies report a diagnostic yield of 84%-90.5% based on lymph node sampling alone.16,17 This suggests that neck ultrasound and lymph node sampling is feasible, with high diagnostic accuracy from a minimally invasive procedure.
In Galway University Hospital, a total of 580 flexible bronchoscopies and 431 EBUS were via our Interven�onal Respiratory Unit in 2022, an increase from 464 and 320 respec�vely
As discussed, significant advances have been made in lung cancer diagnosis and staging, resulting in an increasing variability in biology, tumour burden, immunohistochemical biomarkers and therefore a broad range of prognoses for any given pathology and stage. This necessitates targeted patient discussions about suitable treatment modalities to ensure optimal outcomes. The Joint Thoracic Clinic in Galway University Hospital is a collaborative approach to treating patients with lung cancer. Multidisciplinary cancer clinics can streamline lung cancer services, with an aim to decrease time from diagnosis to treatment.20 This model of cancer care has also been shown to improve patient satisfaction and increase collaboration and communication among multidisciplinary team members.21
Rigid bronchoscopy: Rigid bronchoscopic procedures are offered to specific pa�ents following discussion, for the purpose of surgical debulking of the cancer, relief of endobronchial obstruc�on, and airway sten�ng. It can be performed with therapeu�c or pallia�ve intent.
Pleural Invetigations
Investigations
Pleural aspiration is indicated for all patients with a pleural effusion in the setting of suspected lung malignancy. Diagnostic pleural aspiration remains an important intervention and may lead to a diagnosis in many cases. It is recommended to be performed under ultrasound guidance, which has the benefit of being able to be performed at the bedside, or in an ambulatory capacity, and increases
Pleural:
If a pleural effusion is confirmed to be malignant, either histologically or cytologically, it is associated with a poorer prognosis13, as it confirmed metastatic disease (Stage IV) as per TNM staging criteria.14

Neck ultrasound and lymph node sampling either via FNA or Core biopsy has an important role in suspected lung malignancy15, and in turn can reduce the burden of more invasive procedures (bronchoscopy/EBUS). It is
The diagnosis, staging and treatment of patients with lung cancer requires a multidisciplinary approach in an acute hospital setting, including respiratory physicians, radiologists, thoracic surgeons, oncologists, radiation oncologists, pathology services, specialist nurses and palliative care. This multidisciplinary approach is increasingly essential given the rapidly evolving complexity of lung cancer diagnosis, including multimodality invasive diagnostic interventions, expanded biomarker testing, and novel therapeutics.18 The HSE National Cancer Strategy targets 95% compliance with discussion of patient cases at MDM. Nationally, 92% of cases were discussed between Jan-Jun 2018. A review of the impact of MDM
Conclusion
A coordinated approach to assessment, diagnostics followed by MDM discussion can result in significant improvement of services with faster completion of the diagnostic pathway and commencement of therapy. Galway University Hospital has developed rapid access to pathways including the utilisation of the Interventional Respiratory Unit to provide one stop assessments of patients with presumed lung cancer. The Joint Thoracic clinic is a unique multidisciplinary clinic that ensures early discussion of diagnosis and stage and same day review of the treatment plan.
Naviga�onal bronchoscopy: Peripheral pulmonary nodules are a frequent presenta�on cancer, and present a challenge in obtaining a �ssues diagnosis. Development of naviga�onal bronchoscopy has improved diagnos�c yield to approximately 71%. Limita�ons to naviga�onal bronchoscopy include limited access to resources, both in technology and clinician exper�se. This is an expanding area of interest and research, and appears to be a safe and effec�ve which offers the possibility of improved diagnos�c yield for peripheral lung lesions. (10)
References available on request
Pleural aspira�on is indicated for all pa�ents with a pleural effusion in the se�ng of suspected malignancy. Diagnos�c pleural aspira�on remains an important interven�on and may lead
With the growth in popularity of e-cigarettes in recent years, there is concern in terms of their use by young people. Plans to ban the sale of e-cigarettes to under-18s are being introduced, but currently there is no mandatory age restriction on the sale of e-cigarettes and their marketing may promote adolescent use
Nicotine exposure can harm adolescent brain development, and may act as a ‘gateway’ to smoking initiation among the youth.
Theresa Lowry
 Lehnen, Clinical Nurse Specialist and Associate Lecturer South East Technological
Lehnen, Clinical Nurse Specialist and Associate Lecturer South East Technological
University recently spoke to Irish Pharmacy News about the rise in use of e-cigarettes and vaping products.
Electronic nicotine dispensing systems (ENDS) commonly known as electronic cigarettes, and vaping products have revolutionised smoking and the tobacco industry over the last two decades. Often considered less harmful than conventional cigarette smoking, e-cigarette and vaping products have transformed nicotine use, particularly among young people, repopularising it and creating a new generation of users. The market is expected to grow annually by 3.44% (CAGR 2023-2027).
Plans to introduce a ban on selling e-cigarettes to under-18 has secured approval from the Republic of Ireland’s cabinet.
New laws, due to be enacted this summer, will limit which retailers can sell nicotine-inhaling products in the Republic of Ireland.
Electronic cigarettes first entered the global marketplace in 2006. The fourth-generation ecigarettes were introduced in 2016, and have had the greatest impact on e-cigarette use and vaping behaviour. There was an exponential rise in e-cigarette use associated with their arrival, especially in the adolescent population. Many of the fourthgeneration devices can deliver nicotine similarly to smoking cigarettes and levels can peak within 5 minutes of inhaling the aerosol.
Because e-cigarettes are combustion-free, and many of the damaging effects of tobacco are derived from this reaction, there is a common assumption that e-cigarettes or vaping is safer than conventional cigarette smoking. “Vaping is not harm free,” says Theresa. “Most vaping liquid products contain nicotine, which is the same addictive substance found in tobacco. The addictive potential of nicotine may mean that
people who vape are more likely to become cigarette smokers. Vaping may damage the lungs; release free radicals, which promote cancer development in the body; weaken the immune system; and delay brain development in foetuses, children, and teenagers.
“Nicotine has significant biologic activity and adversely affects several physiological systems including the cardiovascular, respiratory, immunological and reproductive systems, and can also compromise lung and kidney function. In addition to its toxicological effects on foetus development, nicotine can disrupt brain development in adolescents and young adults. The vapour liquid in e-cigarette products is dangerous if swallowed, and vaping also delivers dangerous chemicals, including diacetyl, cancer-causing chemicals, heavy metals, and volatile organic compounds.”
Vaping products are often used as an aid to stopping smoking; however, e-cigarettes are not licenced medicines to aid smoking cessation.
Theresa adds, “The World Health Organisation suggests that ecigarettes cannot be considered as a viable method to stop smoking, due to a lack of evidence, and the results of studies addressing the use of e-cigarettes as a smoking cessation tool remain controversial.
“There are strong differences of opinion on e-cigarettes between countries. Brazil, Uruguay and India have banned the sale of e-cigarettes, while others such as the United Kingdom support the device to quit smoking. Increasing number of adolescent users and reported deaths in the United States prompted the government to ban the sale of flavoured e-cigarettes in 2020.
“The HSE does not recommend vaping for smoking cessation. Licenced smoking cessation products go through strict quality and safety checks before they can be sold to the public. While there are some regulations for vaping products, the system is not
strictly regulated, unlike the system for licenced smoking cessation medicines.”
The lethal dose of nicotine for an adult is estimated at 30–60 mg. 5 mls of a 20 mg/mL nicotinecontaining refill is equivalent to 100 mg of nicotine. Theresa adds, “Given that nicotine easily diffuses from the dermis to the bloodstream, acute nicotine exposure by e-liquid spilling can be toxic. Devices with rechargeable refills are an issue of concern with e-cigarettes, especially when e-liquids are not sold in child-safe containers, increasing the risk of spilling, swallowing or breathing.
“Global data on the numbers of individuals using e-cigarettes are limited. Only about half of the adult population has been surveyed regarding its use. Using established epidemiological calculations for assessing use, Jerzynski et al, estimate that 68 million adults globally were vaping, in 2020.
“In 2019, 4.5% of US adults aged 18 years and older used e-cigarettes, almost doubling in 2 years. For adults 45 years and older, most were current or former smokers. The highest prevalence of e-cigarette use was found in adults aged 18–24 years, and more than half of these individuals had never smoked cigarettes. These statistics support the idea
that a considerable number of people are not using electronic nicotine dispensing systems for smoking cessation.”
One of the major issues in the e-liquid market is the range of nicotine content available. Depending on the manufacturer, the concentration can be presented as low, medium or high, expressed as mg/mL or as a percentage (% v/v).
Concentrations range from 0%, nicotine-free option to 20 mg/ mL (2.0%) the maximum nicotine threshold according to directive 2014/40/EU of the European Parliament and the European Union Council.
“Despite this normative, some commercial e-liquids have nicotine concentrations close to 54 mg/ mL, much higher than the limits established by the European Union. Recently the Elf bar range was removed from many retail stores in the UK due to certain flavour products exceeding maximum nicotine levels. The Elf Bar 600 was found to have at least 50% more than the legal limit for nicotine e-liquid,” Theresa notes.
“The most common components of e-liquids are PG (1,2-propanediol), and glycerol or glycerine (propane-1,2,3-triol). Both types of compounds are used as humectants to prevent the e-liquid from drying out. With
regards to toxicity, little is known about the effects of humectants when they are heated and chronically inhaled.
“Studies have indicated that PG can induce respiratory irritation and increase the probability of asthma development, and both PG and glycerol from e-cigarettes might reach concentrations sufficiently high to potentially cause irritation of the airways. Airway epithelial injury induced by acute vaping of PG and glycerol aerosols (50:50 vol/ vol), with or without nicotine, has been reported in two randomised clinical trials. Although PG and glycerol are the major components of e-liquids other components have been detected, including formaldehyde, acetaldehyde and acrolein, 3 carbonyl compounds with known high toxicity.
“Other compounds detected in aerosols include acetamide, a potential human carcinogen, and some aldehydes. The range of e-liquid flavours available to consumers is extensive and is used to attract both current smokers and new e-cigarette users, which is a growing public health concern.”

The evidence of potential association between cardiovascular risks and e-cigarette use is evolving and often controversial, Theresa told us.
“Results from a Swedish randomised control study, presented at the European
Respiratory Society Congress in September 2021, suggested that aerosolised nicotine from vaping was associated with increased thromboembolic activity and disruption of small vessel dilation and relaxation. Earlier studies have shown conflicting evidence about blood pressure and heart rate reactions associated with e-cigarette use, possibly related to the generation of devices used and nicotine concentration.
“Overall, the consensus is that vaping alone presents less harm to blood pressure and heart rate regulation than the use of traditional combustible cigarettes. However, studies are needed to determine these effects. Evidence suggests that adolescents who regularly use e-cigarettes are highly susceptible to nicotine addiction and rates of addiction have increased sharply since the arrival of the fourthgeneration devices.”
Tobacco cigarette smoking is the primary cause of preventable cardiovascular death. The WHO estimates there are 1.1 billion cigarette smokers globally.
Theresa concludes, “The morbidity and mortality associated with smoking tobacco is well established and is estimated to be responsible for over 7 million deaths annually worldwide. E-cigarettes and vaping products do not produce tar or carbon monoxide, two of the most harmful elements in tobacco smoke. Electronic nicotine dispensing systems could be an alternative to
conventional tobacco cigarettes, with less side effects; however, stricter sale control, and proper regulation of the industry including flavour restriction, as well as further toxicological and chronic effects studies are necessary.
“Vigorous research is ongoing on the association between electronic cigarette use and acute lung injury. More studies and longterm data are needed to assess potential benefits and harms of electronic nicotine dispensing systems and vaping products. Considering the known harm that tobacco use poses to global health, the questions of safety and efficacy of e-cigarette use for smoking cessation requires careful appraisal. There is growing evidence that adolescent vaping is a gateway to smoking traditional combustible cigarettes.
Vaping amongst teenagers in Ireland increased from 23% in 2015 to 39% in 2019, according to research carried out in secondary schools by the Irish Tobacco Free Research Institute. The NDAS survey for 2019-20 shows that 14.9% of the population aged 15 year and older had used e-cigarettes at least once in their lifetime. The Health Behaviour in School-aged Children study shows that e-cigarette use is about twice as common as tobacco smoking and that adolescents who use e-cigarettes are three to five times more likely to start smoking tobacco cigarettes compared to those who never used e-cigarettes.
This evidence suggest that the increase in e-cigarette use by teens poses a threat to the Tobacco Free Ireland policy goal of a smoking prevalence less than 5% by 2025. The European Schools Project on Alcohol and Other Drugs study shows that more students reported using e-cigarettes in 2019 than in 2015, and the use of e-cigarettes among students is now more common than cigarette smoking. Almost four in 10 students (39%) had tried e-cigarettes. Almost one in 5 (18%) are current users.
“Recent evidence shows teenagers, who were identified as low risk for smoking cigarettes, are more likely to start smoking after using e-cigarettes than those who have never used, suggesting that an entire cohort of adolescents who would not have initiated tobacco use, will now be exposed to those risks. Increasing numbers of adolescents report dual use, exposing them to the associated risk of this behaviour. Greater prevention efforts and policy are required globally to prevent adolescents and other vulnerable populations from initiating tobacco or e-cigarette use. Health care professionals, scientists, and policy makers must consider the influence of the tobacco industry on the data used to decide policy. Support of independent research and transparent policy and regulation development is essential, especially as the devices, vaping liquids and ingredients evolve.”
Sidena 50mg Tablets are now available over the counter in a 4 and 8 pack.

Product Name: Sidena 50 mg Tablets.
Composition: Each tablet contains, 50 mg sildena l (as citrate) .
Description: Light blue, round, slightly dotted tablets. Cross breaking notch on one side and marked ‘50’ on the other side. Can be divided into equal quarters. (Only two quarters of the 50 mg is covered by posology).
Indication(s): Treatment of men with erectile dysfunction, which is the inability to achieve or maintain a penile erection su cient for satisfactory sexual performance.
Dosage: Adults and elderly: 50 mg taken as needed approximately one hour before sexual activity. Dose may be decreased to 25 mg. Max dose: 50mg once daily. Impaired renal and hepatic function: Sildena l clearance is reduced in hepatic and severe renal impairment. Consider a dose of 25 mg. Dose may be increased step-wise to 50 mg if tolerated. Children and adolescents below 18 years of age: Contraindicated. Use in patients using other medicines: Starting dose of 25 mg with CYP3A4 inhibitors (not advised to use with ritonavir). To minimise postural hypotension in patients receiving and alpha-blocker, stabilise patient rst on the alpha blocker and use a starting dose of 25 mg sildena l.
Contraindications: Hypersensitivity to sildena l or any of the excipients. Concomitant with ritonavir, nitric oxide donors or nitrates in any form, guanylate cyclase stimulators e.g. riociguat. In patients that sexual activity is inadvisable (e.g. severe cardiovascular disorders such as a recent (6 months) acute myocardial infarction (AMI) or stroke, unstable angina or severe cardiac failure). Refer these patients to a doctor. Patients with loss of vision in one eye due to NAION. Known hereditary degenerative retinal disorders. Severe hepatic impairment. Hypotension. Anatomical deformation of the penis. Women. Not intended if no erectile dysfunction.
Warnings and Precautions for Use: First diagnose erectile dysfunction and determine potential underlying causes (e.g. hypertension, diabetes mellitus, hypercholesterolaemia or cardiovascular disease), before considering pharmacological treatment. Consider the cardiovascular status of patients, since there is a degree of cardiac risk associated with sexual activity. Serious cardiovascular events, including myocardial infarction, unstable angina, sudden cardiac death, ventricular arrhythmia, cerebrovascular haemorrhage, transient ischaemic attack, hypertension and hypotension have been reported post-marketing in temporal association with the use of sildena l. Most, but not all, of these patients had pre-existing cardiovascular risk factors. Sildena l has vasodilator properties, resulting in mild and transient decreases in blood pressure. Caution: Patients with anatomical deformation of the penis (such as angulation, cavernosal brosis or Peyronie’s disease), or in patients who have conditions which may predispose them to priapism (such as sickle cell anaemia, multiple myeloma or leukaemia). Advise patients that in case of priapism, prolonged erections (longer than 4 hours) or sudden visual defect, they should stop taking sildena l and consult a physician immediately. Administer to patients with bleeding disorders or active peptic ulceration only after careful bene t-risk assessment, as there is no safety information available. Interactions: Inhibitors of the cytochrome P450 (CYP) isoforms 3A4 (major route) and 2C9 (minor route) isoenzymes such as CYP3A4 inhibitors: Itraconazole, ketoconazole, erythromycin, cimetidine, HIV protease inhibitor saquinavir: May reduce sildena l clearance and increase sildena l plasma levels. Consider a starting dose of 25 mg. Strong CYP3A4 inducers e.g. rifampicin may increase sildena l clearance and decrease sildena l plasma concentrations. Grapefruit juice: May give rise to modest increases in plasma levels of sildena l. Nicorandil (Hybrid of potassium channel activator and nitrate): Due to the nitrate component it has the potential to have serious interaction with sildena l. Sildena l potentiates the hypotensive e ect of nitrates. Alpha blocker: Concomitant administration of sildena l may lead to symptomatic hypotension in a few susceptible individuals. Patients should be hemodynamically stable on alpha-blocker therapy prior to initiating sildena l treatment. Sildena l potentiates the antiaggregatory e ect of sodium nitroprusside in vitro. Not recommended in patients with a history of bleeding disorders or active peptic ulceration. Not recommended to use with other pulmonary arterial hypertension treatment containing sildena l.
Ability to Drive and Use Machinery: Minor in uence, dizziness and altered vision were reported. Patients should be aware of how they react to sildena l before driving or using machinery. Undesirable E ects: Very common: Headache. Common: Dizziness, visual disorders, visual colour distortion, vision blurred, ushing, hot ush, nasal congestion, nausea, dyspepsia. See SPC for more adverse e ects.
Marketing Authorisation Holder: Rowex Ltd, Bantry, Co. Cork. Marketing Authorisation Number: PA 0711/170/002. Further information and SPC are available from: Rowex Ltd., Bantry, Co. Cork. Freephone: 1800 304 400 Fax: 027 50417
E-mail: rowex@rowa-pharma.ie
Legal Category: Not subject to medical prescription.
Date of Preparation: Aug 2022
Adverse events should be reported. Reporting forms and information can be found on the HPRA website (www.hpra.ie) or by emailing Rowex pv@rowa-pharma.ie
We must change the way we talk about obesity to improve public understanding of the disease, according to a new study.
Researchers at University College Cork (UCC) and University of Galway are calling for ‘obesity’ to be renamed in order to help the public and policymakers to better understand the disease of obesity, and drive advances to treat and prevent it.
Published in Obesity Reviews, their study highlights ongoing confusion about the term ‘obesity’, which currently can refer to the disease of obesity or to a BMI range, or a combination of the two.
Dr Margaret Steele, a postdoctoral researcher in UCC’s School of Public Health, and Professor Francis Finucane, Consultant Endocrinologist and Professor of Medicine in the University
of Galway, explored different or conflicting understandings of the term ‘obesity’. The researchers suggest it is time to reconsider whether the term ‘obesity’ conveys the reality of this complex disease that centres on environmental, genetic, physiological, behavioural and developmental factors, not on body weight or on BMI. New appetite-control medications are generating phenomenal demand worldwide, but patients with obesity may be sent to the back of the queue on the mistaken assumption that they do not need the medication as much as patients with diabetes. The researchers suggest that clearer terminology could play a role in addressing this inequity.
Professor Francis Finucane described new Irish Medical Council guidance warning doctors against using Ozempic for obesity as morally problematic.
Professor Finucane said: “Semaglutide is approved as a treatment for obesity, just as it is for diabetes. There is a deeply stigmatising idea out there that people with obesity are looking for an easy way out, that these medicines provide a low-effort alternative to healthy diet and lifestyle. But for people living with the disease of obesity, these drugs don’t make behavioural change unnecessary, nor do they make it easy – they just make it possible.”

Active Iron, an Irish iron supplement brand based in Cork, proudly announces its achievement in being named as the ‹Best Irish Pharmacy Brand 2023› at the Irish Pharmacy News OTC & Retail Pharmacy Awards. In recognition of this remarkable achievement, Active Iron has launched a heartfelt thank you campaign, expressing gratitude to all who contributed to its success.
Reflecting on this milestone achievement, Pat O Flynn, CEO of Solvotrin Therapeutics, remarked, “I am so grateful for the support of Irish Pharmacists since Active Iron was brought to market. It takes a team effort to build a brand that resonates with customers, and I am incredibly proud of our team for their dedication and hard work. This award is a testament to our commitment to cutting edge science and a passion for addressing women’s health. We will continue to push ourselves to be the best and provide our customers with the highest quality products and services.”
Having launched just five years ago, Active Iron has rapidly ascended to become a prominent OTC brand in Irish pharmacies. This prestigious acknowledgment as a leading brand in Ireland serves as a testament to the commitment and remarkable contributions of the Active Iron team and their esteemed in market partner, Pharmed Ireland.

The Active Iron team would like to extend its deepest appreciation to IPN (Irish Pharmacy News) and the judging panel for acknowledging the brands commitment to providing high quality products for those who suffer with iron deficiency and struggle to tolerate high dose oral iron. Additionally, we would like to express our sincere gratitude to all the pharmacists, pharmacy teams, and consumers nationwide who have wholeheartedly supported us in our mission to empower women through advanced nutritional solutions.
To express gratitude to our valued partners and customers, Active Iron will be hand delivering chocolates to over 500 pharmacies and key accounts. Furthermore, Active Iron will collaborate with pharmacies nationwide to
create in-store displays, enhancing visibility, awareness, and conversion through point-ofsale materials highlighting the brand’s benefits and award throughout the rest of the year. All Active Iron product packs will also bear the distinguished award logo, emphasising the brand’s commitment to excellence.
To add excitement to the campaign, participating pharmacies and key accounts will have an opportunity to win a ¤1,000 voucher for their teams, fostering a sense of appreciation and celebration throughout the pharmacy community.
Active Iron remains committed to empowering women with innovative nutritional solutions and will continue its pursuit of excellence and groundbreaking scientific advancements.

The theme for World Brain Day this year was Brain Health and Disability, with the message of “Leave No One Behind.”
Stroke is sometimes known as a brain attack, and is the biggest cause of acquired disability in Ireland. Stroke occurs when a blood vessel, carrying oxygen and nutrients to the brain, bursts or is blocked by a clot. This causes an interruption of the blood supply to part of the brain, which can damage or destroy brain cells.
Heart disease can also cause damage to the brain, if there is a lack of oxygen to the brain. After surviving a cardiac event, there is a risk of brain injury and neurological dysfunction.
According to the World Federation of Neurology, “Brain disabilities can be prevented, treated, and rehabilitated.”
Recovery and rehabilitation after a stroke or cardiac event varies from person to person, and is a gradual process as the brain takes time to heal. While there is no roadmap for recovery or navigating living with an acquired disability, there are supports to help.
For World Brain Day, the Irish Heart Foundation is reminding stroke survivors of the supports available to them.
The Irish Heart Foundation Nurse Support Line is open 5 days a week; from 9am to 1pm Tuesday to Friday, and 9am to 5pm on Mondays. A nurse will be on hand to respond to any questions or concerns you may have about managing a heart condition, or recovering from a stroke or heart disease.
Supports for stroke survivors include:
• Life after Stroke Facebook support group
• Stroke Connect Service
• Young Stroke Survivor Network; including online groups, fitness classes, a peer support WhatsApp group, the Let’s Talk peer support phone service, courses and training.

Findings by the Health Research Board show cocaine has overtaken opioids to become the most common problem drug.
12,009
Commenting on the key findings in the report, HRB Chief Executive, Dr Mairéad O’Driscoll, said: “Our latest data provides insights into the patterns observed in drug treatment. Like last year, we are seeing an increase in cocaine as a problem drug. This year, it has surpassed opioids. The data we have collated will support practices in relation to treatment as well as underpinning action on preventative measures.”
A Health Research Board (HRB) report into drug treatment demand has found that 12,009 cases* were treated for problem drug use in 2022. Almost four in ten of those cases were never treated before.
This report describes trends in treated problem drug use (excluding alcohol) for the seven-year period from 2016 to 2022. The data is drawn from the National Drug Treatment Reporting System (NDTRS), the national surveillance system that records and reports on cases of drug and alcohol treatment in Ireland.
The Health Research Board (HRB) is Ireland’s lead funding agency supporting innovative health research and delivering data and evidence that improves people’s health and patient care. We are committed to putting people first, and ensuring data and evidence are used in policy and practice to overcome health challenges, advance health systems, and benefit society and economy.
Cocaine was the most common drug reported, accounting for one in three cases. This was followed by opioids (mainly heroin). Cannabis was the third most common drug reported, followed by benzodiazepines.
Dr Anne Marie Carew, Research Officer at the HRB, said: “There has been a considerable rise in the number seeking treatment for cocaine use in recent years. This is the result of the rise in use of cocaine as well as an increase in the provision of specific services to treat cocaine use.”

Different drugs generated varied treatment demand across age groups:
• Cannabis - 19 years of age or younger
• Cocaine - 20-34 year olds
• Opioids - over 35 year olds.
Polydrug use (problem use of more than one drug)
• Polydrug use was common and was reported by over half of cases (57%)
• Cannabis (40%) was the most common additional drug, followed by alcohol (36%), cocaine (36%) and benzodiazepines (32%).
*It is important to note that each record in the National Drug Treatment Reporting System (NDTRS) database, where this data is drawn from, relates to a treatment episode (a case), and not to a person. This means that the same person could be counted more than once in the same calendar year if they had more than one treatment episode in that year.
Bayer Ireland has announced that Vitrakvi® (larotrectinib), a first-inclass oral TRK inhibitor, has been granted reimbursement in Ireland. It is indicated for the treatment of adult and paediatric patients with solid tumours that display a Neurotrophic Tyrosine Receptor Kinase (NTRK) gene fusion, who have a disease that is locally advanced, metastatic or where surgical resection is likely to result in severe morbidity, and who have no satisfactory treatment options.
Larontrectinib is the first treatment in the EU to receive a tumouragnostic indication. The drug has demonstrated high response rates and durable responses in adults and children with TRK fusion cancer, including central nervous system (CNS) tumours. It is already approved in the U.S., Canada, Brazil, Japan, the UK, countries of the European Union (EU) and China, under the brand name Vitrakvi®. The product is approved across all solid tumours in adults and children of all ages who have cancer with an NTRK gene fusion.
The marketing authorization in the European Union, granted by the European Commission was based on clinical data of across the Phase I trial of adult patients, the Phase II NAVIGATE trial in adult and adolescent patients and the Phase I/II pediatric SCOUT trial. In an expanded dataset, 244 evaluable adult and pediatric patients out of 260 total patients with TRK fusion cancer across 25 different tumour types were analysed with longer follow-up (cut-off July 20, 2021).
Results showed larotrectinib continued to demonstrate powerful efficacy and a favorable safety profile. Investigators observed an objective response rate (ORR) of 69% (95% confidence interval [CI] 63–75), including 26% (n=64) complete responses (CR). The median time to response among all evaluable patients was 1.8 months (range: 0.9-16.2 months) and the median duration of response (DoR) was 32.9 months (95% CI 27.3–41.7) with median follow-up of 28.3 months. Median overall survival (OS) was not reached at a median follow-up of 32.2 months; the 48-month OS rate was 64% (95% CI 55–73). The median progressionfree survival (PFS) was 29.4 months (95% CI 19.3-34.3) at a median follow-up of 29.3 months.
“We welcome the approval of
Vitrakvi® (larontrectinib) for patients in Ireland. With larontrectinib, we have seen rapid, robust and durable responses with a consistent and manageable safety profile in patients with TRK fusion cancer, regardless of the age of the patient or where in the body the tumor is located. Cancer care is currently undergoing a paradigm shift and as this new era of precision oncology treatment unfolds, we are continuing to focus on delivering innovative medicines such as larotrectinib, which can provide value to patients and their treating clinican”. said Dr Tristan Cooper, Medical Director at Bayer Ireland.
AYA, the leading Irish vitamin and supplement brand for all the family is delighted to announce the launch of AYA Electrolyte Plus.

AYA Electrolytes Plus provides a rapid hydration formula enriched with 13 vitamins and minerals. Designed to give you an energy boost and help in the reduction in tiredness and fatigue.
AYA Electrolytes PLUS contains essential minerals including magnesium which contributes towards electrolyte balance and is essential for taking water into the cells effectively.
The formulation includes vitamins B and C which aid towards normal energy yielding metabolism and a reduction in tiredness & fatigue to promote general well-being.
The Effervescent tablets dissolve instantly in water and the nutrients
are absorbed quickly in the body. Available in two delicious flavours, Lemon, and Lime & Blackcurrant.
If you want to Live the AYA way and give your body, fast hydration, an energy boost, and immunity support, AYA Electrolytes Plus is for you.
AYA Brand Partner and Irish International Footballer Amber Barrett says ‘’I take my diet and lifestyle seriously. I have partnered up with multivitamin brand AYA, which is now a mainstay of my daily routine. It’s a good fit for me to help stay healthy, not get run-down or get colds. AYA has recently launched a new Electrolyte Plus product which I will ensure I take plenty of ahead of the World Cup. AYA Electrolytes Plus provides rapid hydration, gives an energy boost, and contains vitamins and minerals! It’s my go to, to ensure I am feeling good and game ready.
AYA Brand Partner and Irish International rugby player Robbie Henshaw says, ‘’Aya Electrolytes helps me through my busy schedule. It is a potent powerhouse formula with 13 vitamins and minerals. It helps my immunity and general well-being. I also find taking AYA Electrolytes really helps to support the reduction in tiredness and fatigue’’.
AYA is committed to delivering only the highest quality food supplements and vitamins to support health and well-being for all the family. The range of 39 products caters for adults, children, and babies. Exclusive
to Irish pharmacy AYA is widely available across the country including Allcare Pharmacy, Life Pharmacy, Hickeys Pharmacy, McCauley Pharmacy, and other leading Groups and Independent Pharmacies, where staff are trained to give advice and guidance on appropriate products. AYA’s research-backed products are formulated by scientists to deliver noticeable health benefits to customers and are gluten-free and vegan-friendly or vegetarian.
The distinctive blue bottles of AYA’s adult range reflect the iconic apothecary of the old world, with contents that have been formulated based on the latest cutting-edge research. While many of AYA’s colourful kids and baby range are unique products that contribute to the overall development in healthy children, and others help to support certain requirements or conditions.
AYA Electrolyte Plus available in pharmacies for 8.95eur nationwide NOW.
If there’s one trend that never stops trending, it’s beautiful skin. And, while make-up fads come and go, glowing, dewy, low-maintenance skin works both as a base for make-up and on its own. But how do we get a daily glow as well as long-lasting hydration and repair? Meet Instant Glow Rosehip Oil. Trilogy’s latest innovation combines the long-term benefits of our beloved Certified Organic Rosehip Oil, with responsibly sourced mica for a golden glow and instant illumination. Its silky to the touch and when you use it daily, it nourishes and repairs skin while making you think twice about opting for make-up.
This liquid gold power packed glass dropper bottle contains:
• Rich in omegas and a Trilogy icon, our Rosehip oil is cold pressed to guarantee a minimum 80% omegas 3,6, and 9 to hydrate and restore skin.
• Nature-identical and sustainably sourced mica pigments in shades of copper, sunflower gold, and iridescent pearl give its warm and sheer hue.
• Exclusive-to-Trilogy VanilleActiv2 is a new anti-ageing lipid that supports collagen production. Extracted from would-bewasted vanilla beans, it’s our newest ingredient innovation.
• Derived from olives, Squalane is an oil-like emollient.
• Help replenish skin’s natural moisture with Macadamia Oil and Avocado Oil.
How to Use: After cleansing and toning (and applying any serums), take one to two pumps of Instant Glow and massage into your face, neck and decolletage for a sun-kissed glow. This silky formula makes for a smooth base before applying make-up, or even mixed with your foundation for coverage with an extra glow.
Trilogy Instant Glow Rosehip Oil

RRP ¤40.95 (30ml)
Where to Find Us: Trilogy products are available from selected health stores and pharmacies nationwide including Nourish, The Health Store, The Hopsack, LloydsPharmacy, McCauley Health and Beauty Pharmacy, Meaghers Pharmacy or online at www. cloud10beauty.com.
For further information, images or interviews please contact: Aoife Horgan |aoife@versify.ie | 0879911893
NEW PHASE 2 DATA DEMONSTRATE POTENTIAL BENEFIT OF NIPOCALIMAB FOR PREGNANT INDIVIDUALS AT HIGH RISK OF EARLYONSET SEVERE HAEMOLYTIC DISEASE OF THE FOETUS AND NEWBORN (HDFN)
The Janssen Pharmaceutical Companies of Johnson & Johnson have announced positive results from the proof-of-concept Phase 2 open-label UNITY clinical trial for the treatment of pregnant individuals at high risk of early-onset severe (EOS) haemolytic disease of the foetus and newborn (HDFN).
A statistically significant (54 percent [n=7/13]) proportion of participants who received nipocalimab achieved the primary endpoint of a live birth at or after gestational age of 32 weeks without intrauterine transfusions
(IUTs) compared to the historic reference point of 10 percent, which was derived from published and unpublished data.
Among the seven participants who achieved the primary endpoint, the median gestational age at delivery was 37 and 1/7 weeks. This study demonstrates the potential for nipocalimab to help address the underlying disease mechanism of EOS HDFN. If approved, nipocalimab would be the first anti-neonatal Fc receptor (FcRn) treatment and the first approved non-surgical intervention for pregnancies at high risk of HDFN in the European Union. These data will be presented for the first time at the Fetal Medicine Foundation World Congress in Valencia, Spain on 26 June, 2023.
Nipocalimab is currently the only therapy reported in clinical development for the treatment of alloimmunisedc pregnant individuals at high risk of severe HDFN, a serious and rare condition which occurs when the blood types of a pregnant individual and the foetus are incompatible, potentially causing life-threatening anaemia in the foetus or infant.
“Pregnancies affected by HDFN currently experience a high treatment burden, such as repeated, invasive IUTs that require access to specialty care and put the life of the foetus at risk,” said Kenneth J. Moise Jr., M.D., Professor, Department of Women’s Health and Director, Comprehensive Fetal Care Center, at Dell Medical School of the University of Texas at Austin and lead study investigator. “I find these data encouraging, as they suggest the possibility of providing families with an effective, non-surgical HDFN treatment option if approved.”
In the UNITY clinical trial, 12 of 13 participants experienced a live birth.1 Additional results show:
• In pregnancies that met the primary endpoint of a live birth at gestational age of or after 32 weeks without IUTs (54 percent; n=7/13), one infant required a simple (blood) transfusion. In pregnancies requiring an IUT (n=6/13), all live-born infants (n=5/5) required a simple transfusion. Among the 12 liveborn infants, one infant required an exchange (blood) transfusion.
• The median gestational age at the first IUT was 28 and 3/7 weeks (range: 24 1/7 – 31 5/7 weeks) for those with live births.
• There were no reports of foetal hydrops.
Nipocalimab was generally well tolerated across all the dose groups studied in pregnant individuals at high risk for EOS HDFN:
• One pregnancy resulted in foetal demise due to complications following an IUT performed at gestational age 22 and 5/7 weeks. These complications were considered unrelated to nipocalimab. There were no maternal or infant deaths.
• The most frequently reported adverse events (AEs) were events that are not uncommonly reported in pregnancy or underlying HDFN.
• In the majority of participants, serious adverse events (SAEs [n=4]) were primarily related to HDFN or to various pregnancyassociated conditions and occurred with no discernible pattern or relationship to treatment with nipocalimab. Two participants who experienced live births demonstrated SAEs possibly related to nipocalimab. One participant experienced a subchorionic haematoma,h foetal growth restriction and foetal heart rate deceleration. The other participant experienced premature separation of the placenta.
• Neonatal and infant serum immunoglobulin G (IgG) approximated normal physiological nadirs at 24 weeks of age. Overall, in neonates/infants with maternal nipocalimab exposure, there were no unusual/unexpected childhood illnesses and infections reported in neonates/ infants are generally those that are commonly seen during the neonatal period through infancy.
Nipocalimab was shown to demonstrate an acceptable benefit-risk profile given the favourable efficacy results in the study, the significant unmet medical need with a potential for foetal/neonatal morbidity or mortality, and was overall well tolerated, supporting further clinical development for the treatment of HDFN.
“Despite advances in prenatal and neonatal care, people affected by an HDFN- pregnancy still experience a high treatment burden and babies may still require medical intervention after birth,” said Ludovic de Beaucoudrey, Ph.D., Senior Director, Therapeutic Area Lead, Immunology, Janssen-Cilag Limited. “We are motivated by this urgency to deliver a new treatment option and remain committed to
building on the orphan designation granted to nipocalimab by the European Medicines Agency, further exploring the potential of this medicine as we strive to make meaningful progress in addressing HDFN.”
JANSSEN MARKS FIRST APPROVAL WORLDWIDE FOR AKEEGA® (NIRAPARIB AND ABIRATERONE ACETATE DUAL ACTION TABLET) WITH EC AUTHORISATION FOR THE TREATMENT OF PATIENTS WITH METASTATIC CASTRATION RESISTANT PROSTATE CANCER WITH BRCA1/2 MUTATIONS
The Janssen Pharmaceutical Companies of Johnson & Johnson have announced that the European Commission (EC) has granted marketing authorisation for AKEEGA® (niraparib and abiraterone acetate [AA]), in the form of a dual action tablet (DAT), given with prednisone or prednisolone, for the treatment of adults with metastatic castrationresistant prostate cancer (mCRPC) and BRCA1/2 mutations (germline and/or somatic) in whom chemotherapy is not clinically indicated.
Prostate cancer is one of the most common cancers in men in Ireland with about 3,940 men diagnosed each year. Despite treatment advances, mCRPC remains an incurable, deadly disease. BRCA1/2 gene mutations have been identified in approximately 10-15 percent of mCRPC patients and are more likely to cause aggressive disease, poor outcomes, and a shorter survival time.
Professor Ray McDermott, Clinical Professor of Medical Oncology at Tallaght University Hospital said, “Metastatic castrationresistant prostate cancer remains a lethal disease, with high unmet needs in terms of treatment options, particularly for patients with BRCA1/2 gene mutations. The development of innovative therapies is vital to provide patients with new treatment options. The dual action tablet of niraparib with abiraterone acetate is a promising first line targeted treatment option for men with mCRPC and BRCA1/2 mutations. With BRCA testing now publicly available in Ireland, I hope this medicine will reach the right patients at the right time when available here.”
The EC authorisation, which also marks the first worldwide approval for AKEEGA®, is based on results of the randomised, double-blind, placebo controlled,
Phase 3 MAGNITUDE study (NCT03748641). The trial assessed whether the addition of niraparib to AAP improved outcomes in those with untreated mCRPC, with or without alterations in homologous recombination repair (HRR) associated genes (which are involved in the repair of damaged DNA), including BRCA1/2. A total of 423 patients with HRR gene alterations were enrolled, 225 (53.2 percent) of whom had BRCA mutations, making it the largest cohort of BRCA1/2-positive patients with first line mCRPC in any clinical study to date.
Dr Thorsten Giesecke, General Manager, Commercial Business, Janssen Sciences Ireland UC, said: “Janssen’s legacy in innovation and the development of treatments for prostate cancer spans more than a decade. We remain committed to harnessing the power of science to bring solutions to patients at every stage of their cancer journey. The MAGNITUDE trial was prospectively designed as a precision medicine study to identify the specific population of patients who would most benefit from niraparib with AAP, and potentially increase the likelihood of treatment success. This approval marks an exciting step in the right direction, changing the outlook for patients with mCRPC for the better.”
The primary endpoint for MAGNITUDE was radiographic progression-free survival (rPFS), as analysed by blinded central review. Niraparib plus AAP significantly improved rPFS in all HRR-positive patients (Hazard Ratio [HR] 0.73; 95 percent Confidence Interval [CI], 0.56 to 0.96; p=0.022). This improvement was most pronounced in patients with BRCA1/2 gene mutations, where a statistically significant 47 percent risk reduction was observed for rPFS. With additional median follow-up at 24.8 months in the BRCA subgroup, rPFS by central review demonstrated a consistent and clinically meaningful treatment effect favouring niraparib plus AAP, with a median rPFS of 19.5 months compared with 10.9 months for placebo plus AAP. Additionally, there was a trend towards improved overall survival (OS) with niraparib plus AAP, strong improvement in time to symptomatic progression (TSP) and clinically meaningful improvement in time-to-initiation of cytotoxic chemotherapy (TCC).
The observed safety profile of the combination of niraparib and AAP was consistent with the known
safety profile of each agent. Of the patients with HRR gene alterations, 67 percent experienced Grade 3/4 adverse events (AEs) in the combination arm versus 46.4 percent in the control arm. The most common grade 3 AEs were anaemia (28.3 percent versus 7.6 percent) and hypertension (14.6 percent versus 12.3 percent) with niraparib and AAP versus placebo and AAP, respectively. The combination of niraparib and AAP also maintained overall quality of life in comparison with placebo and AAP.
Niraparib is a highly selective poly adenosine diphosphate-ribose polymerase (PARP) inhibitor. Together with AA plus prednisone, the combination DAT regimen targets two oncogenic drivers in patients with mCRPC, namely alterations in the androgen receptor axis and in BRCA1/2. This is the first DAT formulation available in the European Union for patients with mCRPC with BRCA mutations.
POSITIVE TOPLINE PHASE 2B DATA IN ATOPIC DERMATITIS SUPPORT AMLITELIMAB AS A POTENTIAL FIRST AND BEST-IN-CLASS NOVEL INVESTIGATIONAL ANTIOX40-LIGAND MONOCLONAL ANTIBODY
The primary endpoint was met in a Phase 2b study (STREAMAD) of amlitelimab in adults with moderate-to-severe atopic dermatitis whose disease cannot be adequately controlled with topical medications or for whom topical medications are not a recommended treatment approach.
In this dose-ranging study, treatment with amlitelimab resulted in statistically significant improvements in average Eczema Area and Severity Index (EASI) score from baseline at 16 weeks compared to placebo for all four subcutaneous doses that were studied. There were also improvements in key secondary outcome measures and continued improvements were observed through week 24 in primary and key secondary outcomes. Biomarker results support an effect on both type 2 and non-type 2 pathways.
Amlitelimab was well-tolerated in the study across all dose arms and no new safety concerns were identified.
Naimish Patel, M.D. Head of Global Development, Immunology and Inflammation, Sanofi said, “While we have made significant
strides in the treatment of atopic dermatitis, there are patients who are still in need of new options. We believe that the results from this Phase 2b study with amlitelimab support our perspective that targeting OX40-Ligand has the potential to provide a first and best-in-class treatment option that addresses type 2 and non-type 2 inflammation to meet the individual needs of people living with atopic dermatitis and other chronic inflammatory diseases. We look forward to advancing into a larger Phase 3 clinical development program and continuing to drive momentum in our Immunology pipeline to deliver first or best-inclass treatments.”
Amlitelimab is a fully human nondepleting monoclonal antibody that binds to OX40-Ligand, a key immune regulator, and has the potential to be a first-inclass treatment for a range of immune-mediated diseases and inflammatory disorders, including moderate-to-severe atopic dermatitis and asthma. By targeting OX40-Ligand, amlitelimab aims to restore immune homeostasis between pro-inflammatory and regulatory T cells.
Detailed efficacy and safety results from this trial will be presented in a future scientific forum. Amlitelimab is currently under clinical investigation, and its safety and efficacy have not been evaluated by any regulatory authority.
The U.S. Food and Drug Administration (FDA) has approved Sanofi and AstraZeneca’s Beyfortus™ (nirsevimab-alip) for the prevention of respiratory syncytial virus (RSV) lower respiratory tract disease (LRTD) in newborns and infants born during or entering their first RSV season, and for children up to 24 months of age who remain vulnerable to severe RSV disease through their second RSV season. The companies plan to make Beyfortus available in the U.S. ahead of the upcoming 2023-2024 RSV season. RSV is the leading cause of hospitalization for infants under the age of one in the U.S., averaging 16 times higher than the annual rate for influenza.1,2 Each year, an estimated 590,000 RSV disease cases in infants under one require medical care, including physician office, urgent care, emergency room visits and hospitalizations.3
Thomas Triomphe, Executive Vice President, Vaccines, Sanofi said, “Today’s approval marks an unprecedented moment for protecting infant health in the U.S., following an RSV season that took a record toll on infants, their families, and the U.S. healthcare system. Beyfortus is the only monoclonal antibody approved for passive immunization to provide safe and effective protection for all infants during their first RSV season. I am proud that, by prioritizing this potential gamechanger, we are now about to bring Beyfortus to American families.”
The FDA decision follows the positive recommendation of the FDA Antimicrobial Drugs Advisory Committee and was based on the extensive Beyfortus clinical development program spanning three pivotal late-stage clinical trials. Across all clinical endpoints, a single dose of Beyfortus demonstrated high and consistent efficacy against RSV LRTD extending through five months, a typical RSV season.
Beyfortus was well tolerated with a favorable safety profile that was consistent across all clinical trials. The overall rates of adverse events were comparable between Beyfortus and placebo and the majority of adverse events were mild or moderate in severity. The most common adverse events were rash and injection site reactions. The single administration of Beyfortus was developed to correspond with the beginning of the RSV season for babies born prior to the season or at birth for those born during the RSV season. In clinical trials, Beyfortus helped prevent RSV LRTD requiring medical care in all infant populations studied, including those born healthy at term, late preterm or preterm, or with specific health conditions that make them vulnerable to severe RSV disease.
UCD-LED PAN EUROPEAN BIOMEDICAL IMAGING RESEARCH PROJECT SECURES
¤2.5 MILLION IN FUNDING
A new University College
Dublin (UCD) led pan-European research project using correlative multimodal imaging (CMI) to improve the understanding of biomedical processes of disease and drug therapy has secured ¤.5 million in funding.
CLEXM (Correlative Light, Electron and X-ray Microscopy), a 4-year project involving 7 partner organisations in 4 countries, has been funded by Horizon Europe
under the Marie SkłodowskaCurie Actions Doctoral Network (MSCA-DN) programme. The project which officially commences this September will fund nine (9) PhD candidate projects across the partner organisations.
SiriusXT, a UCD spin-out company based in Dublin, which has developed the first commercial, laboratory-based, soft x-ray microscope, is among the partner organisations.
CMI is used by researchers to obtain a composite view of a biological sample with the multidimensional information about its structure, dynamics, function and chemical composition required to understand biomedical processes and diseases.
There is a growing need for disease and drug therapy researchers to better understand the linkages between structural and functional changes that occur in a cell and to be able to observe these from the cellular (micrometre) to the molecular (nanometre) scale.
Correlative Light and Electron Microscopy (CLEM) is the current state-of-the-art for achieving this, but the technique is extremely complex and slow.
The overall focus of the 9 CLEXM research projects is to demonstrate that the integration of a third imaging technique, Soft X-ray Tomography (SXT), into CLEM will make it easier and faster for researchers to correlate cellular structure with cellular function.
This will lead to a more complete view of the processes of disease and drug therapy by creating a composite view of a biological sample with multidimensional information about its macro-, meso- and microscopic structure, dynamics, function and chemical composition to develop more effective drug therapies.
Three of the nine research projects will take place in UCD, two of these projects will be supervised by Professor Jeremy Simpson, College Principal, UCD College of Science and Professor Oliver Blacque, UCD School of Biomolecular and Biomedical Science and the third project will be supervised by Dr Sergey Kapishnikov, SiriusXT.
Professor Jeremy Simpson, said, “UCD is very pleased to be the Project Coordinator of project CLEXM. It provides an excellent opportunity to collaborate and build relationships with leading European research organisations as well as funding three PhD
projects in UCD and building expertise in correlative multimodal cell imaging.”
Tony McEnroe, CEO, SiriusXT, said, “As an SME, developing a highly innovative cell imaging microscope for the disease research and drug discovery markets, project CLEXM provides us with access to leading research talent, funding to achieve our development goals and an opportunity to collaborate with leading research organisations, many of whom are target customers for our microscope.”
Professor Simpson added, “The overarching objective of CLEMX project is to provide high-level training in the field of correlative multimode imaging to a new generation of doctoral candidates to provide them with the transferrable skills necessary for thriving careers in a high-growth area that will aid researchers in their quest to understand disease and to develop effective therapies.”
The other project partners in addition to UCD and SiriusXT are; Institut Pasteur (France), Aalen University (Germany), Ruprecht-Karls University Heidelberg (Germany), Synchrotron Soleil (France) and ALBA Synchrotron (Spain).
BIOPHARMACEUTICAL COMPANY ABBVIE LAUNCHES NEW SCHOOLS’ PRIZE TO HELP SPARK AN INTEREST IN STEM
Deirdre Clune MEP recently joined employees of the biopharmaceutical company
AbbVie to launch a science, technology, engineering & mathematics (STEM)-focused schools’ prize.
The AbbVie STEM Prize encourages engagement in STEMrelated learning. The company said it wished to showcase the exciting and diverse educational and career opportunities that can be unlocked for young people who develop an interest in these subjects.

The project will roll out to national schools in Dublin, Cork, Sligo and Mayo in September, to coincide with the start of the new school year.
Participating schools will have an opportunity to win STEM-related materials to the value of ¤30,000. Schools that enter will be asked to demonstrate how they might use STEM to solve challenges in their communities.
In partnership with other interested groups, AbbVie previously published the STEM Paths report exploring barriers to engagement in science-related subjects and careers in Ireland. The document highlighted the negative impact that low levels of STEM student interest might have on Ireland’s high-value pharma, biopharma and medical device sectors.
The company also runs a Back to School for STEM initiative. It supports employees from six of AbbVie’s sites around the country to visit local schools, including their alma maters, to talk about their jobs and the difference working in pharma makes to wider society
Speaking at the launch, former civil engineer Deirdre Clune MEP said she was passionate about STEM and delighted to support the initiative.
“It is great to see AbbVie engaging with young people in their schools to highlight the wide variety of career options open to students who may study STEM. The traditional role of Scientist or Engineer has evolved and there are many variations required in today’s workplace. Companies such as AbbVie require a large pool of talent across a range of areas to conceive, develop and deliver their products in a safe and sustainable manner. This initiative will make students and their teachers aware of those opportunities.”
AbbVie General Manager, Andrés Rodrigo Díaz, explained that a research-driven company like AbbVie had to be proactive in its support of STEM in local communities and showcase the diverse opportunities that are available in the pharmaceutical industry.
“Ireland has a highly developed employee talent base, but the global market is very competitive. As an innovation-based company, we need to continuously engage with parents, teachers, schools, and others to highlight the broad range of high-quality opportunities that come from studying STEM disciplines. It’s our job to inspire the next generation of STEM workers and enthusiasts.”
Cancer Trials Ireland, the national organisation dedicated to advancing cancer clinical trials, has announced the creation of the Pat Smullen Chair in Pancreatic Cancer at University College Dublin (UCD). The new position will anchor expertise in pancreatic research in Ireland with the ambition of creating a global centre of excellence for treatment and research of this form of cancer which has one of the poorest outcomes.
“The position will receive ¤900,000 (¤180,000 per annum) in funding over five years from Cancer Trials Ireland’s Pat Smullen Pancreatic Cancer Fund with matching funding for the role from the HSE National Cancer Control Programme (NCCP),” says Eibhlín Mulroe, CEO of Cancer Trials Ireland. “UCD will then take over Cancer Trials Ireland funding contribution to continue the partnership with the HSE NCCP.”
The new Chair will share their time between their clinical work as a treating physician at St Vincent’s University Hospital – the national surgical centre for pancreatic cancer – and their research work at UCD School of Medicine. At UCD, they will work to identify, attract, open and monitor new pancreatic cancer trials for patients
in Ireland. UCD School of Medicine is welcoming applications for the position from today.
Ms Mulroe continued, “The Pat Smullen Pancreatic Cancer Fund arises from various fundraising endeavours undertaken by champion jockey, Pat Smullen, his family, and the horse racing community, following his diagnosis with pancreatic cancer in March 2018. The inaugural fundraising event – the Irish Champions Weekend – raised ¤2.6m in September 2019, with further fundraising events having raised an additional ¤367,000 to date.
“Sadly, Pat died in September 2020, but his legacy lives on and the fund he created includes new treatment options for 174 patients with pancreatic cancer, at no cost to themselves, or to the State. The announcement of this Chair position will help to further develop the research infrastructure in place in hospitals, meaning we will be better able to support the development of pancreatic cancer clinical trials and be ready to take full advantage of important treatment advances when they come along.”
Global Leader
For Professor Ray McDermott, Clinical Lead for Cancer Trials Ireland – and Pat Smullen’s treating doctor – the new Chair in Pancreatic Cancer will see patients reaping the rewards, “This is a huge step forward towards making Ireland a global leader

in pancreatic cancer research and treatment. A position like this is intended to attract a world expert in the disease, who, in turn, will garner the attention of other leading clinicians wishing to work jointly and develop partnerships. Pharmaceutical companies developing treatments in this space will also want to get involved and I have no doubt that Irish patients will reap the rewards of this exciting development in the near future. I commend the vision of Cancer Trials Ireland, University College Dublin, the HSE National Cancer Control Programme and, most of all, Pat’s wife, Frances Crowley, in coming together to make all of this possible.”
According to the Irish Cancer Society, there are approximately 620 people diagnosed with pancreatic cancer each year in Ireland. Unfortunately, the disease is both challenging to treat and to study. Biopsies of pancreatic cancer can be difficult to get, due to the location of the pancreas, and even when large tumour samples are extracted, they often provide very few cancer cells to study, due to the diffuse spread of cells in surrounding tissue. In addition, as its incidence is lower than more common forms of cancer, such as breast, lung, and colorectal cancers, to date, pancreatic cancer hasn’t seen the same levels of attention that other cancers attract.
Research funded by the Pat Smullen Pancreatic Cancer Fund so far:
• A total of 15 patients have been recruited to a Paricalcitol trial around improving chemotherapy effectiveness in people with newly diagnosed pancreatic cancer.
• A total of 22 patients will be recruited to a trial for patients with advanced stage pancreatic cancer that have failed treatment. The first patient was recruited in late June.
• A new radiotherapy study has been developed to investigate if a novel radiation delivery technique can improve outcomes in 67 patients with operable/borderline-operable pancreatic cancer.
• A study, known as the FEED study, has been submitted for ethical approval that will recruit 70 patients for a nutritional intervention to strengthen patient resilience and recovery from pancreas tumour surgery.
• Funding of ¤100,000 provided for a Next Generation Sequencer (NGS) machine in St Vincent’s University Hospital (important in the treatment of pancreaticobiliary cancer). The hospital expects two new appointments in molecular pathology returning from Harvard Medical School this summer on the back of this initiative.
For more information on the work of Cancer Trials Ireland, visit www.cancertrials.ie, and on the Pat Smullen Pancreatic Cancer Fund, visit www.cancertrials.ie/ pat-smullen
A study involving RCSI researchers has found that a small proportion of babies born early in the COVID-19 pandemic had gaps in their communication skills at age two and could benefit from additional support.
Published in Archives of Disease in Childhood, the research builds on findings from a study last year on ‘pandemic babies’ at 12 months of age. The new study looks at communication and other developmental milestones in twoyear-olds who were born in the first months of the COVID-19 and lived through lockdown as babies, and compared them with results for two-year-olds who were born before the pandemic began.
Reassuringly, it found no differences between pandemicborn and pre-pandemic babies in most other aspects of development, and no differences in behavioural outcomes, at the age of two years. However, the new findings about communication point to the need for continued screening and the importance of resources being made available to support children who may need them in the future.
The CORAL (Impact of Corona Virus Pandemic on Allergic and Autoimmune Dysregulation in Infants Born During Lockdown) study looks at what life was like for babies born in the first three months of the COVID-19 pandemic. The project involves researchers from RCSI, Children’s Health Ireland (CHI) and University College Cork.
Study co-author Dr Susan Byrne, RCSI Department of Paediatrics and FutureNeuro SFI Centre, said: “Lockdown presented babies with a very different environment, where they were less likely to interact with people outside of the immediate family group. In the CORAL study, we had previously shown that pandemic-born babies in Ireland had slightly reduced social communication skills relative to their counterparts who had not experienced lockdown as babies. We can’t say exactly why that was but we did show that these babies had very small social circles. In the first year of life a quarter of the pandemic-born babies in the CORAL group did not meet another child of their own age. For this new study, we followed up with the same group of pandemicborn babies when they had just turned two.”
Parents in the CORAL study filled out standard questionnaires and checklists about their child’s development and milestones. The researchers then compared the CORAL results with answers recorded in a previous study, BASELINE, which tracked the development of babies born Ireland before COVID-19. Their findings showed that by the age of two, parents of both pandemic and pre-pandemic babies reported similar results in areas such as movement, personal and social interactions and solving problems. A small but measurable difference in answers about communication between the two groups remained, however, with a larger proportion of pandemic-born babies scoring below standardised cut-offs for developmental concern
in the communication domain (11.9%) when compared with babies who had been born before the pandemic (5.4%).
“We were able to demonstrate that most of their developmental and behavioural outcomes at this age were comparable to pre-pandemic born babies, except for mild differences in communication,” said Dr Byrne, who is a researcher with FutureNeuro and consultant paediatric neurologist in Children’s Health Ireland at Crumlin. “The majority of pandemic-born babies had entirely normal communication scores, but in the overall group there was a statistically relevant higher proportion at risk of developmental concerns compared to the pre-pandemic group.“
These findings are the first to report this mild communication deficit in pandemic-born babies in Ireland, according to study co-author Professor Johnathan Hourihane, who noted the need for continued monitoring and support, particularly as the children approach school-going age: “Our findings highlight the need to continue national developmental screening programmes for all children, and provide the appropriate resources for early intervention services.”
The CORAL Study is supported by the Temple Street Hospital Foundation in Dublin, Ireland and the Clemens von Pirquet Foundation in Geneva, Switzerland.
A unique breastfeeding clinic designed to support mothers who are having difficulty breastfeeding has won two Irish Healthcare Centre Awards. The ‘Well Baby Breastfeeding Clinic’ in Galway won Best Community Outpatient Initiative of the year and Clinical Team of the year at an awards ceremony in May.

The ‘Well Baby Breastfeeding Clinic’, the first of its kind in Ireland, is a collaboratation between the Maternity Department at University Hospital Galway (UHG) and the Department of Public Health Nursing, Community Healthcare West and was designed to support mothers who are having difficulty breastfeeding in the early weeks of their breastfeeding journey. The clinic was set up in response to an identified need to help mothers who were presenting with their babies to the emergency department with common feeding related problems as there was no alternative referral pathway for them.
Dr Ethel Ryan, Consultant Neonatologist and Paediatrician at University Hospital Galway and one of the initiators of the ‘Well Baby Breastfeeding Clinic’, explains; “Breastfeeding is a learned skill acquired through education, observation and experience. While it is the most natural way to feed babies,
breastfeeding issues in the early weeks tend to be time sensitive.
“At our Shantalla clinic here in Galway, we currently see infants born at University Hospital Galway and all clinic referrals come through either the postnatal ward at UHG or your local Public Health Nurse.
“The first ‘Well Baby Breastfeeding Clinic’ was held in December 2021 and saw 270 patients in the first year of service. This represented 10% of all infants born at University Hospital Galway in 2022. A second clinic per week was added in January 2023 as a result of increased demand for the service.”
“By identifying and addressing feeding issues as early as possible, it facilitates improved breastfeeding outcomes and therefore we aim to see all mothers and their infants in the same week of referral where possible,” added Dr Sinéad Gavin, General Practitioner, International Board Certified Lactation Consultant and Clinical Lead for the ‘Well Baby Breastfeeding Clinic’. The clinic identifies breastfeeding issues such as latching and positioning issues, low milk supply, tongue tie, poor or slow weight gain, excess wind, cracked nipples, mastitis and over supply of milk. Each mother and baby receives a 45-minute appointment which includes a comprehensive history assessment, a breastfeeding evaluation, infant oral assessment and a personalised treatment plan. Tongue tie release procedure is also performed, if required.
